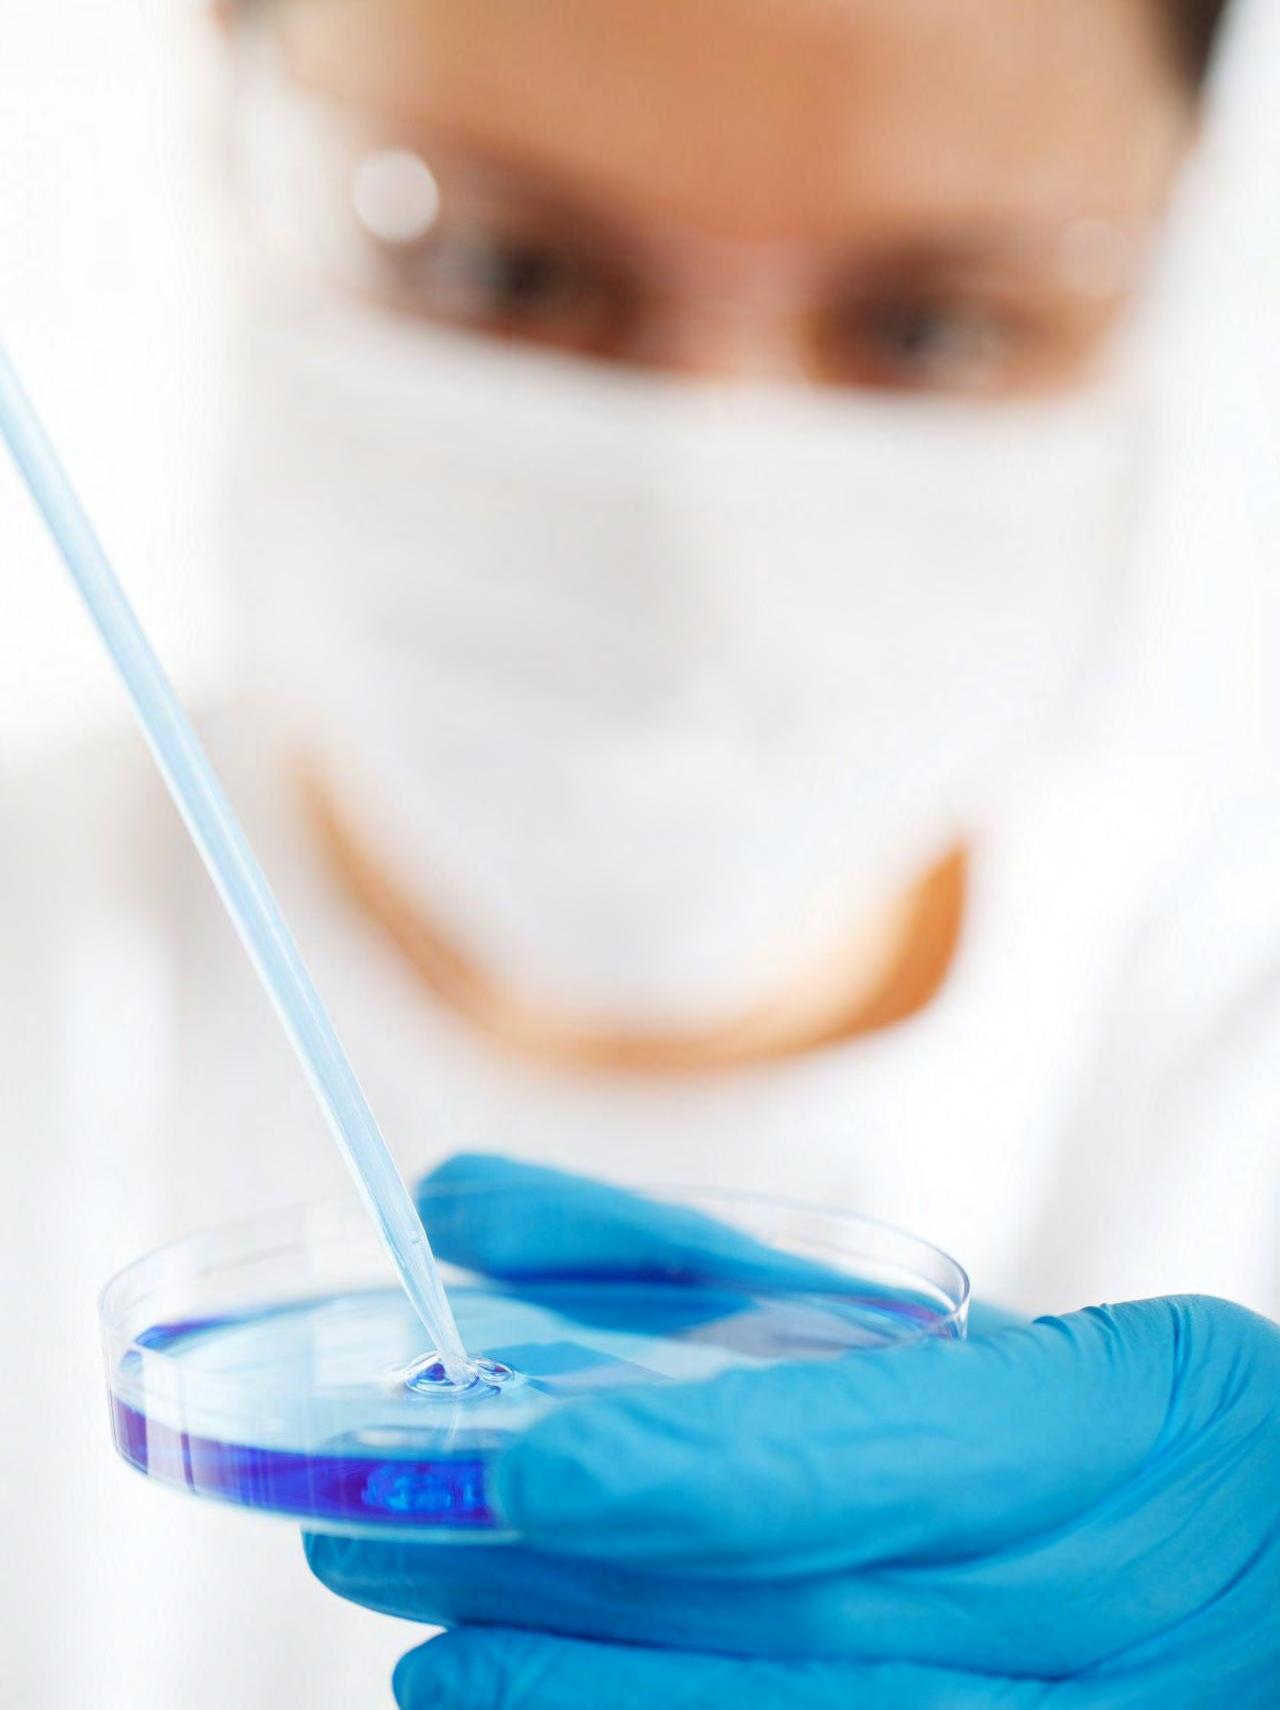

The Industry Yearbook & Buyers Guide 2023
Eurofins BPT Dungarvan, Ireland Laboratory
Eurofins BioPharma Product Testing Dungarvan is part of a network of laboratories with over 40 facilities throughout Europe, North America and Asia-Pacific delivering the world’s most comprehensive scope of harmonised GMP testing services and seamless regulatory acceptance.

www.eurofins.ie/biopharma-service


EurofinsBPT-IE@eurofins.ie
Our services range from Oligonucleotides, Biologics, Gene Therapy, Chemistry, Process Control, Molecular Cell Biology, Bioassay, Raw Materials and Microbiology. With continuous investment in these areas.

IN ASSOCIATION WITH BIOPHARMACHEM IRELAND
Elite Technical Support
150 engineers, operating on and off site, nativespeakers in 10+ languages, ITIL accredited
Ensure critical enterprise technologies are always available. Our highly skilled, multilingual teams of engineers in Ireland, US, UK and New Zealand deliver a collaborative global service model that drives productivity with excellent customer satisfaction ratings.

24/7/365 remote and onsite support for all your business needs. With offices based in several countries, we can provide technical assistance in all of the top 10 European and Asian languages.
Westbourne provides onsite technical support for all your lab applications ranging from LIMS to CDS. We also offer a remote service for those wanted to save on desk-space.


We support companies for short term projects, from lab based CDS to Windows 10 IT upgrades. We can provide onsite staff from 1-9 months to support you through your project.


Westbourne IT - Experts in Global Enterprise Service Desk including Manufacturing and Labs IRELAND | USA | New Zealand, www.westbourneit.com, James.Symington@westbourneit.com +353 (0)21 431-4310
Enterprise Service Desk Project Services Lab IT Services
CONTENTS
4 TAOISEACH’S FOREWORD
Ireland is in prime position to remain at the forefront of the development of the next generation of biopharmaceutical and medical products, including personalised medicines and Advanced Therapy Medicinal Products, writes An Taoiseach, Leo Varadkar TD.
6 SECTOR OVERVIEW
Matt Moran, Director, BioPharmaChem Ireland, explains how BioPharmaChem Ireland and its members worked intensively of the preparation of its latest industry strategy report for the sector, entitled ‘Make Ireland the Global Leader in Sustainable Biopharmaceutical and Chemical Manufacturing, which clearly outlines a way forward for this important sector.
11 BIOPHARMACHEM IRELAND STRATEGY

BioPharmaChem Ireland’s latest strategy identifies six strategic themes which will underpin the future success of the sector here and ensure Ireland remains at the forefront of sustainable biopharma and chemical manufacturing into the future.
17 NIBRT
Darrin Morrissey, CEO, NIBRT, highlights the post-pandemic trends in the global biopharma industry, the innovations driving the sector forward and the role of NIBRT in strengthening Ireland’s leadership position in global biopharma manufacturing and supply.

23 LABORATORY APPRENTICESHIP PROGRAMME
Siobhán Dean, BioPharmaChem Ireland, explains the overwhelming success of the Laboratory Apprenticeship Programme, which has recently expanded to Munster Technological University, Cork.
27
TRAINING & DEVELOPMENT
The BioPharmaChem Skillnet provides businesses with industry-specific and even company-specific training programmes, reveals Susan Costello, Network Manager, BioPharmaChem Skillnet.
30 ENTERPRISE IRELAND
Garrett Murray, Head of Life Sciences, Enterprise Ireland, reports on the strong performance of Irish life sciences companies supported by EI, and explains the pillars of Enterprise Ireland’s new strategy, Leading in a Changing World.
34 IDA
Rory Mullen, Head of Biopharma, IDA Ireland, stresses the continued importance of Foreign Direct Investment in the Irish pharma sector and highlights the areas to focus on to ensure that Ireland remains a key player in biopharma going forward.
39 MEDICINE SHORTAGES
Grainne Power, Director of Compliance, Health Products Regulatory Authority, explains how the HPRA has developed a framework to tackle medicine shortages nationally, in conjunction with other stakeholders.
42 SUPPLY CHAIN LOGISTICS
DHL have a deep knowledge of pharmaceutical market dynamics, standards and regulations, combined with many years of experience of developing specific solutions for the industry, including temperature assurance, special handling for vaccines and biologics, customisation, packaging and direct delivery to patients and customers.

46 SSPC
SSPC has proven itself to be a dynamic hub of research expertise, bringing together academia and industry to address key challenges facing the biopharma sector.
51 PMTC
An emphasis on collaborative engagement with its industrial partners ensures that PMTC is strategically positioned to address real-world challenges within the pharmaceutical manufacturing sector, writes Sarah Hayes, Centre Director, Pharmaceutical Manufacturing Technology Centre.
54 CUSTOM FORMULATION/MANUFACTURING SERVICES
Leading supplier of custom formulation and manufacturing services, Ortec officially opened its European Headquarters, Manufacturing and Operations Centre in Newcastle West, Co. Limerick.
55 ADVANCED THER APEUTICS
VLE Therapeutics went from concept to reality in just seven months, explains Paul McCabe, COO, who argues that Ireland needs to move fast if we want to be leaders in Advanced Therapeutics.
58 ELI LILLY
Eli Lilly is creating a new facility for biologic active ingredients in Limerick, which will support increased demand for existing products and play a key role in bringing new therapies to patients worldwide.

60 MERCK
Merck is expanding its membrane and filtration manufacturing capabilities in Ireland with an investment of €440 million in two sites in Cork.

62 COVER STORY – LABORATORY TESTING
Eurofins BioPharma Product Testing Ireland offers unique and unparalleled breadth of service and experience for Biologics, RNA based drugs and highly potent products.
64 SK BIOTEK
From standalone analytical services to Cell & Gene Therapy, SK pharmteco is growing from strength to strength. Here in Ireland, the Dublin-based pharma plant of SK biotek Ireland, an SK pharmteco company, celebrates five years operating as a CDMO this year.
68 ACTYLIS
Limerick-based A&C Bio Buffer has been fully integrated into and has become a key part of the newly formed Actylis, a leading global manufacturer and sourcing expert of critical raw materials and performance ingredients for the life sciences market.
Irish PharmaChem | Industry Buyers Guide 2023 1
Editorial and Marketing Director: Kathleen Belton Editor: John Walshe
6 42 34 30
70 PACKAGING
Tekpak Automation designs, develops and manufactures end-of-line packaging systems for pharmaceutical manufacturers, with a core expertise in high-speed robotic pick-and-place applications.

72 PHARMACEUTICAL INGREDIENTS
Univar Solutions is bringing innovation to the future of pharmaceutical ingredient distribution.

74 LIQUID ANALYSIS
Endress+Hauser are introducing the next generation of Memosens digital technology for simple, safe and connected liquid analysis.
76 WASTE MANAGEMENT
Discover how European waste management experts Indaver can contribute to a cost-effective, CO2-reducing and environmentally friendly waste management.
78 CHEMICAL SOLUTIONS
Chemifloc Group provides specialist chemical solutions and technical services for multiple industrial and municipal applications.
82 ERT COMMUNICATION
Advancing technology allows ERT critical communications equipment from Hubbcat to offer a range of elements into one digital device.
84 SPECIALTY CHEMICALS
Greenfield Global is a trusted partner for multi-compendial raw materials.
86 PHARMACEUTIC AL RAW INGREDIENTS
Paul Power, Strategic Sourcing & Supply Chain Executive, NCC, discusses the impact of the energy crisis and how it may affect the pharmaceutical industry.
88 HOVIONE
Hovione is a global company with over 60 years of experience as a Contract Development and Manufacturing Organisation.
CONTENTS
89 IT SERVICES
Westbourne IT Global Solutions Ltd work with their clients’ IT department as an outsourced extension of their team, delivering short, medium- and long-term projects in their laboratories.
91 CALIBRATION
Paperless calibration is here to stay, with Bonner leading the way.
92 INGREDIENTS
Ingredients distributor Barentz offers pharmaceutical manufacturers a range of ingredients to suit every application, including challenging formulations.

94 MODUL AR CLEANROOMS
Dawsongroup TCS Ireland have introduced a wide range of cleanroom solutions for customers, including modular cleanrooms to rent as well as buy.
96 GRIFOLS
Grifols’ new 17,000 square metre albumin plant in Grange Castle brings its total investment in its Irish operations to around €300 million since 2012.
98 CONTRAST MEDIA
GE Healthcare’s new $30 million pharmaceutical imaging agents facility in Cork secures the future supply of contrast media, as demand is projected to double.
99 E-LEARNING
Paula Álvarez, Information Developer, Technically Write IT, explains the company’s human-centred approach to eLearning.
100 ROBOTICS
Robot technology from KUKA can be employed right along the process chain, from API recipe testing and ingredient measuring to packaging product in clean room facilities.
Irish PharmaChem is published by: Tara Publishing Ltd
14 Upper Fitz william Street, Dublin 2. Tel: 00 353 (0)1 678 5165
Web: www.irishpharmachem.com
Managing Director: Patrick Aylward
Editorial and Marketing Director: Kathleen Belton
Email: kathleenbelton@tarapublications.ie
Editor: John Walshe
Advertising Sales: Brian Clark, Aaron Stewart
Design: Tony Hunt
Production: Ciara Conway
Printed by: W&G Baird
Irish PharmaChem | Industry Buyers Guide 2023 2
SECTION 103 Chemical Suppliers 104 General Suppliers 110 Company Listings 120 Useful References
LISTINGS
100 62
Janssen Never Stops
As the world finds its way forward, people never stop needing ways to conquer disease. Ways to live with immune-related disease. Ways back from cancer. That’s why we never stop working toward a future where disease is a thing of the past.

Learn more at www.janssen.com/ireland/

Consolidating Ireland’s Strengths in Life Sciences

Ireland is in prime position to remain at the forefront of the development of the next generation of biopharmaceutical and medical products, including personalised medicines and Advanced Therapy Medicinal Products, writes An Taoiseach, Leo Varadkar TD.

I’ll begin by congratulating you all on another great year for the pharmaceutical sector in Ireland.
Earlier this year, I took the opportunity to introduce the Special Edition of the Irish PharmaChem Yearbook to focus on and celebrate the importance of innovation and research to our continued health. Ireland has a strong track record of excellence in design, development and manufacture of biopharmaceutical products, and we are well placed to deal with the complex data, quality, regulatory and supply chain issues associated with the growing trend towards personalised medicines and increasing regulatory requirements.
NIBRT Cell & Gene Therapy Facility
September of this year marked another important step forward in our life sciences journey when I turned the sod on the new cell and gene therapy facility at the National Institute for Bioprocessing Research and Training. This €21 million investment in NIBRT, an important incubator for biopharmaceuticals in Ireland, underscored the Government’s commitment to meeting the needs of future employers, manufacturers, and patients alike.
Through IDA Ireland, we have invested over €80 million in NIBRT. This cutting-edge, state-ofthe-art facility is world class, and since 2013 has grown from strength to strength, training and preparing people in Ireland today to step into tomorrow’s roles.
Transforming the Global Pharma Landscape

Looking to the future, digitalisation and increasingly sophisticated technology will transform the ways that we develop and manufacture medicines, as well as how we diagnose and treat patients. Advanced Therapy Medicinal Products (ATMPs) are transforming the global pharmaceutical landscape and revolutionising health for millions of patients.
We are no longer on the threshold of a digital transformation of manufacturing that will change the very bedrock of how we
create, control, and produce quality medicinal ingredients and products. We are already there. The advent of digital, smart, and advanced manufacturing methods will benefit us all.
ATMPs such as cell and gene therapies, antibacterial treatments, and microbiome therapies are poised to enhance the lives of those who live with cancer, cardiovascular disorders, diabetes, HIV and AIDS, Alzheimer’s, as well as immunological, neurological, and mental health disorders.
The Contribution of Life Sciences
These last few years have shown us our vulnerabilities. The Covid-19 pandemic has brought home to every one of us that what happens in laboratories and on production lines affects us all. The innovations and breakthroughs in the development of mRNA vaccines have helped to give us back our society and to resume our normal lives.
The hard work, perseverance, and innovation of you who work in the life sciences has meant
Taoiseach’s Foreword
2 4 Irish PharmaChem | Industry Buyers Guide 2023
Leo Varadkar, An Taoiseach
that 2022 brought a relieved and welcome return to our everyday lives. Without your efforts in producing life-saving vaccines against Covid-19, we might again have spent a distant and lonely holiday period. We are all grateful for your enormous contribution.
Strategic Direction of Ireland’s Enterprise Policy
The Department of Enterprise Trade and Employment’s Enterprise White Paper outlines the strategic direction of Ireland’s enterprise policy. It does so in the context of challenges, opportunities and new drivers of growth and will work to protect the core elements which make Ireland an attractive location for enterprise.
It examines the risks we face as a small, advanced economy, the compromises that we may accept, and the policy choices that underpin it all.
Taking stock of Ireland’s industrial policy in the round has afforded us a moment to consider what is working well? What should be continued and cultivated? What can be adapted? Unquestionably, continuing to foster talent and innovation in sectors such as pharma will be a priority for Government.
Next year marks 50 years of Ireland’s membership of the European Union and our unwavering commitment to the single market. There is much to do to ensure adequate pathways for patients to access lifesaving and life-changing medicines. Closer collaboration between industry and the State on the operating environment for medicines innovation and investments is the way forward.
Consolidating Our Strengths
As we look to the coming year, our focus is on consolidating our strengths and on remaining resilient in the face of challenges. Competition for global investment is stiff, but we are confident that we remain a world-class destination to invest and grow business.
We know how important the life sciences are to our economy and we look forward to attracting and sustaining further investment from the sector well into the future. I am confident of Irish PharmaChem’s continued success in 2023 and wish you all the very best for the coming year.


 Leo Varadkar, An Taoiseach
Leo Varadkar, An Taoiseach
Taoiseach’s Foreword
5 Irish PharmaChem | Industry Buyers Guide 2023
BioPharmaChem Ireland
BioPharmaChem Ireland Publishes Sixth Industry Strategy

BioPharmaChem Ireland (BPCI) and its members used the recent lockdown to work intensively of the preparation of its latest industry strategy report for the sector. Titled ‘Make Ireland the Global Leader in Sustainable Biopharmaceutical and Chemical Manufacturing’, it is the sixth in a series of such reports published by the association. We consulted with the members of BPCI over a period of about 18 months to come up with the report, which clearly outlines a way forward for this important sector. The entire project was led by BPCI Senior Executive, Nessa Fennelly, supported by BPCI Chair, Paul McCabe of APL/ VLE Therapeutics. It is intended that this report will inform our stakeholders of our priorities in the coming three years.
The report was shared first at a private dinner for the sector held during Biotech Week in Boston in late September. The dinner was held in partnership with IDA Ireland and The National Institute for Bioprocessing Research
and Training (NIBRT) and included a number of US-based companies, as well as some Irish companies, including Thermofisher, Vertex, MSD, APC/VLE, Avantor, DHL, MorphoSys and many others.
Given the importance of the US to the sector in Ireland through foreign direct investment, it was considered very important that the USbased industry was prioritised as a stakeholder to the Irish sector. The strategy was also presented to the International Council of Biotechnology Associations (ICBA) and the National Association of Manufacturers (NAM), both based in Washington DC.
BPCI held two events under the Biopharma Ambition banner in Ireland this year. Biopharma Ambition is a partnership between BPCI, the Irish and Pharmaceutical Healthcare Association (IPHA) and NIBRT. The first of these, titled ‘Davos by the Lee’, was held in Cork, where it brought together

most of the Chief Executives of the industry to debate key strategic issues for the sector with a panel of global industry experts. The event was sponsored by Thermofisher and the Biopharmachem Skillnet and was addressed by international speakers from Sanofi, J&J, Pfizer, Novartis, Thermofisher and Eli Lilly. The event also focused on promoting and supporting the indigenous or local based life sciences industry too, and we were joined by Poolbeg Pharma, Avectas and APC/VLE.
The second event was a joint policy forum on the future of medicines, supported by the Department of Enterprise Trade and Employment, which was held at NIBRT. More than 90 delegates attended to hear presentations around Advanced Therapeutics, talent, the role of Intellectual Property supporting biopharmaceutical R&D and the need for the EU to prioritise manufacturing in biopharmaceuticals. The event was opened by Minister of State at The Department of
Sector o vervie w
Irish PharmaChem | Industry Buyers Guide 2023 6
recently published its sixth industry strategy, entitled Make Ireland the Global Leader in Sustainable Biopharmaceutical and Chemical Manufacturing, writes Matt Moran, Director, BioPharmaChem Ireland.
Enterprise, Trade and Employment, Dara Colleary TD, and featured speakers from the Mater Hospital, Innopharma, NIBRT, Eli Lilly and Charles River Consultants, while we at BPCI took the opportunity to present our new strategy to the audience.

It was clear from the discussion that followed the presentations that there is clear need for an integrated approach to biopharma in Ireland where, despite significant investment in manufacturing and development, companies still find it difficult to provide the latest therapies to Irish patients. Clinical research and even the provision of clinical trials is underdeveloped in Ireland. This supported one of the central recommendations in the BPCI strategy – the urgent need for an Office of Life Sciences within Government. This office would be charged with developing a clear Life Sciences Strategy for the country. In a joint budget submission from BPCI and Ibec’s Medtech Ireland, this was recommended too, in concert with a clear national strategy for health technologies. This
Pictured at the BioPharmaChem Ireland strategy launch in Ibec Offices in Brussels on November 29, 2022, are (l-r): Matt Moran, Director, BioPharmaChem Ireland; Sean O’Reagain, Deputy Head of Unit, Industry 5.0 DG Research and Innovation – European Commission; Jackie King, Director, Ibec Global; Sean Kelly MEP; and Ian Jones, CEO, Innopharma.
will simply bring Ireland in line with other life sciences powerhouses such as the UK, Israel and France.
Central to the BPCI strategy are six thematics or pillars, which are outlined below:
• Industry 5.0
• Provision of Talent
• Support for the manufacture of Active Pharmaceutical Ingredients (APIs)

• Contract Development and Manufacturing
• Global Business Services
• Advanced Therapeutics, including Cell and Gene Therapies
A Growing Sector
The sector exceeded the €100 billion mark for exports last year and proved its worth to the economy during the recent pandemic, both as the sector that actually came up with the vaccine for Covid but also one of the essential sectors that stayed fully operational during the period. A period where those who worked within the sector kept the lights on at the many manufacturing plants all around
Sector o vervie w
Strategic themes 2023-2027 Cell and Gene Therapies (CGT)/ Advanced Theraputics • Adoption of an integrated approach to CGT by State Agencies • Realising Ireland’s potential in next generation biologics including the development of a thriving indigenous and start-up ecosystem • Identify a funding strategy for CGT Contract Development and Manufacturing Organisation (CDMO) Focus on development of project management and CRM skills • Ensure that labour intensive assets are kept in Ireland • Map the full-service provider ecosystem Global Business Services (GBS) National strategy to identify future GBS talent needs • Branding of GBS as Global Location of Choice Establishment of an “Office for Life Sciences Make Ireland the Global Leader in Sustainable Biopharmaceutical and Chemical Manufacturing 22 Active Pharmaceutical Ingredients • Sustainability grants for renewable energy Development of a major supply chain hub in Ireland • Develop a footprint of API in Ireland Industry (Pharma) 5.0 • Sponsor and promote Ireland as the location of choice for the sustainable manufacture of medicines • Focus on digital skills Bring new products to Ireland and grow the ecosystem Skills • Continue to provide adequate funding for competitive funding such as Springboard, Apprenticeships and Skillnets allowing the Biopharma industry to be talent developers – not just consumers. Ensure the recommendations of the Expert Group on Future Skills Needs (EGFSN) are implemented involving all relevant stakeholders. Ensure Ireland’s Higher Education Insitiutions are aligned and sufficiently resourced to meet the future skills needs of the Biopharma sector. 23 A strategy for the sector 2023 - 2027
Irish PharmaChem | Industry Buyers Guide 2023 7

Sector o vervie w Irish PharmaChem | Industry Buyers Guide 2023 8
the country, often at some personal risk. It is testimony to each and every one of these facilities that they were able to ensure that any risk to their workforces was minimised during that difficult period.
Every member of BPCI came together every week, led by Michael Gillen of BPCI, to exchange knowledge and ensure that the guidance that came down from Government and the Health Authorities was as clear and practical as possible.
As the membership of BPCI considers the future of the sector, a couple of underlying principles underpinned their thinking.
1. The Installed Base
Significant capital has been invested by the sector in all forms of biopharmachem manufacturing: in chemical manufacture, in the manufacture of APIs – or small molecule manufacture, in the manufacture of biotech or biologic substances, and the manufacture of medicinal products. It is now estimated that the sector is still investing at least €1 billion per annum in new capital projects.


Some of the major recent announcements are outlined in Table 1.
If this base is to be retained and if it is to continue to grow, it is vital that it stays competitive, hence the emphasis on Pharma 5.0. by the sector, which led to the establishment of a Lighthouse Project. Not only
A sample of investments in the sector in 2022
approach to digitisation or Factory 4.0; this must happen in biopharma where the employee remains central to continued production of medicines that are safe and efficacious so that the world’s patients can continue to benefit and be cured of diseases. Government is due to publish a major report on skills for the sector through is Expert Group on Future Skills Needs (EGFSN). This is a follow-up to their 2016 report and will be timely as the global war for talent hots up.
2. Future Trends

Over 1,000 clinical trials are underway globally in Advanced Therapeutics – this encompasses Cell and Gene Therapy, Gene Therapy, Regenerative Medicine and Car-T. If Ireland is to sustain its base into the future, it is important that it participates in this. This can take the form of manufacturing such products, and Takeda in Grangecastle have already invested in a cell based manufacturing facility. There could also be an opportunity for local companies to enter the market – APC/VLE have already set up a CGT unit in Cherrywood, Maynooth-based Avectas have developed a platform technology to help CGT companies, St James’ and CGT-Vector are developing and administering Car-T products to Irish patients.
Ireland has developed a thriving Global Business Services sector which continues to develop its remit beyond traditional financial services to more specialist medical services, which could also encompass digitisation of autologous CGT. If Ireland can align its GBS and manufacturing sectors, it can copper-fasten the sector more.
BPCI hosted a Round Table in the Ibec Brussels Office in collaboration with Ibec Global and Innoglobal (part of the Innopharma Group) at the end of November to share its strategy report with its EU stakeholders. The Round Table was joined by Members of the European Parliament; Sean Kelly MEP opened the event, and Sean O’Reagain, who heads up the Industry 5.0 unit and DG Research in the European Commission, also contributed, both sharing their thoughts on 5.0. An Irish Pharma 5.0 strategy was presented by Ian Jones, founder of Innopharma, and Bryan O’Donnell of J&J updated the group on the Lighthouse Project. Jackie King, Director of Ibec Global, joined the meeting too.
must it stay competitive but it must also operate sustainably – this too is addressed under the principles of 5.0.
The availability of sufficient talent is also critical – there needs to be a huge emphasis here. Pharma 5.0 talks of a human-centric
It was great to see so many pharma industry folks gathered at the recent pharma industry awards – over 600 at the brand new Radisson Golden Lane Convention Centre. Congratulations to all those companies who were shortlisted and to those who won awards. There was real air of celebration in the room and a big shout out to Mark Barrett and Brian Glennon of APC/VLE who have shown that we can develop our own successful biopharma companies here in Ireland – they are going from strength to strength. Long may it continue!
Sector o vervie w
€400m invested in Limerick €36m invested in Dublin €27m invested in Dublin €12m invested in Waterford €100m invested in Dublin €150m invested in Cork €440m invested in Cork €140m invested in Tipperary 19 A strategy for the sector 2023 - 2027
Irish PharmaChem | Industry Buyers Guide 2023 9
Table 1: Sample of Investments from the sector
From Organic Intermediates to Biochemicals, from Performance Chemicals to Food Ingredients, Camida can source, manage and deliver your needs.
Whether your business is in pharmaceuticals, food, biotechnology or surface coatings, we meet the highest industry standards and conform to the most stringent international protocols.
Tap into our global network and over 30 years’ experience in sourcing specialised chemicals.
We understand your needs, we provide solutions, above all, we exceed your expectations.
Visit www.camida.com, email us at info@camida.com or phone us at +353-52-6125455.
LIFE SCIENCE INDUSTRIAL INGREDIENTS your
is
Search
over
BPCI Strategy Sets Out the Roadmap to Future Success
BioPharmaChem Ireland’s new strategy for 2023-27 aims to ‘Make Ireland the Global Leader in Sustainable Biopharmaceutical and Chemical Manufacturing’.

It clearly sets out its vision, whereby Ireland will be the globally recognised centre of excellence for innovation and development in the sustainable manufacture and supply of biopharmaceuticals, pharmaceuticals, and chemicals, and the location of choice for the launch of new products.
In his introduction to the Strategy, BPCI Director Matt Moran acknowledges that if this vision is to come to fruition, Ireland must overcome a series of challenges, including:
• The need for a future focused industrial policy championed by Government;
• The importance of broadening our sectoral ecosystem beyond manufacturing & supply;
• A supportive environment to enable indigenous SMEs to grow & flourish;
• The ongoing challenge to create a sustainable talent pipeline;
• The imperative to continue to stay competitive and innovative.
The Irish Government need to publish a Life Sciences Plan, Moran stresses, setting out a 10-year strategy for the sector to build on Ireland’s extensive life sciences expertise, demonstrated by the successes of the Covid-19 response over the past two years. The strategy, he writes, should highlight what all life science stakeholders (regulators, industry, academia, NGO’s, HSE etc.) need to do to create an environment in which the life sciences industry can continue to grow and flourish.
The BPCI Director stresses that a central part of this strategy needs to be the establishment of an Office for Life Sciences that reflects international best practice in industrial policy by embracing clustering to champion research, innovation and the use of technology to transform health and care services, led by the Department of Enterprise, Trade & Employment with support from other departments.

The Government and any subsequent Office for Life Sciences needs to review global best practice in ecosystem development as a mechanism for strategy/ecosystem development, such as the MIT REAP Regional Entrepreneurship Acceleration Programme (MIT REAP), according to the Strategy. MIT REAP provides opportunities for communities around the world to engage with MIT in an evidence-
based, practical approach to strengthening innovation-driven entrepreneurial (IDE) ecosystems. A typical MIT REAP region has a population of 1-10 million people.
By adopting industrial policies that promote clustering, we can create the means to achieve more strategic methods of cooperation across sectors both vertically and horizontally, with key stakeholders represented.
BioPharmaChem i reland Strategy
BioPharmaChem Ireland’s latest strategy identifies six strategic themes which will underpin the future success of the sector here and ensure Ireland remains at the forefront of sustainable biopharma and chemical manufacturing going forward.
The BPCI Strategy calls for the establishment of an Office for Life Sciences that reflects international best practice in industrial policy by embracing clustering to champion research, innovation and the use of technology to transform health and care services.
Irish PharmaChem | Industry Buyers Guide 2023 11
This view is reinforced by the OECD ‘Empowering the health workforce: Strategies to make the most of the digital revolutions’ which advises that a successful digital transformation requires system-wide reorganisation, underscored by an overarching strategy, with leadership that establishes a framework for coordination among decision making actors.

As we enter the new era of Advanced Therapeutics, partnership will be critical between industry, the Government and the HSE, Moran argues, if Ireland is to cement its place as a global hub for life sciences going forward.

Acknowledging Ireland’s successes in attracting FDI across the sector, the BPCI Director is also frank about where we have not been quite as successful, the development of a strong indigenous biotech sector, citing outliers like APC and Avectas as those who continue to break the mould and put Ireland on the map internationally in the biotech sphere, as well as the development of Spear Street Capital’s bioincubator at Cherrywood, South Dublin.
The Strategy reveals the six strategic themes, which BPCI believe will underpin the future success of the sector here:
1. Industr y (Pharma) 5.0
2. Skills
3. Active Pharmaceutical Ingredients (API’s)
4 Cell and Gene Therapies/Advanced Theraputics

5. Global Business Ser vices (GBS)
6. Contract Development and Manufacturing Organisation (CDMO)
1. Industry (Pharma) 5.0
The two most significant challenges facing Europe over the next decade are the transition towards a climate neutral society and the retention of our industrial competitiveness. Industry 5.0 can help drive this twin transition and involves the interpretation of Industry 4.0 Technologies through a human-centric lens, broadening the focus from solely shareholder value to value for all stakeholders in society and indeed greater resilience – particularly of supply chains and the manufacture of strategically important goods.
Recent disruptions have shown the importance for Europe to be more self-reliant and flexible in manufacturing and supply to adapt to changing conditions.
There lies an opportunity for the sector in Ireland to defend its competitiveness, while at the same time meeting its sustainability targets reducing its carbon footprint. By embracing the principles of Factory 5.0, Ireland can ensure the long-term future of the sector here.
The Strategy provides a case study in the form of the Lighthouse 5.0 Partnership, a cluster of Irish based high-tech manufacturers, service providers and Government agencies formed with the goal of leveraging sectoral competencies and best practice experience to accelerate the transition of current operations towards Industry 5.0. Lighthouse 5.0 members include Life Science leaders like Lilly, MSD, SK biotek, J&J, Merit Medical, Thermo Fisher Scientific, Pfizer, GE Healthcare, and Merck, and the cluster is supported by IDA Ireland and Enterprise Ireland.
2.
Demand for the right kind of talent is becoming ever-more acute, which has been recognised by Government, who have tasked the Expert Group on Future Skills Needs (EGFSN) with the job of preparing a report on the current skills scenario within the sector in Ireland. Attracting and retaining talent are key priorities and life sciences leaders are transforming their talent acquisition strategies, selecting partners, piloting technologies and customising new recruitment and retention strategies. There is a strong business case for diversity, equity, and inclusion (DE&I), including its profound and very real power to attract the best talent and build highperforming teams.
The areas of product and technology transfer, downstream processing and quality professionals are under increased pressure to
locate talent. The rise of automation and artificial intelligence (AI) has brought new opportunities and with that, new skills are required. Companies are challenged with finding these skills within the current workforce and are now battling with every other industry sector in the world for ultrahigh demand talent.
The Strategy highlights the importance of continuing to provide adequate funding for programmes like Springboard, Skillnets and Apprenticeships, allowing the biopharma industry to be talent developers
The Strategy’s vision is for Ireland to be a globally recognised centre of excellence for innovation and development in the sustainable manufacture and supply of biopharmaceuticals, pharmaceuticals, and chemicals. Image from rawpixel.com.

BioPharmaChem i reland Strategy
Skills
Make Ireland the Global Leader in Sustainable Biopharmaceutical and Chemical Manufacturing A strategy for the sector 2023-2027
12 Irish PharmaChem | Industry Buyers Guide 2023

The BioPharmaChem Skillnet and Laboratory Apprenticeship Programme are cited of examples of how we can address the talent challenge.
3. Active Pharmaceutical Ingredients (API’s)
API’s have formed the traditional core of the sector when many of the large multinationals first established in Ireland and still represent a very valuable component of the industry. As global networks come under increasing cost pressure, it is vital that Ireland’s API sector stays competitive and continues to grow.
The Strategy highlights the Lighthouse Project on Factory 5.0, whose aims include digitising the sector, driving sustainability in the industry and developing a roadmap to support an ecosystem to bring the small molecule API sector towards the principles that underpin Factory 5.0. Advancements in automation, artificial intelligence (AI) and machine learning in recent years have improved the success rate in the structural design of small molecules. API companies are adding more sustainable manufacturing processes in line with stated aims to achieve zero carbon emissions from global operations by the mid-2020s onwards.
4. Cell and Gene Therapies/Advanced Therapeutics

Advanced Therapeutics represent a significant opportunity for the Irish biopharma sector. The Strategy notes the opening of Ireland’s first stem cell therapy production facility, with Takeda’s cell therapy production unit at Grangecastle. Cell and Gene Therapies comprise a major part of Advanced Therapeutics, with technologies such as CAR-T able to provide a route to the permanent cure of diseases such as cancer; the Strategy highlights the opening of Ireland’s National Adult CAR–T Cell Centre at St James’ Hospital, Dublin.
It is widely predicted that advanced therapeutics and vaccines will be the next big wave of biopharma growth, with analysts now predicting that CGT revenues will reach $1060 billion globally by 2025/26.
The Strategy highlights the development of the Cell & Gene Therapy (CGT) Forum and its mission to help make Ireland a global leader in the development, manufacture, supply and adoption of Advanced Therapies, including Cell and Gene Therapies and novel vaccines, through strong investment in worldclass training, an innovative research base, a supportive entrepreneurial environment and excellent clinical trials infrastructure.
5. Global Business Services (GBS)
A growing number of biopharma companies operate Global Business Service (GBS) centres in Ireland. While originally set up to manage finance for corporate networks, they have laterally diversified into other areas, including HR, management of medical information, and connected health. Such centres are becoming more aligned with the manufacturing part of the industry and could look to establish control towers to manage supply chain in CGT products, for example.
The Irish based GBS operations have earned a reputation for managing complexity and uncertainty, through their high knowledge base, and we need to ensure that Ireland is the location of choice for pharma GBS against other very competitive locations through our talent pool and raising the sector’s profile in the labour market. The key to this, it argues, is managing knowledge-based activity, as transactional activity moves to lower cost locations. Ireland is ideally placed to host CGT
‘Control Towers’ and leverage co-location with manufacturing sites, in addition to leveraging data to provide new insights/opportunities into the business.
The Strategy highlights the development of the GBS Skills Pathway Programme, a structured learning and development initiative that spans entry level to leadership development, with two accredited qualifications – a CPD Diploma in GBS and an MSc in GBS.
6. Contract Development and Manufacturing Organisation (CDMO)
The CDMO sector is expanding and evolving globally, driven by existing operators and the transfer of some existing API operations. The Strategy recognises the potential to expand this sector, building on Ireland’s excellent reputation for quality and strong regulatory compliance, as well as our geographical advantage, sitting at the bridgehead between the US & Eurasia.
CDMO is a labour-intensive enterprise, and an extensive ecosystem of suppliers is in place in Ireland (a mapping exercise of the fullservice provider ecosystem will demonstrate this) and should therefore be supported and promoted. There are enormous employment benefits associated with growing a service offering in CDMO, the Strategy maintains.
Government agencies need to focus more on the CDMO opportunity for Ireland and support growth for a service offering not only in small molecule but also in biologics CDMO’s, according to the Strategy. Specialist CDMO’s with a dedicated biologics capacity will be best placed to support companies in getting their innovations to market.
The pharmaceutical CDMO market has been valued at circa $90 billion, growing at 7% per year. Traditionally, investment has been directed at small molecule Therapeutics but recent years have seen the market share of small molecule treatments decline, while there is rapid growth in the volume of large molecule and biologic treatments.
To encourage the growth of CDMO’s in Ireland, we need to:
• Focus on development of project management & CRM skills;
• Ensure that labour intensive assets are kept in Ireland;
• Map the full-service provider ecosystem.
BioPharmaChem Ireland’s full Strategy is available to download at: www.ibec.ie/connect-and-learn/ industries/life-sciences-and-healthcare/ biopharmachem-ireland/bpci-strategy-2022.

BioPharmaChem i reland Strategy 14
12 of the
medicines
11.2bn Covid-19 vaccine doses
in a single year 85+ companies Biopharmaceutical and chemical sector had an export value of €106bn in 2020 – the first time a sector has exceeded the €100 billion mark in a single year. Over 80,000 employed directly and indirectly by the
Over €10bn in
investment A profile of
BioPharmaChem Sector 67% of the total goods exported from Ireland Make Ireland the Global Leader in Sustainable Biopharmaceutical and Chemical Manufacturing 14 Ireland has one of the largest shares of tertiary education with 47% of 25-64 year-olds having third level degrees, with 85% of tertiary educated adults employed and enjoying greater earnings according to the OECD Ireland has an exemplary compliance record with regulatory agencies like the Food and Drink Administration (FDA) and European Medicines Agency (EMA), who collaborate and work closely with our Health Products Regulatory Authority (HPRA) to achieve trouble-free compliance. 10 of the top 10 world’s Biopharma companies 19 of the top 20 global pharma and biopharma companies based in Ireland 50 FDAapproved pharma and biopharma plants 25% of all PhD researchers in the Irish industry are employed in the sector. 15 A strategy for the sector 2023 2027 Irish PharmaChem | Industry Buyers Guide 2023
topselling
manufactured
produced
sector
capital
Ireland’s
Astellas Ireland Co., Ltd.
Kerry Plant
Killorglin
Co. Kerry
Astellas Ireland Co., Ltd.

Damastown Road
Damastown Industrial Park
Mulhuddart
Dublin 15
We are in the business of breakthroughs – the kind that transform patients’ lives. Dedicated to our mission of discovering, developing and delivering innovations that help patients prevail over serious diseases. We’ll never give up on our search for more hope, for more people, around the world.

Visit bms.com/ie to see how we’re driving meaningful change for patients, their loved ones and for the communities and societies we all share.
2022
All rights reserved. NO-IE-2200034 November 2022
©
Bristol-Myers Squibb Company.
Investing in Ireland’s Biopharma Future


In early November 2022, I was privileged to be invited to attend the Biomanufacturing World Summit in San Diego. The Summit is an annual gathering of a few hundred of the world’s leading biopharma and biotech executives, who come together to discuss the state of the biopharma and biotech sector and focus on how best to address the challenges and seize the opportunities in the world of biologic medicines manufacturing. It was the first post-pandemic in-person running of the event and, as well as the great buzz created by people coming together to meet each other after the long break, there was also a surprisingly positive overarching theme evident over the two days.
The general sense was that in spite of the devastating impact that the Covid-19 pandemic had on every person and community around the world, the industry had learned many important lessons over the pandemic period, including how to navigate the clinical development and regulatory systems more efficiently, how to manufacture at scale quickly and safely, and how
Darrin Morrissey, CEO, NIBRT, highlights the post-pandemic trends in the global biopharma industry, the innovations driving the sector forward and the role of NIBRT in strengthening Ireland’s leadership position in global biopharma manufacturing and supply.
to get supply chains for life-saving medicines and vaccines cranking at speeds never before seen. As the pandemic dissipates, what is now emerging is a biopharma industry that has developed much greater resilience in how it manufactures and supplies medicines than before, as well as an appetite for greater and quicker rates of innovation.
A standout moment from the conference was a presentation on day one from Arleen Paulino, Senior Vice-President for Global Manufacturing at Amgen, who presented on the top five
post-pandemic trends that are impacting the biopharma industry. In summary, these trends are:
1. The world is in a period of unprecedented change and headwind – and this will be the situation for the foreseeable future.
These headwinds include the pandemic itself, the inflationary effect of war and other factors, shrinking margins, the price pressure on innovative medicines, geopolitical threats, and the accelerating crisis of talent attraction and retention. These changes are challenging
NIBRT
Irish PharmaChem | Industry Buyers Guide 2023 17
At PBC Biomed we can help your idea become a reality by partnering with you to accelerate your innovation to patients.


AIM takes an idea from concept to commercialization quickly, while de-risking potential roadblocks along the pathway to success.
Please scan the code above to visit the PBC BioMed website and to find out more about AIM
Technology Valida on Technology Op misa on Concept Refinement Commercial Development
Introducing
AIM
for every person and every industry, including biopharma, but they also create a climate that promotes more innovation and a motivation to think differently.
2. Biopharma supply chain. From weak link to resiliency.
The pandemic has taught the industry valuable lessons on how to build quickly and maintain a resilient supply chain. There is now a strong appreciation that a strong supply chain strategy, coupled with resilient, adaptive supply chain infrastructure, are critical must-have assets for a successful biopharma company.
3. Innovation in biopharma is accelerating and this creates massive complexity.
The appetite for innovation in healthcare globally is increasing, and this need is being matched by new therapeutic modalities being developed and launched. This shift towards innovative products has been further accentuated by the pandemic. New drug modalities, including mRNA, oligonucleotides, cell-based and gene-based technologies, are being approved and introduced with increased speed, so much so that this rapid evolution in biological-based, genetically-targeted medicines is leading some to call this era the ‘biocentury’. Overlaying these new bio-therapeutic modalities are new digital technologies that are playing an ever-increasing role in the manufacturing and supply chain processes.
4. Smart Manufacturing is happening –now!
It is clear to see that the biotech and biopharma sector is increasing in sophistication and complexity. Automation and predictive technologies are increasingly being integrated with process and people at the heart of the biopharma manufacturing and supply chain process. Advanced automation, along with better data flow, visibility and analysis, digital quality

surveillance and the use of other technologies – like blockchain, artificial intelligence, virtual reality etc. – are leading to steady transformation and ultimately increased resilience and efficiency across the manufacturing and supply value chain.


5. Talent is now so important to the industr y that it has become a major differentiator and a point of competitive advantage.
The attraction and retention of talented staff, and the training and support of these key people, is now of critical importance to biopharma manufacturing companies. Moreover, the shift in the make-up of the workforce towards the new generation of workers is forcing companies to consider the ways of working and benefits on offer. Generation Y workers are now starting to enter the workforce in steadily greater numbers and are looking for more meaningful careers, professional development and flexibility over more traditional working practices. Companies’ ability to match these expectations will become
NIBRT delivers nearly 40,000 training days to 4,600 trainees and students annually.

ever stronger predictors of success in the future.
The biopharma pipeline – increasing innovation and diversity
The PhRMA report, Innovation in the Biopharmaceutical Pipeline, published in December 2021, represents a snapshot of drug development activity. The report outlines how there were approximately 12,600 potential NME projects at clinical development phase at the time of publication. Of the total number in development, approximately 50% are small molecule chemistry-based products and 50% are a combination of biological and Advanced Therapy products.
25% of the total clinical development projects involve more traditional monoclonal antibody and recombinant protein-based products. However, this category now also includes increasing numbers of more complex multi-specific antibodies and antibody drug conjugates (ADCs), which use highly selective monoclonal antibodies joined to other agents such as cytotoxic small
NIBRT
Irish PharmaChem | Industry Buyers Guide 2023 19
NIBRT has ambitions to also play a leading role in attracting the next wave of biopharma innovation.
NIBRT already has a curriculum of world-leading biopharma courses from Springboard+ and operator level to degree and Masters level, across the full range of traditional biopharma manufacturing skills areas.
molecules to target cancer.
4.3% of the total were projects involving cell therapies. Cell therapies are highly innovative products, in which healthy, functioning cells are themselves the therapy and are introduced to treat a disease or condition. An additional 2.7% (348 projects) were in gene-modified cell therapies, in which a functional gene is introduced into a cellbased therapy to improve its therapeutic effect. An example of a gene-modified cell therapy is chimeric antigen receptor T-cell (CAR-T) therapy, where a cancer patient’s blood cells are extracted and their T-cells isolated, which are then genetically engineered and reinjected back into the same patient. The engineered T-cells then activate that individual patient’s immune system to specifically target the particular cancer. CAR-T therapies have proven to be remarkably effective at not just treating but effectively curing certain previously fatal blood cancers.
Further exciting classes of therapies in development and highlighted in the PhRMA report include:
• RNA and DNA therapeutics (265 projects, 2%), where directly introducing RNA/DNA can produce a therapeutic or prophylactic effect – e.g. the Covid-19 mRNA vaccines.
• Gene therapies (281 projects, 2.2%), in which a corrective gene is introduced directly into a patient to treat or prevent a disease.
• Oncolytic viruses (133 projects, 1%), in which tumour-seeking viruses infect tumour cells and replicate themselves until the cells burst, releasing markers that allow the cancer to be recognised by the immune system and an immune response is then mounted against the cancer.
• Gene-editing products. These are highly experimental products based CRISPR-CAS9
Left and right: The €21 million expansion of the NIBRT facility will incorporate more Advanced Therapy research and training capacity.

technology, and at time of writing only seven clinical development projects were active globally.
Innovation, complexity and the shifting biopharma landscape - an opportunity for Ireland
Over the last 20 years, Ireland has established itself as a global leader in biopharmaceutical manufacturing and has experienced tremendous success in attracting multinational companies to establish monoclonal antibody and recombinant protein manufacturing operations across the country. Biopharma foreign direct investment (FDI) has topped €10 billion over the last decade, with the number of pharma manufacturing facilities now standing at over 85 across the country, biopharma facilities at over 25, over 40,000 people now directly employed in the sector and biopharma contributing over €40 billion in national exports annually – see http://IDAIreland.com.

At the San Diego World Summit meeting recently, it was highlighted that there is much work to be done on standardising the platforms for the manufacture of novel therapies, most notably
Cell and Gene Therapies and oligonucleotides. Similar to the productivity challenges experienced with monoclonal and recombinant protein manufacturing in the 1980s, improving the manufacturability of Advanced Therapies through process development and other intensive research is widely recognised to be a critical success factor towards ensuring these medicines can be more affordable, safe and available for widespread patient access. The availability of well-trained talent for the intensive manufacturing processes is also a critical factor for success.
Building on a successful track-record, strong existing infrastructure, a highly experienced workforce and a history of supportive government investments, Ireland has a strong potential to play a major role in the efficient, cost-effective and safe manufacture of Advanced Therapies. Ireland has a mature system of higher education, research and training institutes, and expertise across life science and digital technologies built up over the years, and a uniquely central geographic location, which when taken as a whole can be uniquely attractive to biopharma and biotech companies operating in the advanced therapies area.
NIBRT
20
Irish PharmaChem | Industry Buyers Guide 2023
NIBRT – expanding its important role, supporting biopharma growth


The strategic vision of IDA Ireland, and the Irish government of the day, to invest in the establishment of the National Institute for Bioprocessing Research and Training (NIBRT) in the late 2000s, and ongoing investment since then, has been shown to be pivotal in helping Ireland to win and sustain the biologics manufacturing investment over the last decade. NIBRT now has ambitions to also play a leading role in attracting the next wave of biopharma innovation.
On the training and skills front, NIBRT already has a curriculum of world-leading biopharma courses from Springboard+ and operator levels to degree and Masters levels, across the full range of traditional biopharma manufacturing skills areas, including upstream processing, downstream processing, fill-finish operations, QC Micro and single-use technologies. Recently, NIBRT has also been introducing various novel biologic modality and biopharma 4.0 / digital courses into its curriculum. A selection of these advanced technology courses are:
• Introduction to Advanced Therapies/CGTs;
• Introduction to Cell Therapy;
• Introduction to Gene Therapy;
• Fundamentals of Vaccine Manufacture;
• Introduction to Data Analytics for Biopharma Manufacturing;
• Advanced Data Analytics for Biopharma Manufacturing;
• Biopharma 4.0 Strategic Workshops in partnership with Boston Consulting Group (BCG).
More information on when these and other courses are running in 2023 can be found in the just-published NIBRT Training Catalogue 2023: www.nibrt.ie/nibrt-publish-trainingcatalogue -2023.
Growing research areas
NIBRT’s research team has been growing over the last decade, and we now have a team of over 50 researchers, led by eight principal investigators, working on industry collaborative projects with industry partners, as well as various SFI, Enterprise
Ireland and Horizon Europe-funded projects. From an initial core focus on monoclonal and recombinant protein research, which included research into the fundamentals of manufacturing cell biology, complex protein characterisation and integration, automation and digitalisation for applied process control, NIBRT’s research has recently been evolving into Advanced Therapy areas, including:
• Viral vector characterisation and optimisation of the manufacturing process, with potential applied uses in gene therapy and vaccine manufacturing;
• Cell therapy activities, such as novel modified cell therapy manufacture, developing workflows for CAR-T generation and process control/monitoring and utilisation of single cell ‘omics’ to monitor modified T cell therapy manufacturing;
• mRNA research focused on synthesis of modified oligonucleotides/mRNA, lipid nanoparticle formulation and characterisation, understanding and manipulation of translation.
At a national leadership level, NIBRT has played a strong central role in the establishment of the Cell and Gene Therapy Forum (CGT), along with many stakeholders from industry, academia and government. The CGT Forum produced a White Paper which laid out a series of recommendations for increased investment in workforce
development, research excellence and national infrastructure. The CGT Forum White Paper was important in supporting a business case that led to a decision by IDA Ireland to invest €21 million in the expansion of the NIBRT facility to incorporate more Advanced Therapy research and training capacity. This expansion is currently under construction, and it is anticipated that the new facility, incorporating dedicated research laboratories and training suites for Advanced Therapeutics, will be completed and open for business in Q2 2023.
In conclusion
As we anticipate the next few years of opportunity and challenge, NIBRT looks forward to playing its own uniquely important role in supporting the biopharmaceutical manufacturing industry in Ireland and internationally, by training the people who make life changing biologically-based medicines and undertaking research that grows the fundamental understanding and delivers impactful solutions to improve manufacturing processes of complex biopharmaceuticals and advanced therapeutics.
The foundations are already laid and NIBRT is committed to playing a leading role, along with our partners at IDA Ireland and across the ecosystem, in enabling Ireland to capitalise on the next phase of the biopharma opportunity.
NIBRT – the National Institute for Bioprocessing Research and Training – was established in 2007 with the mission of supporting the biopharma manufacturing facilities in developing talent and skills through world-leading training and addressing complex manufacturing challenges through excellent research. Over the years, NIBRT has gone from strength to strength and the Institute now delivers nearly 40,000 training days to 4,600 trainees and students annually, as well as delivering a diverse range of research projects with funding from industry partners, state funders and the European Commission.
NIBRT
Irish PharmaChem | Industry Buyers Guide 2023 21
The extension to NIBRT will incorporate dedicated research laboratories and training suites when it opens in mid-2023.
We make healthy possible.
Amneal Ireland is located on the Cahir Road, Cashel, County Tipperary.

Should you wish to be part of our team in the manufacture of high-quality, affordable medicines, please see all our job openings on the Careers section of our website
The facility is dedicated to the production of metered dose (MDI) and dry powder (DPI) inhalers.

www.amneal.com
If you are interested in a career with Anmeal Ireland, please send your CV to careers.cashel@amneal.com
www.amneal.com/cashel

Lab Apprenticeship Programme expands to Cork
The Laboratory Apprenticeship Programme provides apprentices with practical skills for a career in the life sciences sector and ensures businesses have job-ready applicants for laboratory roles.
Apprenticeships have been identified as an essential route to develop skills and shape new career pathways and address the emerging skills gaps industry are experiencing.

The Apprenticeship is quickly becoming a very popular route for those interested in roles across STEM.
Apprenticeships are an exciting and recognised way for employers to develop talent for their company and the sector. The positive influence of learning, which is closely linked to the workplace, provides huge benefits for both employers and apprentices, and is documented to improve social mobility. Employers can proactively support a pipeline of talent targeted to their own needs and learners have the unique opportunity to earn nationally recognised qualifications whilst also gaining invaluable hands-on work experience. Since 2016, the Government has invested over €620 million in the expansion of the apprenticeship system, launching the New Generation Apprenticeships to promote and support apprenticeship development in new and emerging sectors of the Irish economy.
This investment also saw the introduction of over 33 industry-led programmes to date, with many more in development, with qualifications ranging from Level 5 to Level
Siobhán Dean, BioPharmaChem Ireland, writes on the overwhelming success of the Laboratory Apprenticeship Programme, which has recently expanded, with 11 new apprentices beginning training in Munster Technological University, Cork.

9. The Government set out a target that by 2025 there will be 10,000 new apprentice registrations per annum. To help achieve this target, the action plan for apprenticeships was launched in 2021, outlining a range of recommendations and supports, such as the employer grant and opening applications for new apprenticeships on an ongoing basis, allowing employers and education providers to develop apprenticeships in response to evolving industry skills needs as they arise.
Laboratory Apprenticeships: Development and Outcomes
The Laboratory Apprenticeship is one of the newer pathways for candidates hoping to start a career in the laboratory. The programme not only offers opportunities within the pharmaceutical sector, but also medical devices and diagnostics, chemical manufacturing, independent testing labs and the food and drink sector. The programme was designed by industry in partnership with Technological University Dublin as one of the outputs from the EGFSN report on the skills needs of the biopharma sector in 2016. At the time it was
estimated that over 8,000 new roles would be developed by the sector by 2020. CSO figures have shown that the sector has surpassed this growth, showcasing the need for the sector to explore the different routes to develop skills.
The skills and tools apprentices learn are practical and applicable to a real-life role in a laboratory in the life sciences sector. The apprentice attends college two days per week (off-the-job) and the workplace three days per week (on-the-job) during term (they work five days in their sponsor company during college break) so naturally, by the time they complete the programme, they are already knitted into the fabric of their sponsor company and have a thorough understanding of the business needs and how everything fits together. On completion of the apprenticeship, participants are job-ready, equipped with the skills and knowledge required to work in any regulated laboratory environment.
Feedback from Employers and Apprentices
This apprenticeship programme offers an array of benefits not only to the candidate,
Laboratory a pprenticeship p rogramme
23 Irish PharmaChem | Industry Buyers Guide 2023
but to the employer as well. The apprenticeship programme allows the employer to access a completely new talent pipeline and helps them with talent attraction and retention issues. As the apprentice is learning theory in college to support practical work in the lab, it ensures that work-ready candidates graduate from the programme.
Our sponsor companies often speak about how the laboratory apprentices have brought a fresh new attitude to the laboratory and are extremely passionate about what they are learning.


Andrew Hayes, Senior Manager, Human Resources at Helsinn Birex Pharmaceuticals Ltd, said: “The creation and successful launch of the BPCI National Laboratory Apprenticeships was a passion project for many pioneers within the biopharmaceutical sector. We believed that these apprenticeships would engage and develop a parallel source of untapped talent into the evergrowing sector, giving a chance to those with different learning needs, while complementing the ongoing recruitment of those with the necessary traditional third-level qualifications, all to ensure the ongoing supply of much needed skills to the industry. The experience of participating companies has been overwhelmingly positive.”
The Laboratory Apprenticeship Programme has been delivered in Technological University Dublin, Tallaght and South East Technological University, Waterford, for the last number of years. The programme is being expanded nationally, with Munster Technological University, Cork, welcoming 11 apprentices in September 2022 and other education providers have expressed their interest to deliver the programme.
Hear from Apprentices Themselves
We recently caught up with some of our apprentices, to get their take on the programme:
“I am a qualified Dental Nurse, but always wondered about a new career and a dream job for me in the lab,” says Milena Smokowska, a laboratory apprentice with Merck. “I thought
a career change would not be possible as I would need to have a wage to provide for my family while gaining my qualifications. When I heard about the Laboratory Apprenticeship Programme, I was slightly sceptical but decided to apply the very same day. Once I learned about the structure of the course, I couldn’t have been happier. Gaining a degree while earning a salary and not compromising on family time couldn’t’ have been more appealing to me. The apprenticeship offers many benefits. Whether you choose a twoyear or three-year course, throughout this time, you are gaining valuable experience and
confidence, which gives you a huge advantage for future employment.”
Jennie Jones, a lab apprentice with Sanofi, says: “The Laboratory Apprenticeship Programme has allowed me to retrain whilst gaining great experience in the pharmaceutical environment at Sanofi. Applying the academic knowledge that I have learned from the course to my everyday roles and responsibilities has helped to accelerate and improve my understanding of the industry.”
For more information on the Laboratory Apprenticeship Programme, please email labapprenticeship@ibec.ie.

Laboratory a pprenticeship p rogramme
Irish PharmaChem | Industry Buyers Guide 2023 24
The Laboratory Apprenticeship Programme has been delivered in Technological University Dublin, Tallaght and Southeast Technological University, Waterford, for a number of years, and has recently expanded to Munster Technological University, Cork.
Your Ideal Partner for the Development and Manufacture of APIs
Our team in Cork is expert in developing and manufacturing API for clinical and commercial supply
Our campus in Cork is a state-of-theart contract API development and manufacturing facility, where our team support our customers in bringing medicines to patients through the relentless application of science in process and analytical development. We take chemistry from laboratory scale development through to large-scale commercial supply, made

possible by our driven and dedicated employees - a team of 500+ highly skilled chemists, engineers, analysts, operators and crafts personnel. Our facility meets with the most stringent production, compliance, safety and environmental standards. We take pride in our mission to enable our customers to make the world healthier, cleaner, and safer.
Learn more at https://www.patheon.com/sites/cork-ireland/ or email us at contactcork@thermofisher.com


Your advantages with DACHSER Chem Logistics Specialised chemical logistics expertise and standardised logistics solutions Automated processes with consistent electronic interface documentation High standards of safety and quality for the chemical industry, assessed according to SQAS A uniform European network Complete transparency with innovative IT systems A high degree of expertise in handling dangerous goods DACHSER Ireland Ltd. • Dublin Branch Blackchurch Business Park • Rathcoole County Dublin • D24 C796 • Tel.: +353 1 4013333 dachser.dublin@dachser.com • dachser.ie Logistics in its element. DACHSER Chem Logistics 211112_ANZ_CHEM_Keyvisual_680_IR-EN_180x130_V05.indd 1 15.11.2021 17:09:05 Carbon Group, Ringaskiddy, Co. Cork, Ireland, P43 R772 T: +353 21 4378 988 Contact: Carol Deegan T: +353 86 261 2485 E: carol.deegan@carbon.ie Suppliers of a wide range of raw materials/blending services to the pharmaceutical, biopharma and medical device industries
BPC Skillnet: Offering Flexible and Relevant Training
Established over 15 years ago, BioPharmaChem Skillnet’s goal is to promote an organisational wide climate of whole-company talent development in the area of industry specific technical and nontechnical training within the life sciences sector. ioPharmaChem Skillnet is a Skillnet Business Network that supports and enables the growth and development of staff in global and indigenous organisations across Ireland.
Promoted by BioPharmaChem Ireland (BPCI) and co-funded through Skillnet Ireland and participating companies, BioPharmaChem Skillnet, through continuous interaction and engagement across industry, has developed into a network with unique capabilities to support talent development, while also facilitating invaluable research, networking and benchmarking activities.
The BioPharmaChem Skillnet works in alliance with Ibec industry association BPCI to help companies across the broad life sciences sector to identify current and evolving skills needs. It meets those needs through the provision of a range of specially designed education and training programmes,
ranging from short rapid learning sessions to virtual reality programmes on highly technical aspects of the manufacturing process, and fully accredited diploma level programmes.

Customised Training Programmes
BioPharmaChem Skillnet also meets the specific needs of individual companies through the delivery of customised programmes which can then be reworked for roll-out to other companies in the sector. Participating companies and their employees are directly involved in the identification, design, delivery and evaluation of training, ensuring it is relevant and aligned to the needs of the sector. BioPharmaChem Skillnet provides programmes that are:
• Cost efficient – subsidised utilising the buying power gained through the wider Skillnet Ireland structure;
• Relevant companies can tailor the intervention to the exact training their staff need;
• Convenient – delivered at a time and a location that suits participating companies;
Susan Costello, Network Manager, BioPharmaChem

• Of a high quality – we source the best and most experienced training providers. Through networking, companies can accelerate learning and advance their competitive advantages, whilst employees up-skill and gain positive personal and economic benefits.
Evolving Talent Development Needs of Industry
Ireland has a strong international reputation for life sciences; the biopharmachem sector in Ireland employs over 72,000 people both directly and indirectly. Our workforce is well-known to be highly educated and agile. As outlined in the recently launched BioPharmaChem Ireland Strategy, 57% of employees in the biopharmachem sector are third level graduates and 25% of all PhD researchers in Irish industry are employed in the sector. The continued demand for highly educated, skilled workers will increase significantly over the coming decade,
27 Irish PharmaChem | Industry Buyers Guide 2023 TRAINING & DEVELOPMENT
The BioPharmaChem Skillnet provides businesses with industry-specific and even company specific training programmes, explains Susan Costello, Network Manager, BioPharmaChem Skillnet.
Skillnet.
TRAINING & DEVELOPMENT
BioPharmaChem Skillnet has commenced development of a sectoral map of Ireland that will profile the companies, products manufactured, supply chain and employment opportunities. In addition to this, the network is hoping to secure funding to develop a skills framework for the sector, demonstrating the occupations and skills required within the biopharmachem sector and having a clear, defined framework outlining the critical functions and key tasks, along with the skills and competencies required to perform them. The network will then work with industry and education providers to ensure that the relevant talent development programmes for the skills and competencies required are available.
Talent Needs within the Sector
In the early years of the 21st century, the sector saw significant expansion into biopharmaceutical manufacturing and a contraction in chemical API manufacturing. Through the past few years, another wave of technological change is evident, with a renewed expansion of the chemical API sector, driven by new product launches and the employment of new continuous manufacturing technologies. This comes at the same time as a new era for biopharmaceutical manufacturing emerges with the growth of Advanced Therapeutic Medicinal Products (ATMPs), also termed Cell and Gene Therapies (CGTs), encompassing cells as therapies, gene therapies and engineered tissues with applications across infectious diseases, oncology, immunology and autoimmune diseases.
the relevant talent development programmes are available.
Equality, Diversity and Inclusion Research
A major undertaking for the BPC Skillnet in the past year has been the completion of a research project on Equality, Diversity and Inclusion in the biopharma sector in Ireland, with the support of the BPCI Diversity & Inclusion Working Group. The aim of the research was to gain a demographic snapshot of the biopharma sector, including but not limited to: gender diversity, cognitive diversity, demographic diversity, and intellectual diversity.
As expected of a high tech sector, almost all biopharma manufacturing sites offer flexible working hours, with many having additional policies, including agile working programmes (93%), top-up to fully paid maternity leave (85%), other compassionate leave (85%), and formal training/support for further education & learning to facilitate promotional opportunities (80%). However, the research found that fewer businesses had policies for menopause (5%), neurodiversity (7%), fertility treatment (7%), chronic/ invisible illness (10%), transitioning/transgender (15%) and formal return to work programmes (17%). The data from this research will feed into appropriate learning offerings in the near future.

Looking to the Future
requiring the up-skilling of current employees for new digitised roles and re-skilling of people from adjacent industries who can successfully transfer over to the biopharmachem sector.
The past three years have been unprecedented, with periods of significant change and growth, which have driven organisations to increase the rate of change within their operations. These challenges have presented opportunities and we are very proud of our significant achievements over this period. These achievements, driven by the needs of the sector, have been guided by Skillnet Ireland’s strategic pillars of Workforce Design, People Development and Strategic Innovation. BPC Skillnet has been instrumental in facilitating business transformation in industry by offering talent development solutions to companies and allocating significant resources to future skills needs.
VR Training Programmes
As the industry increases its digitisation and leverages information technologies to improve its performance, the BPC Skillnet continues to develop and launch training programmes utilising virtual reality (VR). Having developed and launched VR programmes on Aseptic Technique for Biopharmaceutical Manufacturing and Powder Handling for API Manufacturing, the network has secured funding for the development of a third module, Health and Safety, aimed at SME businesses within the sector.

Additionally, there has been huge growth in Contract Development and Manufacturing Organisations in Ireland, where we are seeing an increase in outsourcing clinical and commercial activity, which are new outsourced roles. A number of these organisations have acquired manufacturing facilities in Ireland in recent years and are contracted not only to manufacture products, but also perform process development and validation work. We are working closely with companies nationwide to ensure the talent needs for these roles are met and
As the sector continues to expand through the development of newer products, companies within the sector are facing challenges in recruiting personnel with the appropriate skills and backgrounds. The top roles experiencing recruitment challenges include quality (68%), engineering (63%), research and development (46%), regulatory affairs (44%) and manufacturing (37%). The BPC Skillnet, with its demonstrated commitment to partnering with businesses to deliver innovative learning and development solutions, looks forward to working with the sector to identify, develop and deliver innovative talent development solutions to companies in the sector.
28 Irish PharmaChem | Industry Buyers Guide 2023
The BPC Skillnet continues to develop and launch training programmes utilising virtual reality.
Would you compromise on safet y?
Kolliphor ® P 188 Bio –The right choice for your formulation
BASF Kolliphor ® P 188 Bio is a parenteral grade surfactant that is designed for both Biopharma Formulations and Bioprocessing. Poloxamer 188 has a long history of use in approved and marketed biologic drugs.

Kolliphor ® P 188 Bio is a high purity poloxamer 188 that meets customers’ needs in quality, consistency, and performance in the formulation of parenteral biologic drugs including antibodies, therapeutic proteins, gene therapies, and vaccines.
Why use Kolliphor ® P 188 Bio instead of other poloxamer 188 grades?
+ Designed specifically for the biopharma industry

+ Higher purity improves consistency and reduces manufacturing and safety risks
+ Superior packaging meets manufacturing requirements
Get in contact with our expert for further information and free product samples
Inspiring Medicines for Better Lives www.pharma.basf.com
Enterprise Ireland Supporting Strong Life Sciences Sector

Despite the economic challenges and headwinds facing businesses globally, Irish enterprises have shown incredible resilience and have grown from strength to strength in every sector in recent years.
Companies supported by Enterprise Ireland in the wider life sciences, inclusive of pharma and the chemicals sectors, last year posted gains in net job creation and in export growth. Employment increased in this portfolio of companies by over 10% in 2021 to over 10,000 across all regions of Ireland. Sales in the sector increased last year to over €2.5 billion, of which €2.1 billion were exports.
These gains were achieved despite the many challenges facing companies in recent years and were complemented by significant investment in research and innovation in Ireland. These numbers, and the internationally competitive nature of our uniquely collaborative research and innovation community, are incredibly strong foundations on which to build future growth.
Supporting Innovation
Through our needs-led innovation programmes, commercialisation projects in our Higher Education Institutions, high potential start-ups (HPSUs) and the established Enterprise Ireland clients we work with, these efforts have all contributed to supporting innovators, many of whom have limitless ambition. Irish innovators and entrepreneurs are competing and excelling
Garrett Murray, Head of Life Sciences, Enterprise Ireland, reports on the strong performance of Irish life sciences companies supported by EI, and explains the pillars of Enterprise Ireland’s new strategy, Leading in a Changing World (2022-2024).

are exemplars for those commercialising their research or looking to scale their companies.


What is also not immediately recognised is the number of Irish companies contributing to the supply chains of those on the front lines of drug discovery and production. This is true across services, equipment supply, facility construction and digital platforms, among many more.

Ireland at the Cutting Edge
Irish small and medium enterprises (SMEs) and large Irish-owned companies, based on their experience at the cutting edge in delivering for their customers, have the potential to support the expansion of the growth of these sectors in Ireland.
in terms of innovation and product and service development in the global market. And in fact, many Irish companies saw the challenges posed by the pandemic and worked to deliver solutions and scale.
Ireland has a number of global players and ambitious entrepreneurs in these sectors that
Enterprise Ireland is also very optimistic that we will see innovative Irish companies at the core of these sectors that will continue to grow, and that we will see new leaders emerge in this space. In this guise, prioritising supports for innovative start-ups, with a particular focus on increasing the total number of HPSUs that spin-out of the research system in the pharma sector, remains at the core of our strategy.
Leading in a Changing World

Enterprise Ireland’s new strategy, Leading in a Changing World (2022-2024), anticipates Irish start-ups and scaling companies taking key positions in major global markets. We see a

Ent E rpris E i r E l and
Irish PharmaChem | Industry Buyers Guide 2023 30
Garrett Murray, Head of Life Sciences, Enterprise Ireland.
Enterprise Ireland: Proud to support Irish businesses




















At Enterprise Ireland, we work with ambitious and innovative Irish companies across all sectors to help them grow and compete internationally. Whether it’s funding, capability building or advice on exporting to new markets, we have the support to help you achieve your global ambition. Visit globalambition.ie
huge opportunity for Ireland to be at the heart of a new wave of innovation, led by Irish top talent. Through this strategy, we will be looking to support companies to achieve success in line with our five strategic ambitions:

• Export-focused Irish enterprises delivering growth across all regions of Ireland;
• Ireland as a world-leading location to star t and scale a business;
• Irish enterprises achieving sustainable competitive advantage through customer-led innovation and digitalisation;


• Irish enterprises leading globally on sustainability and achieving climate action targets;
• The world’s most successful enterprise development team.
Advancing the development of these sectors will only happen through collaboration between industry, the national and European research community, Government and industry bodies, working together on shared objectives to support the ambition of Irish enterprise. And this is something that Enterprise Ireland is proud to support.

Ent E rpris E i r E l and
Garrett Murray of Enterprise Ireland is pictured with members of the VLE Therapeutics team visiting their lab in Dublin.
Enterprise Ireland see a huge opportunity for Ireland to be at the heart of a new wave of innovation, led by Irish top talent.
Irish PharmaChem | Industry Buyers Guide 2023 32
Irish innovators and entrepreneurs are competing and excelling in terms of innovation and product and service development in the global market.
Mallinckrodt is building on our 155-year history of providing medicines that address patient needs. We have operated in Ireland - the home of our global corporate headquarters - for more than 25 years.


Since 2016, we have opened new offices, a manufacturing facility and a Global Device Engineering laboratory at the College Business and Technology Park, in Blanchardstown, Dublin15.

FDI critical to Ireland’s Biopharma Growth

Pictured at a €443 million investment announcement by Merck were (l-r): Mayor of The County of Cork, Cllr Gillian Coughlan; Martin McAuliffe, Managing Director and Head of Cork Operations, Merck; An Taoiseach, Micheál Martin TD; Matthias Heinzel, Member of the Executive Board of Merck and CEO Life Science; and Michael Lohan, Head of Lifesciences and Talent, Transformation and Innovation, IDA. The €443 million investment will allow for an expansion at Merck’s existing facility in Carrigtwohill, in addition to the construction of a new manufacturing facility at Blarney Business Park, both in Cork.

2022 has been a challenging year for us all. In February, as Ireland continued to work to get the Covid-19 pandemic under control and to get our economy back on track, the Russian invasion of Ukraine resulted in a huge spike in energy input costs to add to the supply chain challenges that our industry faced because of Covid. And while working to ramp up the construction of housing following the property crash of 2010, Ireland grappled with housing solutions for some 64,000 Ukrainian people seeking refuge here from the war.
Despite these headwinds, global Foreign Direct Investment (FDI) entered 2022 with strong momentum. In Ireland, the number of FDI projects reached record levels in the first half of 2022. There were strong levels of investment by both new and existing investors in Ireland. A total of 155 investments were won, with associated employment potential of over 18,000 jobs. 73 of these were new investors in Ireland, while the same number (73) of the 155 investments won went to regional locations.
This performance underlines the country’s ongoing reputation as a competitive, stable and resilient place in which to do business. However, the global economy is now facing severe challenges, with the outlook dependent
on the future trajectory of the Russia-Ukraine war, inflation, monetary policy and geopolitical developments.
Key Areas to Address
The outlook for IDA’s 2023 pipeline remains relatively positive despite this difficult operating context. However, in a challenging external environment, we need to ensure that Ireland has the immediate and medium-term absorptive capacity to support continued growth. The key areas requiring attention remain planning, housing, energy, water and transport. Policies that support the continued availability of talent are also critical. Managing costs in the current inflationary environment and executing on planned capital projects will be challenging, but important for Ireland’s continued competitiveness.
The jobs and revenue created by multinationals helped to keep Ireland out of recession when the pandemic hit and are now giving the Government the financial firepower to ease the cost-of-living crisis and
avoid recession once again. Ireland’s existing base of Foreign Direct Investment is a core national asset. The benefits of FDI include direct employment of over 275,000 people, 72% of Ireland’s export sales, 70% of corporation tax, and direct expenditure on pay, materials and services totalling €27.9 billion.
Ireland has worked hard to create a welcoming environment for FDI in all parts of the country as the strong regional spread of jobs and investment in the biopharmaceutical industry demonstrates.
The life sciences industry globally has excelled in its response to the Covid-19 pandemic. The development of effective vaccines and therapeutic medicines so quickly has saved countless lives and greatly reduced the impact of the virus on all our lives. The industry in Ireland has certainly played its part and is part of the global supply chain that has produced the vaccines and medicines that were so badly needed. Throughout the pandemic, all the biopharma manufacturing plants in Ireland continued to operate successfully without
IDA
Rory Mullen, Head of Biopharma, IDA Ireland, stresses the continued impact of Foreign Direct Investment on the Irish pharma sector and highlights the areas to focus on to ensure that Ireland remains a key player in biopharma going forward.
Irish PharmaChem | Industry Buyers Guide 2023 34

any interruption in the supply of the essential innovative medicines that are produced in Ireland.
A Thriving Biopharma Industry

The biopharma industry has continued to grow and thrive in Ireland and IDA client companies in the sector now employ over 42,500 highly qualified people directly. In the last year alone, there have been 15 announcements of new investments or expansions in the sector. These new investments have been all over the country and they will ensure that the recent growth in employment continues.
Highlights during 2022 included announcements by Eli Lilly of plans to invest €400 million in a new biologics drug substance manufacturing facility in Limerick and Merck KGaA’s announcement of investment of over €440 million in the development of their membrane manufacturing capabilities in Cork, including the development of a second site in Blarney. Horizon and Eirgen both announced the development of their manufacturing capabilities in Waterford and in March Janssen announced a €150 million investment to develop their manufacturing operations in Cork.
It was also particularly heartening to attend the opening of Takeda’s cell therapy production facility in May and Meira GTX’s opening of their 150,000 square feet gene therapy facility in Shannon in September. Whilst we are continuing to win investment across both the small molecule and biologics manufacturing sectors, these investments in Advanced Therapeutic Medicinal Products (ATMPs) will ensure that Ireland continues to be a leader in biopharma manufacturing as more of these exciting and innovative new therapies are developed. These new advanced therapies will continue to transform the ways in which we can help patients.

There has also been an increase in the number of biopharma companies expanding their global business services activities in Ireland in commercial, regulatory and development activities.
Commitment to Continued Development
The Irish government is fully committed to the continued development of the sector in Ireland.
The new government-funded Advanced Manufacturing Centre in Limerick has already started to work with companies in the sector and construction of NIBRT’s additional capacity for the development of their Cell and Gene Therapy capabilities is well underway. IDA Ireland will also continue to work closely with global biopharma companies to ensure that their activities in Ireland are successful.
I was delighted to join BioPharmaChem Ireland and several of our mutual clients in Boston in September at the launch of BPCI’s strategy for the continued growth and development of the sector in Ireland. I am always impressed by the culture I see in our biopharma clients that is so focused on the delivery of innovative medicines that can transform people’s lives. I am also heartened to see the industry collaborating to solve the common challenges that the industry now faces, including digitalisation and sustainability.
I wish BioPharmaChem Ireland and its members every success in 2023 and assure you of IDA Ireland’s continued support for the future growth of the sector in Ireland.
I believe that Ireland has a strong future in biopharma and will continue to be a global leader in manufacturing and process development for many years to come.
In addition, I believe that the advanced services activities that our client companies are increasingly establishing in Ireland will continue to grow and develop. I look forward to working with BioPharmaChem Ireland during 2023 to ensure that that we have all the building blocks in place for the continued success of our existing and future investors.
IDA
Pictured at the opening of Takeda’s cell therapy production facility in May are: Conor Simpson, Regional Manager, IDA Ireland; Ambassador Mitsuru Kitano, Japanese Ambassador to Ireland; Rory Mullen, Head of Biopharma, IDA Ireland; and James Dinniss, Takeda’s Bray site head.
“The jobs and revenue created by multinationals helped to keep Ireland out of recession when the pandemic hit and are now giving the Government the financial firepower to ease the cost-of-living crisis and avoid recession once again. Ireland’s existing base of Foreign Direct Investment is a core national asset.”
Rory Mullen, Head of Biopharma, IDA Ireland.
Irish PharmaChem | Industry Buyers Guide 2023 36
Budget. Capacity. Technical knowledge.
These are just some of the obsticals that can stand in the way of your biologic’s market approval. Are you prepared for them? With Charles River supporting 85% of drugs approved by the FDA in 2019, leverage our experience and expedite your time to market. We can provide the services, capacity and know-how that can help you bring your therapies to those who need them most.
Improve your odds at criver.com/biologics.

Only .01% of all drug candidates entering clinical trials will reach the market.
Our inspiration and our Guiding Star.
At Alexion, our mission is to transform the lives of people affected by rare diseases and devastating conditions through the development and delivery of innovative medicines, as well as through supportive technologies and healthcare services. alexion.com

College Park is home to over 650 people AND:
• Bulk Drug Substance Biologics Manufacturing
• Commercial & Clinical Secondary Packaging
• QC Global Centre of Excellence
• Quality Assurance Release & Certification
• External CMO Management
• Global Supply Chain, Finance, HR and IT Functions
Athlone is home to over 215 people AND:
• Aseptic Drug Product Biologics Manufacturing
• Commercial Drug Substance Biologics Purification
• Clinical Drug Substance Biologics Manufacturing
ANNA LIVING WITH HPP
Grainne Power, Director of Compliance, Health Products Regulatory Authority, explains how the HPRA has developed a framework to tackle medicine shortages nationally, in conjunction with other stakeholders.
The World Health Organization recognises medicine shortages as a global problem. While medicine shortages have been a global issue for some time, they have increasingly affected Ireland and other European countries, significantly affecting patient care and total healthcare costs. In 2018, the Health Products Regulatory Authority (HPRA) took on a coordinating role in managing and preventing medicines shortages. As part of this, the HPRA developed a framework to facilitate a consistent and aligned approach to managing medicine shortages in conjunction with other stakeholders. The holistic approach, involving a coordinated approach from multiple stakeholders, has enabled a comprehensive framework to tackle availability issues nationally.

Although the framework was implemented before the extraordinary events of the last two years, it has proven a timely intervention and has provided a basis for responding to the challenges of Brexit and the Covid-19 pandemic through the piloting of approaches and the development of effective collaborations.
The Importance of Early Communication and a Collective Approach
This two years of experience illustrate that early communication and collective approaches effectively prevent shortages or limit their impact on patients if this is not possible. This was demonstrated initially with Brexit but most recently and critically in the context of the Covid-19 pandemic, particularly during the first wave, which resulted in a significant unexpected demand for specific medicines. The close communication and aligned strategies among key stakeholders, such as the Department of Health, the Health Service Executive, the HPRA, healthcare professionals and the pharmaceutical industry as a whole, ensured an effective response to the challenges created by the pandemic and the need for continuity of treatment for patients.
The development and implementation of the multi-stakeholder framework for handling shortages in 2018 and its on-going development in the interim has been the first step in the national
Managing Medicine Shortages: a multistakeholder approach
response to shortages. A direct consequence has been gathering comprehensive data on the nature of shortages observed in the Irish market for the first time.
Key Trends and Main Findings
As part of a review of the initial phase of this multi-stakeholder framework, the HPRA examined the data gathered to identify the key trends and main findings. This review has identified some interesting findings and identified several strategies that can serve as the foundation for the next phase of the framework, further developing the management of shortages and driving the implementation of preventative strategies.
There is a need to optimise the notifications of
potential and actual shortages, including earlier submission of notifications in advance of potential shortages and improving the accuracy of the detail provided to maximise the opportunities to prevent potential shortages from being realised or limiting their impact. There are also pathways to address the challenge of avoiding shortages and mitigating their impact, aiming to tackle the causes and exacerbating factors. These include increasing supply chain resilience and reliability.
Manufacturing issues accounted for over 50% of shortages. This included delays in the material receipt, capacity issues and missing production schedules. Other illustrative examples of issues included errors in ordering, equipment breakdown, processing delays and integrating new equipment.
Irish PharmaChem | Industry Buyers Guide 2023 39 Medicine Shortage S
Medicine Shortage S
Although accounting for a small number of shortages, the HPRA has seen how cyber-attacks can significantly impact the entire IT system of a company, which causes temporary site closures and supply chain disruption.

Manufacturing site transfers have also been the cause of shortages, where insufficient buffer stock to bridge the gap between the old site ceasing production and the new site becoming operational has been the source of difficulty. Other issues related to quality defects and recalls and other aspects that did not result in a recall but prevented medicines from being released onto the market, such as manufacturing investigations and out-of-specification results.
Where shortages are due to these types of issues, it can be difficult to estimate accurate timeframes for the resumption of regular supply. In many cases, identifying the root cause(s), implementing corrective actions and subsequent release of new stock onto the market can take considerable time.
Supply Chain Vulnerabilities
It is apparent from the data gathered that failures associated with manufacturing issues are illustrative of the supply chain vulnerabilities, as the diminished capacity to anticipate, cope with, resist and recover from external shocks to the supply chain have resulted in shortages of medicines for patients in Ireland.
The requirement to strive for continuous improvement and the importance of robust processes to support the delivery of quality, safe and effective medicines has been a fundamental basis of Good Manufacturing Practice and the application of a Pharmaceutical Quality system. The prevalence of medicine shortages, however, highlights the challenge for the pharmaceutical supply chain to reliably deliver, in practical terms, consistent access to medicines. There is a need to continue to shift the paradigm and focus on the industry to achieve increased supply chain resilience that reduces the burden of shortages.
As the medicine regulatory system adapts to new demands, this focus on continuous improvement to strengthen the reliability and resilience of supply chains, to mitigate for potential fluctuations in the supply chain that could lead to shortages, is needed. This then enables the prevention of shortages where these areas are the root cause.
Recognising the Challenges Ahead
The global nature of the medicine supply chain will require more international collaboration and alignment to ensure the security of medicine supplies and shortage prevention. As referenced at the beginning of this article, recent public health emergencies and international situations have further highlighted many global challenges in ensuring medicines supply. These challenges have been recognised across the EU and more globally, and additional steps are being taken to tackle shortages.
The European Commission’s Pharmaceutical
Strategy includes a specific intention to address medicine shortages as a component of its four main pillars. The European Medicines Agency has been formally mandated to address this challenge on behalf of EU citizens, which is part of an internationally coordinated package to tackle shortages, and also includes:
• The further development of the European Single Point of Contact (SPOC) network, which has facilitated greater communication on shortages that may impact multiple countries;
• The European Joint Action on shortages, which represents a commitment by the European Commission to enable a co-ordinated approach across Member
States;
• The inclusion of medicine shortages in the European Medicines Agencies Network Strategy to 2025.
The international initiatives can also reciprocally help companies, such as manufacturers, based in Ireland to ensure that strategies to increase resilience can be successfully implemented and have the optimum chance of success in preventing shortages.
The continued engagement from stakeholders with the HPRA relating to the medicine shortages framework and continued drive by the industry to optimise resilient and robust processes will enable a more secure and agile supply chain, thereby contributing positively to people’s health and reducing the frequency and impact of shortages.

Irish PharmaChem | Industry Buyers Guide 2023 40
Grainne Power, Director of Compliance, Health Products Regulatory Authority.
Increasing supply chain resilience and reliability is key in tackling medicine shortages (Image from rawpixel.com).


Around the world, increasing controls on temperature assurance and regulatory requirements are having a profound impact on the pharmaceutical supply chain.
Beyond the increasing needs for compliance, the nature of the pharmaceuticals themselves is continuing to change. Investment in drug research is now predominantly focused on complex biologics and Advanced Therapeutics, with an associated increased personalisation of medical care and thereby, supply chains.
The integrity of these innovative medicines, in storage and while being transported, is guaranteed only with zero temperature deviations. Pharmaceutical supply chains that are future-ready, therefore, need to ensure stringent temperature control and visibility in real-time. It’s a future with challenges that DHL is well-qualified to address.

DHL has a deep knowledge of pharmaceutical market dynamics, standards and regulations, combined with many years of experience of developing specific solutions for the industry, including temperature assurance, special handling for vaccines and biologics, customisation, packaging and direct delivery to patients and customers.

In fact, here in Ireland, DHL Supply Chain has made its mark on both the Irish and global life sciences sectors within a short space of time, having only opened the doors at its Global Export Centre in Horizon Logistics Park, Dublin Airport, in 2016. Since then, they have become an established strategic partner to key pharmaceutical manufacturers in Ireland and around the world. Whether in R&D, manufacturing or finished goods supply chains, DHL has specialised in supporting biologics customers’ time-critical, temperaturesensitive needs. Across the whole team, for the past six years consistently, their passion and competency has ensured a patient-focused service geared to customer satisfaction, while achieving almost flawless KPIs. The business, part of a network of 175 depots globally, 23 of which are Clinical Trial Logistics depots, is compliant with the most rigorous regulatory and security standards, certification for all of which has been successfully renewed following re-inspections
DHL De L ivers on TemperaT ure Con T ro L
over the last 18 months.
The DHL Supply Chain Ireland team can also count on the support of the two other DHL divisions - DHL Global Forwarding and DHL Express - connecting customers to their customers and patients through a comprehensive multi-temperature shipment and medical parcel distribution network globally.
Expanding Capacity
Looking to the future, DHL’s new carbon neutral
airport site, which will be licensed in early 2024, will elevate Horizon’s experience and high-quality service to a much larger scale, allowing them to extend their support across multiple temperature regimes to the thriving biopharmaceutical industry in Ireland and support the needs of the emerging advanced therapeutics industry.
Quantum, a 200,000 square foot facility, located in North Dublin close to the existing Life Sciences & Healthcare Site at Dublin Airport, is ideal for global and European export and supporting Irish manufacturing plants. It will offer full sprinkler protection in all controlled ambient, chilled and frozen environments, designed to provide storage, pick, pack and conditioning services under stringent GDP and GMP conditions.
This state-of-the-art facility is a LEED Gold and BREEAM Excellent-rated site, equipped with the full range of levers to maximise the energy efficiency of the building and its operations, amongst which are intelligent business monitoring, rainwater harvesting, heat pumps and solar panels. Such features support DHL’s work to enable a more sustainable future whilst delivering excellence across the globe to their customers’ patients.

Supply Chain Resilience
The team at DHL Supply Chain Ireland are rightly proud of their track record over the last six years. From attaining their first global export customer
Irish PharmaChem | Industry Buyers Guide 2020 24 Supply Chain logi S ti CS
DHL’s goal is simple: putting the patient at the heart of everything they do.
DHL
Supply Chain has made its mark on both the Irish and global life sciences sectors within a short space of time.
ENSURING UNINTERRUPTED PATIENT SUPPLY

• Global distribution of investigational medicines and finished products
• Time critical, temperature sensitive patient supply
• Supporting the needs of Irish Manufacturing Plants
• Expanding GDP & GMP capacity in Dublin to help futureproof your supply chain
Learn more about how our expertise and resilience can help you with your supply chain needs: John Halpin, Business Development john.halpin@dhl.com + 353(0)86 0665865
DHL Supply Chain – Excellence. Simply delivered. www.dhl.com/gb-en/home/our-divisions/supply-chain.html
in 2016 to broadening services to include European clinical trials logistics in 2019 and then GMP importation and secondary packaging in 2020, the site has continued to adapt to everchanging market conditions, working upstream and downstream in customer supply chains.

“Our aim is to develop logistics services which will support both the continued growth of the global biopharmaceutical industry within Ireland and the country’s aim to be the global leader in sustainable biopharmaceutical manufacturing“ says Gillian McCann, Head of Life Sciences, DHL Supply Chain Ireland, “working across R&D, manufacturing and finished goods supply chains.

“Supply chain resilience is key,” she continues. “Pre-Brexit contingency solutions in Europe were required a number of years ago by global manufacturers needing to relocate European clinical trials hubs from the UK to protect patients’ supply in post-Brexit supply chains. We worked hard to gain the necessary licenses and skills to facilitate this service and to ensure that it was business secured for Ireland.”
According to Gillian, supporting manufacturing supply chains with storage of raw materials, API, drug substances, drug products and intermediate stocks, as well as GMP packaging and contingency and overflow services, also gained momentum during the pandemic, with significant licensed capacity required within the Irish market at short notice. “The pandemic also saw the need to establish new depots elsewhere in the global network, closer to customers and for increased agility and mitigating in anticipating supply chain disruption,” she notes. “Throughout the pandemic, uninterrupted patient supply was maintained, with one of our key customers telling us that they were delighted to have survived a global transportation crisis unscathed.”
The industry today faces unprecedented challenges and uncertainty as a result of difficult market, supply chain and geopolitical conditions. The need for significant flexibility, increased offsite capacity and more tailored solutions are anticipated in the coming years. These will support the increasing supply chain demands of manufacturers as they seek certainty of supply of key commodities and raw materials, and as Ireland gains ground in the development of Advanced Therapeutics.
“Our role in amongst all this disruption is to ensure that all supply chains, infrastructure and systems run smoothly,” Gillian stresses. “Investing in the right facilities and infrastructure, with the right level of redundancy and anticipating and managing risk and disruption before it impacts the manufacturer of the medicine.”
A Sustainable Sector that Drives Innovation
DHL Supply Chain Ireland is aiming to fulfil the group’s long-term strategy with a particular focus on further investment in key sectors such as life sciences and healthcare by continuing to develop the innovative services that their customers need. As a global logistics leader, DHL has played a key role in the delivery of 2.5 billion doses of Covid vaccines in 177 countries around the world, significantly enhancing its global capacity and
capability in cold chain and deeper frozen.
DHL invests heavily in innovation, with four dedicated innovation centres located around the world and with their innovation efforts driven by their Logistics Trend Radar, which sets the priorities for investments.

Within the industry in Ireland, the DHL Life Sciences team leverages these global initiatives and develops the solutions which will enhance their customers’ business. Most recently, they have completed an extension of services into deeper frozen (-40 and -70) to support R&D in biologics and have upgraded their warehouse management systems, providing enhanced functionality and enabling easier adoption of digital tools and end-to-end supply chain visibility.
DHL is aiming for zero emissions by 2050 to ensure a sustainable future. “We want to achieve this for, and together with, our customers,” explains Gillian. “As part of this, DHL Supply Chain Ireland will decarbonise our HGV fleet by moving to Bio Methane gas fuel, which will help reduce our carbon emission footprint to zero and all our new facilities will be carbon neutral, starting with the new Quantum Life Sciences facility in 2024.”
The Group also aims to become a leader in sustainable aviation, using Sustainable Aviation Fuel (SAF) and investing in the latest technology with the most fuel-efficient, only SAF-capable assets in the industry. These programmes will enable DHL to make its contribution to Ireland’s goal of sustainably manufacturing and supplying new medicines to patients globally.
Irish PharmaChem | Industry Buyers Guide 2020 24 Supply Chain logi S ti CS
DHL has a deep knowledge of pharmaceutical market dynamics, standards and regulations, combined with many years of experience of developing specific solutions for the industry.
The team at DHL Supply Chain Ireland are proud of their track record over the last six years.
Gillian McCann, Head of Life Sciences DHL Supply Chain Ireland.
Cara Partners 40 Years and Growing

A leaf from Ginkgo Biloba , believed to be the oldest living species of tree. The seeds and leaves of Ginkgo Biloba have been used in Chinese traditional medicine for over 800 years
Cara Partners manufactures a quantified extract of Ginkgo Biloba for the EU and Chinese market Ginkgo Biloba extract products are used to treat a variety of conditions associated with blood circulation disorders

Little Island Industrial Estate, Wallingstown, Cork Telephone : +353 21 4520500 www.carapartners.ie
SSPC: Fuelling Pharma Research



SSPC, the Science Foundation Ireland (SFI) Research Centre for Pharmaceuticals, is a hub of Irish research expertise, developing innovative technologies to address key challenges facing the (bio)pharmaceutical industry. The aim of SSPC is to deliver industry-relevant technical solutions, which result in job growth and retention within this sector in Ireland and grow the skills base of qualified scientists and engineers.
SSPC is uniquely positioned to bring together interdisciplinary expertise to resolve challenges across the pharmaceutical development process. Their applied research programme is directed towards solving the challenges of the now, while their fundamental research programme aims to create new knowledge to resolve the challenges of the future. The Centre has a broad research capability that encompasses scientific expertise in small and large molecule drug substance and drug product manufacturing, with a particular emphasis on process optimisation, data analytics and ATMPs.
The Centre’s focus is to make strategic collaboration a top priority and push the frontiers of knowledge under the Directorship of Professor Damien Thompson. Their mission is to realise an internationally leading interdisciplinary Centre in pharmaceuticals, engaged in industry-guided research that goes beyond the state-of-the art. This research will inform and enhance industry through the co-creation and application
SSPC Irish PharmaChem | Industry Buyers Guide 2023
46
SSPC has proven itself to be a dynamic hub of research expertise, bringing together academia and industry to address key challenges facing the biopharma sector.
Professor Damien Thompson, SSPC Director.
of new knowledge. SSPC will deliver on its mission through its people, science, industry engagement, global reach and societal impact.
A key component in the success of the pharma and biopharma industry is a wide range of research collaborations with Irish universities and research institutes and SSPC is building impact in the green (bio)pharma, small molecule, large molecule, health, education and public engagement space.
Measuring the Impact of SSPC
SSPC research impacts society by improving and advancing the sustainable production and the availability of medicines globally. SSPC’s research-based EPE work enables the Centre to work with community partners to deepen their understanding of and engagement with SSPC research.
SSPC plays a leadership role in bringing together international partnerships to advance these aims. As an example of this, SSPC is working with five of the world’s leading biopharma companies (Pfizer, Eli Lilly, Janssen, BMS and MSD) on a programme that aims to reduce waste, maintain standards and minimise costs in pharmaceutical processes by addressing the global protein A resin shortage.
Over the past year, SSPC has had two winners in the Irish Industry Pharma Awards Innovation of
the Year. Dr Waleed Faisal, UCC, received an award for the Microneedle ArrayPatch (MAP), a propriety wearable microneedle patch technology designed to treat local diseases. ArrayPatch consists of an array of sharp but painless dissolvable microneedles that penetrate the skin on application and then dissolve to deliver a local effective dose of medication. Secondly, Dr Luis Padrela, UL, received an award in celebration of his technology developed through CM-Nano. Life-saving cures are not reaching patients due to high failure rates at pre-clinical trial stage; nanotechnologies hold great promise to overcome these chemical barriers.
SSPC develops a significant pipeline of high calibre scientists and engineers for the sector through their internal PhD training programme and various CPD mechanisms accessed by their industry partners. The interdisciplinary nature of the Centre provides a unique environment where the students gain a valuable understanding of their research in the context of the whole manufacturing lifecycle. A key impact of SSPC is the creation of a unique talent pipeline, and the transition rate of SSPC researchers to industry currently stands at 53%.
By way of evidence, see SSPC’s EPSRCSFI Centre for Doctoral Training (CDT) in Transformative Pharmaceutical Technologies. The CDT is funded through a partnership between the Engineering and Physical Sciences Research

Council (EPSRC) in the UK and SFI in Ireland. Comprising of three academic partners - the University of Nottingham (UoN; lead), UCL and SSPC at Trinity College Dublin, University College Dublin and University College Cork in Irelandthe CDT equips doctoral scientists in Ireland and the UK to drive innovation in the pharmaceutical and healthcare sectors.
Collaborating with Industry
At SSPC, building engagement with industry and delivering value for the sector is a core objective of the Centre.
SSPC provides the sector with a nationally distributed, research performing community that enables high impact, collaborative research between industry and academic partners within the life sciences sector.

Since its inception, SSPC has successfully collaborated with over 50 industry partners, composed of indigenous and foreign operations, whose size ranges from small to multinational. Collectively, this demonstrates a strong trackrecord in delivering applied research that enables industry to solve challenges, leading to the development of better medicines. SSPC’s industry partners benefit from the depth and breadth of expertise available within SSPC and through their collaborations, they augment their R&D capabilities and increase opportunity for technology transfer and commercialisation.
SSPC’s success is defined through its unique collaboration abilities and through building R&D excellence in one of Ireland’s largest industries. The role that industry members play within SSPC is a multi-faceted one that is successful in both responding to the current needs of the sector and anticipating the skills and training necessary to mentor future research leaders.
Working with SSPC
Industry projects can be supported in a number of ways in SSPC.
1. Companies have the option to initiate fully funded industry specific research projects and own all project IP, thanks to a flexible Irish IP protocol that facilitates industry-led project collaborations with Irish research performing organisations.
2. Companies can also avail of SSPC cofunding (max. 50%), providing organisations with the opportunity to licence back any IP arising.
Working in partnership with the SSPC, your organisation can:
• solve key industrial challenges;
• develop R&D capabilities;
• attract new talent;
• co-author publications;
• upskill staff;
• network with industry peers in a worldleading international community of practice.
For more information, contact SSPC’s Industry Engagement Manager (aisling.arthur@ul.ie) or Business Development Manager (Jamie.guidera@ul.ie), or visit www.sspc.ie.
SSPC
Irish PharmaChem | Industry Buyers Guide 2023 47
SSPC has a broad research capability that encompasses scientific expertise in small and large molecule drug substance and drug product manufacturing, with a particular emphasis on process optimisation, data analytics and ATMPs.
Providing circular side stream solutions
Purifying water and recovering materials with mobile & modular installations
InOpSys is committed to providing circular waste or side stream solutions for the chemical and pharmaceutical industry, by building and operating mobile & modular purification installations on the customer site. Using a train of selective technology combinations, InOpSys efficiently closes water and material loops and thus helps the industry reach their sustainability goals by reducing waste and CO2 emissions.

Award-winning concept for API removal & metal recovery
InOpSys offers solutions to treat water and solvent streams, for:



• Active Pharmaceutical Ingredient (API) removal & recovery
• Metal removal & recovery (e.g. precious metals)
• Micropollutant removal
Awards:
• Imagine Chemistry Challenge AkzoNobel (2017)
• Belgian Business awards for the Environment (2018): first prize
• Solar impulse foundation (2021): efficient solution label
Selective and very high rate of removal
InOpSys uses a decentralized model, creating installations on-site, close to the side stream source. This allows working with unmixed and welldefined side streams, and avoids transport as a plus.
InOpSys is a one-stop shop, because we do not focus on one single technology, but on a hybrid combination of different technologies. Thanks to this “relay team” of technologies, very high removal rates can be achieved in a more efficient way compared to monotechnology solutions. This also allows InOpSys to remove pollutants in a selective way, leaving easily biodegradable components untouched.
CAPEX-free service
The customers are unburdened as InOpSys takes ownership from start to finish, and offers its service in a CAPEX-free way. InOpSys finances the installation via a pay-per-use model, which spares customers an investment which is not interesting enough according to their internal return on investment guidelines.
Contact details
www.inopsys.eu • info@inopsys.eu
+32 (0)495 653 821
Alternative for linear destruction
The costs associated with waste and emissions can thus be reduced and value can be created by the recovery of materials (e.g. precious metals like Pd, Pt, …).
InOpSys wants to do better than linear destruction (e.g. incineration) of hazardous side or waste streams in times of water and material scarcity.
advantages.
• Reach sustainability goals
• Reduce waste and associated costs
• Create value by recovery of material (e.g. precious metals like Pd, Pt, …)
• Reduce handling & transport of hazardous material
• Reduce CO2 emissions we offer.
• Circular economy solution
• CAPEX-free concept
• Selective removal of pollutants
• One-stop shop
• Ownership from start to finish
circular
One of the running on-site installations which recovers valuable Palladium, used as a homogeneous catalyst by the customer, and purifies the waste water, closing the loops
circular chemistry can save the world.
we believe in circles. advantages.
circular chemistry
we believe in circles. advantages.
SELECTIVE REMOVAL
circular chemistry can save the world.



www.inopsys.eu Don’t accept the status quo
The right shipment solution for when it matters the most
Kuehne+Nagel Healthcare Logistics simplifies your needs. Key benefits include:


Dedication to quality and service
Because your products require the utmost care during transportation and storage, we use our innovative technology and certified network to provide dedicated end-to-end solutions, so that you can focus on what matters most.
Meeting every requirement
Regardless of the compliance level required, our attention to detail will allow you to focus on what is important. We leverage our global network and local knowledge to ensure full compliance with industry regulations, global guidelines and local legislation.
Flexible end-to-end solutions
Our globally standardised systems and specific service offerings ensure that we always meet your exact requirements. Select the right service for each shipment based on the needs of your product.
24/7 control and rapid intervention
Do your shipments require special care? Our certified healthcare experts will meticulously
monitor your products and proactively intervene to correct any deviations.
Pioneering risk management
Our integrated approach to risk management ensures the optimal handling of your products throughout the entire supply chain, regardless of transportation.
Over 240 GxP certified operations and counting
You can rely on our advanced digital tools, including our global quality management system, risk management processes and predictive analytics, to give you full control and let you follow the journey of your products in real time.
Kuehne+Nagel is one of the world’s leading logistics providers with a network of nearly 1300 offices in over 106 countries. 80,000+ employees worldwide are dedicated to providing customers with technology and data-enabled transport services and logistics solutions. Local specialists ensure that Kuehne+Nagel delivers according to customer needs, complying with national and international regulations and industry requirements.
Learn more about how to benefit from Healthcare Logistics
@healthcarelogistics.kuehne-nagel.com
Our attention to shipment quality will allow you to focus on what is important — your patients.
Through collaboration with our experts from QuickSTAT, we can support you with global clinical trial logistics and personalised medicine transportation:
● Cell and gene therapy clinical supply chain planning;
● Direct-to/from-patient clinical trial solutions;
● Transport for early-stage R&D to pre-clinical testing;

● Temperature-controlled logistics solutions - from ambient to cryofrozen;
● Chain of custody/identity and GDP protocols to ensure product integrity and patient safety;
● 24/7 regulatory support and consultation;
● Online IT platform allowing for real time temperature and location tracking.
Learn more about how QUICK can support your business → quick.aero
Pharma & h ealthcare logistics s ervices Advertorial
PMTC: delivering value via collaboration

At PMTC, we harness the value of collaboration, first by identifying industry challenges and then transforming them into opportunities through targeted research which delivers value to the sector, leveraging both academic talent and our indigenous SME network.
Situated within the Bernal Institute at the University of Limerick, PMTC has a wide range of capabilities and extensive domain experience, ensuring we can remain relevant, agile, and highly responsive to the unique and growing needs of our member companies. Our team of experienced post-doctoral researchers support companies across the biopharmaceutical manufacturing sector in optimising their manufacturing facilities within the framework of our three core research areas:
1. Pharmaceutical Plant Cleaning - including containment, changeover, and verification;

2. Process Control and Optimisation;
3. Data Analytics and Utilisation.
Added to that, PMTC has a number of affiliated research performing organisations and research centres to assure we can place the industry need with the best academic talent and capabilities nationally.
The importance of pharmaceutical manufacturing to the Irish economy cannot be understated. Ireland is the largest net exporter of medicines in the EU, with over €90 billion worth of products being exported each year. This accounts for over 40% of the country’s total exports. The industry directly employs ca. 43,000 people, with comparable numbers employed in the provision of services to the sector. This critical sector is ever expanding and developing and PMTC’s objective is to support continued growth and competitiveness of the sector in Ireland through excellent research and development outputs.
With an emphasis on collaborative engagement
with our industrial partners, PMTC is strategically positioned to address real-world challenges within the pharmaceutical manufacturing sector, ensuring that the needs of this important sector are supported into the future. Sitting at the interface of industry and academia, PMTC supports the pharmaceutical manufacturing industry and its supply chain to solve problems, while differentiating itself by focusing on industryinformed research, where programmes are driven by real market needs defined by biopharma multinational operations in Ireland.
Focus on industry needs
As the pharma sites across Ireland embark on their digital transformation, we at PMTC are leveraging our deep domain knowledge and our growing digitally enabled infrastructure to support pharmaceutical manufacturing operations in identifying skills needs in the area of data analytics. Looking forward, PMTC aims to provide handson learning and development opportunities in a sandbox-type environment to promote innovation opportunities, such as digital transformation and continuous manufacturing, at Irish sites.
PMTC also recognises there are valuable synergies amongst the multinationals’ needs and the skills, services and products of SMEs nationally. Acting as the enabler to foster collaborations across these sectors is just one of the ways PMTC delivers value across the wider ecosystem of companies.
PMTC, with support from IDA Ireland and Enterprise Ireland, recently surveyed industry stakeholders on their current position and future needs. The study, titled ‘Delivering for Ireland’s Pharmaceutical Industry’, identified clear trends and challenges, while also pinpointing how supports can be matched to meet these challenges. The results of the study paint a positive picture of a
pharmaceutical manufacturing ecosystem that is expanding and building on its strong track record, reputation and innovative culture. The findings of this work give us a solid basis for further industry engagement and collaboration, while ensuring PMTC stays relevant to the future needs of the industry. The study has been distributed to PMTC industry members and is available to the public at www.pmtc.ie.
Sustainability
PMTC is well placed to support companies across the sector on their sustainability journey. The centre delivers high-impact research for pharma sites in Ireland; some of those already carried out include reduction in solvent volumes, reduction in downtime and faster cycle times. Research outcomes so far have enabled companies to save on costs of materials, reduce downtime, and improve process robustness, as well as helping to strengthen the competence of their site team through a deeper understanding of manufacturing technologies. One such example is the implementation of PMTC’s unique ATEX rated cleaning facility.
Cleaning has a significant impact on pharma plant efficiency, utilities and resources. Based on client testimonials and some recent survey data, it is estimated that some sites spent 50% of time on plant cleaning, severely impacting operations with excessive downtime, costs and delays across the supply chain. PMTC’s industry-designed cleaning facility will have a transformative impact by allowing offline development and transfer of right first-time cleaning processes to pharma plants, enabling better utilisation of their high value fixed assets, while maximising processing time to achieve optimal productivity. The facility was funded through Enterprise Ireland and endorsed by
An emphasis on collaborative engagement with our industrial partners ensures that PMTC is strategically positioned to address real-world challenges within the pharmaceutical manufacturing sector, writes Sarah Hayes, Centre Director, Pharmaceutical Manufacturing Technology Centre (PMTC).
PMTC
Irish PharmaChem | Industry Buyers Guide 2023 51
The PMTC study, ‘Delivering for Ireland’s Pharmaceutical Industry’, is available online at www.pmtc.ie.
ATEX rated cleaning facility at PMTC.
PMTC’s member companies. This unique capability within PMTC presents many opportunities for delivering competitive advantage to companies, including:

• replicating plant operations to develop new cleaning methodologies for new entities and supporting new product introductions at Irish sites;

• De-risk and prove the use of PAT tools for real time monitoring and verification of cleaning;
• Reduction in time, cost, and volumes of cleaning agents;
• Development of greener and sustainable processes by reducing waste and energy usage;
• Supporting tailored training to industry members in the areas of cleaning and cleaning validation, driving compliance and process robustness.


Societal and Commercial Impact
PMTC has an excellent track record in cleaning by developing methodologies to optimise cleaning processes toward more efficient and sustainable process. PMTC’s methodology combines experimental and computational methods to select the best cleaning agents and has been developed by the PMTC researchers and in collaboration with subject matter experts. Our methodology is based on three pillars:

• Chemistry; understanding the residues and the cleaning agents;



• Surface science; understanding the surfaces to clean;
• Fluid dynamics; understanding the cleaning agent’s delivery methods.
The outcomes of the cleaning activities fit squarely with the pharma industry’s green agenda as it allows the development of more efficient, sustainable, and greener processes by reducing time, costs, solvent, water waste and energy usage. It also allows companies to direct more resources into production which in return will increase their competitiveness. In addition, the use of PMTC cleaning method and access to our unique ATEX rated cleaning facility, as well as the centre’s expertise and training programme in the field of cleaning, offers the Irish pharma industry a unique opportunity to upskill their staff or to hire highly

skilled talent directly from PMTC.
PMTC has facilitated a number of key industry and academic partnerships in the last 12 months that have realised direct value into our national sector, namely:
• Enabling SMEs to showcase their innovative products across the MNC sector and drive adoption of best-in-class technology to support Industry 5.0;
• Enabling SMEs to understand key industry needs to pivot their innovative products to expand and grow their market;
• Targeting resources through grant funding to deliver impactful R&D projects and placements to industr y to meet knowledge gaps and expand researcher mobility to address gaps in national recruitment pool.

Innovation Through Collaboration
Collaborative engagement is core to PMTC. Our focus towards industry-led, highly engaged collaborative research strongly translates to the delivery of real impact for member companies through the research outputs delivered by the centre.

This strong emphasis on collaboration within the PMTC is not limited to the relationship between the centre and its members, but importantly, supports company-to-company engagement and collaboration across the Irish pharmaceutical manufacturing sector as a whole, thus enriching the eco-system in Ireland. In recognising this strong need for industry engagement, PMTC provides opportunities for companies to network and stay abreast of new technology developments through events such as the PMTC Knowledge Day, as well as technical workshops, communities of practice and training events.
Through our knowledge-sharing across the PMTC community and acknowledging that talent and capacity development across the pharmaceutical sector in Ireland is a key success factor for the industry, PMTC supports member companies in the continued professional development of technical personnel in member companies and always seeks new ways to strengthen the talent pipeline in Ireland.
To get involved or learn more, visit www.pmtc.ie or contact pmtc@ul.ie.
PMTC
November 2022 iPharMa Irish Pharmaceutical Manufacturing Ecosystem Analysis SURVEY RESULTS & DISCUSSION Outcome of an industry mapping survey of pharmaceutical companies in Ireland and supporting SMEs to inform the future priorities for applied research PMTC:
Irish PharmaChem | Industry Buyers Guide 2023 52
Delivering for Ireland’s Pharmaceutical Industry
Established in 1974, Micro-Bio Ireland Ltd has been serving the needs of Ireland’s biopharma, pharma, dairy, food, water treatment, electronics, and brewing industries for more than 45 years from its base in Fermoy, Co. Cork.



Micro-Bio is Ireland’s Only Manufacturer of GMP, high purity, multi-compendial:
• Sodium Hydroxide
• Hydrochloric Acid
• Sodium Hypochlorite
• Brine Solutions
Micro-Bio employs close to 30 people directly and a further 30 people indirectly. Apart from local employment, Micro-Bio is very much an active part of the community, sponsoring many organisations and events in the local area.
If you would like more information, please contact any of the following:
Peter McNamara, Managing Director
Tom Tobin, Sales Director
Denis O’Brien, Technical Director
Micro-Bio Ireland Ltd.

Industrial Estate, Fermoy, Cork Tel: 025 31388
Email: info@micro-bio.ie
www.micro-bio.com
Ortec opens European HQ in Limerick

Ortec Inc., a leading supplier of custom formulation and manufacturing services to the life sciences industry, has officially opened its European Headquarters, Manufacturing and Operations Centre in Newcastle West, Co. Limerick.


The 26,000 square feet building is a dedicated cGMP manufacturing facility. In addition to product synthesis, other facility capabilities include USP/EP generated water, a full-service analytical laboratory, multiple ISO 8/Class 100,000 clean rooms, as well as additional blending rooms. The site is ISO 13485 certified and will operate under FDA/EMA guidelines for production of pharmaceutical, combination, and medical device materials.
Reducing Supply Chain Complexity
With all the issues around supply chain security, this new Ortec facility will offer an alternative where the customer can reduce their supply chain complexity by having materials synthesised or blended locally. The same is true when companies are considering looking to outsource non-key chemical manufacturing activities that will free up assets to focus on the core competencies. Ortec has always had a flexible, honest approach to
Are you considering outsourcing your chemical manufacturing?

Want to free up your assets to focus on other projects?
Need a partner who has the quality systems and regulatory knowledge to meet your demands?
Someone who can hit specs, improve efficiencies, and get you quickly to market without going over budget?
Let our over 40 years of experience help you with your outsourcing needs.
Contact: ORTEC INC
working on new opportunities with companies, and with fallow space available along with the current assets, Ortec can move quickly when evaluating if a process fits their competencies and facility.
Ortec has specific expertise in partnering with customers to move projects from lab scale to pilot to full commercialisation with great efficiency, no surprises and confidentiality you can trust. From initial research to final finished product, Ortec can meet your needs for a variety of materials.
Founded in 1980, Ortec is a custom materials research and manufacturing company that helps clients reach their market goals through technical expertise, quality systems, regulatory compliance, confidentiality and personalised service. The company serves customers from multiple life science markets including pharmaceuticals, biopharmaceuticals and medical devices. Ortec currently has three facilities in upstate South Carolina, and the new Irish facility is the first investment that Ortec has made outside of the USA.
For more information, visit www.ortecinc.com or email John Geraghty, Business Development Manager, on jgeraghty@ortecinc.com.
Custom Formulation/ m anu FaC turing s er vi C es
Irish PharmaChem | Industry Buyers Guide 2023 54
Above: Ortec’s new European Headquarters, Manufacturing and Operations Centre in Newcastle West, Co. Limerick. Below: Ortec has expertise in partnering with customers to move projects from lab scale to pilot to full commercialisation.
Ortec Inc is your privately owned partner for GMP chemical development and manufacturing.
Business
Manager Tel: +353 87 7752914 Email: jgeraghty@ortecinc.com Web: www.ortecinc.com
John Geraghty,
Development
VLE at the fore of Advanced Therapeutics

VLE Therapeutics Ltd is a start-up GMP Clinical Manufacturing company based in Cherrywood, Co. Dublin. It was launched in June 2021, spun out of APC Ltd, the award-winning process development business. We have extended the value chain and so established a global centre of excellence across process development, digital and GMP manufacturing, thereby enabling clients to get their critical medicines to their clinical trials. Our mission is to deliver Science-first GMP Operations, and so be lifecycle partners for our clients, thus accelerating the development, manufacture & supply of their critical therapies to patients.
Advanced Therapeutics – the Cutting Edge of Science
Over the last five years, there has been a steady rise in the number of approvals in the broad category of Advanced Therapeutics and next generation vaccines, a category of innovative medicines that includes Cell-based and Genebased therapies (CGT).
Technologies such as CAR-T will be able to provide a route to the permanent cure of diseases such as cancer – this is incredibly exciting. It is widely predicted that these will be the next big wave of biopharma growth, with analysts now predicting that CGT revenues will reach up to $60 billion globally by 2027.
The sector in Ireland has evolved from the chemical synthesis of APIs, through final dosage forms, to biotech manufacture and now right into the exciting new world of Advanced Therapeutics. As a country, we have made very small steps in this area to date and we are way behind other countries already (UK, US, Israel, Belgium, Netherlands, Nordics). Advanced Therapeutics

AdvA nced Ther A peu T ics
VLE Therapeutics went from concept to reality in just seven months, explains Paul McCabe, COO, who argues that Ireland needs to move fast if we want to be leaders in the growing area of Advanced Therapeutics.
Irish PharmaChem | Industry Buyers Guide 2023 55
represent a significant opportunity for the Irish biopharma sector to evolve and create a sustainable future.
Ireland’s Indigenous Biopharma Sector
The biopharma sector in Ireland continues to grow; it now contributes more than €100 billion in exports and accounts for ~67% of Ireland’s GDP. As Chair of BPCI, it is clear to me that the sector globally is evolving rapidly and that a key objective of our sectoral strategy is the need to create a broader and deeper ecosystem in Ireland. Building out the indigenous biopharma SME sector is a critical element of this sectoral evolution; companies like APC Ltd and VLE Therapeutics Ltd are taking on the challenge of leading this charge and hopefully more will follow.
The evolution of Advanced Therapeutics also can be part of the sectoral development. The scale of their operations is significantly smaller than that of the traditional pharma manufacturing. As such, their scale aligns incredibly well to the SME biopharma sector, and VLE Therapeutics have ambitions to play a significant global role in this space.
VLE Therapeutics – The Launch
VLE Therapeutics was launched in June 2021 and the importance was underlined where An Taoiseach Micheál Martin TD was in attendance, with Dr Mark Barrett (Group CEO), Prof. Brian Glennon (CTO) and Paul McCabe (COO) to demonstrate the significant contribution VLE Therapeutics can make to the sector.


Another key element of our launch was the support of Enterprise Ireland, who have been strong supporters and advocates for VLE Therapeutics right from the start-up concept stage, at mobilisation and through to operational readiness. Leo Clancy (CEO, Enterprise Ireland) was also in attendance for the company launch and the EI team have supported our startup financially with a grant under Ireland’s EU Structural & Investment Fund programmes.
VLE Therapeutics – Project Design, Challenges & Innovative Delivery
A key aspect of our challenge and innovative delivery was to build a GMP Clinical Manufacturing facility on the third floor of an office building, which was already almost fully occupied by APC Ltd’s business, meaning that the requirements of a GMP facility could not be delivered in the normal method (such as super and sub structures), so innovation was needed. Following a facility design and EPCM process, the team brainstormed how to implement innovative processes to deliver our facility. The solutions included:
• The team created a scaled GMP box to enable full GMP manufacturing capabilities within the floor to ceiling slab structure;
• A technical void was created around the GMP box to support wrapping the GMP facility & utility systems around the facility at appropriate points;
• Space was created on the roof of the building and utility connections were made down through the upper floors down to the GMP box space
Also, the ability to construct a GMP facility during a global Covid pandemic, to manoeuvre the EPCM requirements of a GMP cleanroom build, to deal with material supply chain and influencing suppliers to deliver to scheduled lead times needed skill and tenacity.
Our strategy focused our EPCM approach on Irish SME suppliers, with the objective of working with these local providers to achieve our project delivery requirements. As a result of these challenges, it also meant that the VLE and project teams would require a lot of innovation, sense of urgency, focus and grit.
From Concept to Reality in Seven Months
Following a facility innovation brainstorm process, the team commenced construction and went from facility concept to reality in approximately seven months.
• Construction commenced in late September 2021 and the facility was opened in early April 2022.
• Zero injuries/incidents occurred during the project, ensuring best in class safety.
• There were many schedule challenges, primarily related to equipment or system deliver y. By immediate intervention, including travel to national and international vendors during Covid, we managed to achieve our project schedule.
• The project was also delivered with best-inclass budget cost controls, this despite the impact of global supply chain and inflationar y issues in the construction sector.
• At the same time, we hired a talented team of over 30 professionals from the multinational GMP biopharma companies in Ireland.
• We implemented a suite of GMP and business processes to support our operations. We have also implemented multiple digital solutions across our GMP operations (CMMS, QMS, LMS and ERP) and integrated to our proprietary iACHIEVE knowledge management system.
• We have also implemented a full set of GMP connected services, including: iTRANSFER, supply chain, quality & regulatory services, and GMP QC services, to ensure clients get the full end-to-end experience they need in getting their medicines to patients
The chance to create something new, to create future opportunities for people and to create a potential for an Irish business to be a global player in Advanced Therapeutics is incredible. At VLE Therapeutics, we have so much potential ahead for ‘The Medicine Accelerator’ and as such an opportunity to accelerate the development, manufacturing and launch of critical medicines to patients, what a compelling purpose that our team get to work for every day.
AdvA nced Ther A peu T ics
Pictured are (l-r): Deirdre Glenn, Commercialisation Director, Enterprise Ireland; Dr Mark Barrett, Co-founder and CEO, APC & VLE Therapeutics; Professor Brian Glennon, Cofounder and CTO, APC & VLE Therapeutics; then Taoiseach Micheál Martin TD; Kathryn Price, Finance Director, APC & VLE Therapeutics; and Leo Clancy, CEO, Enterprise Ireland.
VLE Therapeutics’ GMP Clinical Manufacturing facility opened in April 2022. Pictured at the opening are Dr Mark Barrett, Group CEO (fourth from left); Professor Brian Glennon, CTO, VLE Therapeutics; Garrett Murray, Head of Life Sciences, Enterprise Ireland; and Paul McCabe, COO, VLE Therapeutics (right).
Irish PharmaChem | Industry Buyers Guide 2023 56

Lilly Expanding in Limerick
Eli Lilly is expanding in Ireland, with a brand new manufacturing facility in Limerick. When the announcement was made in January 2022, the cost of the new facility was estimated to be more than €400 million, but more recent reports in the national newspapers suggest that the investment could end up being up to three times that amount.

The new facility will expand Lilly’s manufacturing network for biologic active ingredients, support increased demand for existing Lilly products and play a key role in bringing Lilly’s robust clinical pipeline, including its promising Alzheimer’s portfolio, to patients around the world.
The proposed project is expected to create more than 300 new jobs for highly skilled workers, such as engineers, scientists and operations personnel, who will use the latest biologics manufacturing technology to produce life-changing treatments that patients need to address health challenges. In addition, an estimated 500 additional positions will be required while the facility is under construction.
Real Hub for Biopharma
Speaking back in January at the official announcement, Tánaiste and Minister for
Enterprise Trade & Employment, Leo Varadkar TD described the investment as fantastic news for Limerick and indeed the entire region: “The Mid-West has become a real hub for leading biopharma companies such as Lilly and I’m really pleased that the company has chosen Limerick for its new manufacturing centre, investing over €400 million and creating 300 new, permanent jobs and a further 500 jobs during construction.
“Lilly produces crucial healthcare products which are making a huge difference to the lives of patients around the world, fighting some of the world’s most serious illnesses,” he continued. “This new manufacturing centre is a significant expansion of that work and I wish the entire team the very best with the project.”
Supportive Government Policies
Senior Vice President and President, Lilly Manufacturing Operations, Edgardo Hernandez, said: “Over the past 40 years, we have continued to invest in Ireland in part
because of supportive government policies that value life science innovation. This new Lilly campus in Limerick will allow us to expand our capacity to make innovative new medicines that can help treat some of the world’s most serious illnesses. This facility will use the latest technology to support advancements in science, productivity and sustainability, further establishing Lilly as a global manufacturing leader.”
IDA Ireland CEO Martin Shanahan described the scale of the investment as very welcome news for the entire country. “Lilly employs more than 2,300 people in Cork and the decision to significantly expand its footprint into the Mid-West region with the proposed construction of a new biopharmaceutical manufacturing facility on a greenfield site in Limerick demonstrates the confidence Lilly has in Ireland and the region’s strong talent pool. The regional economy will also substantially benefit from the approx. 500 jobs in the construction of this proposed facility.” He assured Lilly of IDA Ireland’s continued support.
Eli l illy Irish PharmaChem | Industry Buyers Guide 2023
58
Eli Lilly is creating a new facility for biologic active ingredients in Limerick, which will support increased demand for existing products and play a key role in bringing new therapies to patients worldwide.


























Ground Breaking Science. Life Changing Medicine. Find your place at Lilly careers.lilly.com Manufacturing Campus Kinsale Global Business Solutions Centre Little Island Copyright © 2022 Eli Lilly and Company. All rights reserved.
Merck Investing €440 Million in Cork Sites
Merck is expanding its membrane and filtration manufacturing capabilities in Ireland. The company will invest approximately €440 million to increase membrane manufacturing capacity in Carrigtwohill and to build a new manufacturing facility at Blarney Business Park, both in Cork, Ireland. The investment, which is the largest in a single site ever for the life science business, will create more than 370 permanent jobs by the end of 2027.
Matthias Heinzel, Member of the Executive Board of Merck, and CEO, Life Science, stressed that Ireland is central to the company’s strategy to drive long-term growth and expand its global leadership position in life science: “The investment in Cork is the biggest site investment in the history of our Life Science business and will accelerate the delivery of the critical products, technologies and services our customers need to fight the world’s toughest health challenges, including Covid-19.”
Strong Commitment to Ireland
Speaking at the site’s official announcement, An Taoiseach Micheál Martin TD said it underlines the company’s commitment to doing business in Ireland: “This investment, the largest in the history of Merck Life Science, speaks volumes about our capacity to provide the right conditions for multinational organisations to grow their operations. Ireland’s development of a strong life sciences ecosystem has been one of our greatest economic successes. I am delighted that Merck has chosen Cork for its latest investment. I wish the team continued success, as they work towards improving lives around the world.”
Martin McAuliffe, Managing Director and Head of Cork Operations at Merck, said that the announcement was both “a testament to
the capability, hard work and dedication of all our colleagues here in Cork” and “a statement of Merck’s commitment to our Irish operations. These new investments secure a bright future for Merck in Cork and enable us to expand our capabilities here, generating new employment opportunities in future technology.”
IDA Ireland CEO Martin Shanahan noted that the developments in Carrigtwohill and Blarney will have a significant positive economic impact on the South West region, both during the initial construction period and also with the number of full-time roles that will be created as a result of the expansion. “Merck’s decision to increase its footprint is tangible evidence of the company’s confidence in Ireland’s ability to provide access to world-class talent,” he said. “I want to assure the team at Merck of IDA Ireland’s continued support and wish them every success with this major investment.”
The New Facilities
Merck’s new filtration manufacturing facility at Blarney Business Park will cost almost €150 million. Once fully operational, it will increase the company’s global manufacturing capacity and supply customers, producing both traditional and novel treatments and therapeutics.

With the more than €290 million expansion in Carrigtwohill, Merck is adding a manufacturing facility for the immersion casting of membranes. These membranes support novel and gene therapies, as well as applications like virus sterilisation.
The announcement follows a €36 million investment at the same site in 2021 for a second
lateral flow membrane manufacturing product line. Now formally open, this facility produces lateral flow membranes, most commonly used in rapid diagnostic testing for rare diseases such as dengue fever, malaria and Ebola. They are also a key component in rapid antigen tests, which are used for the detection of Covid 19.
The membranes also serve the Process Solutions business, which is one of the “Big 3” growth drivers for Merck and markets products and services for the entire pharmaceutical manufacturing value chain. Merck aims to increase its Group sales to approximately €25 billion by 2025. To achieve its growth targets, the company plans to increase its total investments between 2021 and 2025 significantly, compared with the period from 2016 to 2020.
Significant Worldwide Investments
Merck’s Life Science business sector is continuing to invest in products and technologies across its portfolio that are key to manufacturing novel therapies and vaccines, including single-use solutions, high-potency active pharmaceutical ingredients (HP-APIs) and novel modalities, such as antibody-drug conjugates (ADCs) and viral and gene therapies (VGTs).
Over the next five years, Merck will implement investment programmes worldwide. Target countries include Germany, China, France, Switzerland, Ireland and the USA. All expansion projects include clear targets for water consumption, waste management, and energy efficiency to support Merck in meeting its goal to be climate neutral by 2040, in line with its sustainability strategy.
Merck
Merck is investing €440 million in two Cork sites, a key part of the company’s worldwide investment strategy in next gen. medicine development.
Irish PharmaChem | Industry Buyers Guide 2023 60
Merck is investing more than €290 million to expand its plant in Carrigtwohill.
At MSD, we actively foster a culture of collaboration, diversity and inclusion. Together, we use the power of leading-edge science to save and improve lives around the world. For more than a century, we’ve been at the forefront of research that advances the prevention and treatment of diseases in people and animals. Visit MSD.ie to see what we’re all about. We’re all in. Copyright © 2022 Merck & Co., Inc., Rahway, NJ, USA and its affiliates. All rights reserved. HQ-NON-01000 7/22
In 2022, Eurofins BioPharma Product Testing (BPT) Laboratories in Dungarvan again increased capacity for ATMP, reaching 3,300 square metres of dedicated labs with the latest analytical technologies.

As client internal priorities shifted to support the acceleration of Covid-19 therapies to market, their laboratories flexed and rose to meet the urgent demands for raw material, intermediates and finished product analyses. With the challenges of new and prioritised product types
State-of-the-art Analytical Technology from Eurofins BPT
Eurofins BioPharma Product Testing Ireland offers unique and unparalleled breadth of service and experience for Biologics, RNA based drugs and highly potent products.

where time means lives and not just money, comes a renewed focus on delivering the most appropriate technological solutions.
Biologics including Cell & Gene Therapy
Eurofins-BPT Ireland boasts a state-of-the-art 1,445 square metres, purpose-built biosafety level-2 (BSL-2) molecular and cell biology suite and biologics. Their laboratories are fully certified by the Environmental Protection Agency (EPA) to handle genetically modified microorganisms (GMMs) & organisms (GMOs).
Their BSL-2 laboratories are designed to accommodate, and segregate, cell storage, cell culture, dedicated viral handling lab (virus infected cells) cell based assays, binding assays (e.g. ELISA) and molecular techniques (e.g. ddPCR). The suite also includes self-contained PCR reagent preparation and dedicated extraction labs. Eurofins BPT works closely with clients to optimise method success rates for feasibility, transfer and validation. Method development support is also available. All work is performed under strict adherence to cGMP, EP/USP and ICH guidelines.
Increasing Number of Gene Therapy Programmes
The teams at Eurofins BPT Ireland have a gene therapy programme, in which they have established analytical strategies, across all levels of development and in line with regulatory requirements. Their bespoke, purpose-built GMP BSL2 laboratories have supported this
advancement in Gene Therapies:
• Viral Vector (AAV, Adenovirus, Lentivirus);
• Nanoparticle Vector;
• Plasmid Based;
• Viral Vaccines/ Oncolytic Viral Therapies.
Quality Control: a New Glycoprofiling Platform
In protein-based biologics drugs, glycosylation is considered as a Critical Quality Attribute (CQA) for its direct impact on the safety and efficacy of the drug.
Eurofins BPT Ireland now has the capability and capacity of executing glycoprofiling using kitbased 2-AB labelling to assist clients through all the steps of their development and manufacturing process, from analytical method development to analytical methods validation and from screening and confirmatory testing to routine quality control needs related to glycoprofiling. The laboratory has established a platform development and qualification (HILIC-UPLC) approach for this technique that would significantly reduce the overall project timelines and hence cater to the fast-paced demand in the current market.
Quality Control: Bioassays Need Expertise
Due to complexity of bioassay methods, experience is essential for understanding and gap-assessing any methods presented to transfer/ validation. The team at Dungarvan is headed by experienced scientists (with an average of 15 years technical experience) whose role is to ensure successful transfer of methods for routine QC testing.
Laboratory t esting
Irish PharmaChem | Industry Buyers Guide 2023 62
The teams at Eurofins BPT Ireland have a gene therapy programme, in which they have established analytical strategies, across all levels of development and in line with regulatory requirements.
All studies are conducted in accordance with industry best practice and relevant guidelines such as USP <1032> and the new draft ICHQ2R2/ ICHQ14.
In conjunction with client support, this experience is critical troubleshooting of QC assays pre- and post-transfer.
Examples of potency testing assays performed:
• Cytotoxicity Assays/ADCC /CDC;
• Proliferation assays;
• Neutralisation assays;
• Reporter gene assays;
• Infectivity assays.
RNA-based drugs
Many vaccines that are currently authorised, or undergoing large-scale clinical trials in Europe, come from recently licensed technologies (recombinant protein vaccines and vectored vaccines), or completely new technology (mRNA vaccines).

mRNA vaccines have their own unique analytical requirements, distinct from traditional vaccines and biologics. However, at Eurofins BPT, supporting RNA-based drug development candidates is not a new activity and a lot of analytical methods are already routinely done, such as purity by LC/ MS, identity by Reverse Transcription (RT) Sanger Sequencing, Total RNA by Spectroscopy, Endotoxin testing, potency by Cell Based ELISA, residuals as plasmid DNA by PCR, etc.
Highly Potent Drugs
The strict high-containment of HP-API and drug product during development and testing presents great challenges and requires significant investments at the laboratory level. Specialised approaches in facility design, equipment selection and laboratory processes to achieve desired levels of containment, minimise operator exposure, and ensure worker protection and safety are needed. Additionally, personnel training is crucial for implementing safe practices. The knowledge gained through experience is invaluable.
Eurofins BPT Ireland has been conducting analyses under CAT 4 containment since 2022, and will establish CAT 5 containment in 2023, to meet both the requirements of HPAPIs and ADCs (Antibody Drug Conjugates).
Due to their composition, ADCs are more complex to analyse than single biologicals as they require testing for the mAb (monoclonal antibody), linker, payload, ADC drug substance (DS) and the finished drug product (DP) with levels of containment. Combined with their high molecular weights, ADC structural analysis represents a major challenge for analytical scientists.
Global is Local
Eurofins BPT is very well placed to assist the diverse pharma and biopharma operations in Ireland and beyond, irrespective of the stage of product development. Their access to world leading centres of excellence within the Eurofins
Eurofins BPT clients can access world-leading centres of excellence within the Eurofins BPT network for specialist or niche services.
BPT network for specialist or niche services, such as assay development, structural characterisation, process and product impurity profiling and GMP nuclear magnetic resonance, has resulted in increased efficiency, product safety and ultimately profitability for their partners.
Eurofins BPT’s local presence ensures personal service, backed by the unique global breadth of harmonised capabilities that support all functional areas of bio/pharmaceutical drug development and manufacturing. With a global network of 40 facilities located in 20 countries, their network of GMP laboratories and vast experience allow them to support projects of any size from conception to market.
Comprehensive Services
Eurofins BPT offers the flexibility to manage testing programmes more efficiently through three service models:
1. Fee -for-service;
2. Dedicated teams at Eurofins site (Full Time Equivalent - FTE);
3. Dedicated Eurofins teams at clients’ site (PSS Insourcing Solutions®).
Their clients can choose the best, most costeffective service solution for their project goals and transition as their need grows. Their breadth
of services includes:
• Method establishment, including method development, feasibility, optimisation, cGMP qualification and validation, as well as verification of compendial methods;
• Comprehensive stability and release programmes for clinical and marketed products;
• Complete biochemical & chemical characterisation and microbial identification;
• Raw material and excipient testing (USP/ NF, EP, JP, CP);
• Packaging testing;
• Lot release/unprocessed bulk testing;
• Full microbiology testing services, including sterility testing;

• Process/facilities validation, including residual impurities testing, extractables & leachables, water testing, environmental monitoring, disinfectant efficacy and on-site sample collection.
“Eurofins BPT Ireland has the physical and technical capacity to be the partner of choice for our clients’ most critical projects,” reveals Deirdre Falconer, Senior Manager Business Development, Ireland. “We look forward to delivering best in class service. When the world awaits your product, choose the laboratory that provides complete capabilities and rigorous quality systems you can trust.”
For more information, email: EurofinsBPT-IE@eurofins.ie.
Laboratory t esting
Eurofins BPT is very well placed to assist the diverse pharma and biopharma operations in Ireland and beyond.
Irish PharmaChem | Industry Buyers Guide 2023 63
SK pharmteco’s Expansion Continues
The Dublin-based pharma plant of SK biotek Ireland, an SK pharmteco company, celebrates five years operating as a CDMO this year. Its Swords Campus is an integrated facility combining manufacturing plants, R&D and QC laboratories within the same footprint. In this five-year subset of the campus’ almost 60-year history, it has grown significantly, and there seems to be no stopping it; a $65 million expansion is underway.
This new project provides significant increase in manufacturing capacity and capabilities for its global customer base. It includes a new manufacturing building, an increase of 24m3 reactor volume capacity, along with filtration/ drying equipment, additional manufacturing lines, and associated utilities. The new building will occupy a decommissioned building on-site, within close proximity to the other site facilities. The expansion will result in a 50% increase in capacity, bringing overall site capacity to 150m3
The new building will come on-line during 2024, when Swords Campus celebrates 60 years as a small molecule API manufacturer, making
From standalone Analytical Services to Cell & Gene Therapy, SK pharmteco is growing from strength to strength.

some of the world’s leading therapeutics for oncology to cardiology patients.
In 2020, Swords Campus completed a $30 million capacity expansion, which included additional isolation and drying equipment, solids handling equipment and associated utilities to meet growing demand.
“As we continue to innovate in our core technologies, our entrepreneurial spirit guides us to look for new services and capabilities to enhance our offering to our customers,” explains Joyce Fitzharris, President of SK biotek Ireland. “With substantial growth in our business base, this expansion supports SK biotek Ireland’s position as a key contributor to SKPT’s EU and worldwide business.”
Proven Track Record
Through the implementation of strong safety policies and compliance with the high-quality
and safety standards required of the industry, SK has a proven track record as a reliable supplier of HPAPIs to multiple customers. For the last 30+ years, the Swords Campus has maintained its leadership in the development, scale-up and commercial manufacture of highly potent chemical intermediates and APIs. Today, it offers multi-scale plants (from grams to hundreds of kilogrammes) capable of handling materials with Occupational Exposure Limit (OEL) ≤10ng/m³.
In addition, SK is strengthening the role of the Swords Campus as a Centre of Excellence for particle engineering, small scale spray drying, and micronisation, with an additional $10 million investment in equipment.
Analytical Services
Launched in 2022, SK biotek Ireland Analytical Services offers a broad range of innovative

SK biote K
64 Irish PharmaChem | Industry Buyers Guide 2023
SK biotek is celebrating five years operating as a CDMO this year.














Linker Antibody Payload
technology that supports both method development and product release. Although SKPT believes that its customers are best served by combining their analytical needs with SK’s ability to develop and manufacture their products, they understand that this may not always be the preferred option.
“Our model is flexible to allow customers access to our leading analytical capabilities without a wider commitment,” explains Dr Matthew Webberley, Associate Director, AR&D, SK biotek Ireland. “With our talented team of analytical scientists and the latest cutting edge equipment, including XRD, NMR, QTof, and GCMS, it makes perfect sense to have Analytical Services in the heart of Europe to complement SK pharmteco’s US footprint with sister company AMPAC Analytical, and gives our customers a global solution.”
SK’s Global Expansion
And it’s not just SK’s Ireland site that is expanding. AMPAC opened a Center for Complex Chemistry and Engineering at their California site. SK’s Sejong site launched its Center of Excellence for continuous catalytic reactions and associated flow chemistry,
with the capability to develop and optimise catalysts. Investment in this plant has almost doubled its capacity, with an additional 100m3 capacity set to come online in late 2023.
SK entered the Cell and Gene Therapy market in 2021 with the addition of Yposkesi, a one-stop-shop for viral vector development and manufacturing for gene therapy, offering a full range of services for Lentiviral (LV) and Adeno-Associated Virus (AAV) vectors manufacturing for bulk drug substances (up to 1,000 litres) as well as final fill and finish for drug product. Investing in bioprocessing innovation to deliver high-quality genemodified cell therapies and in vivo gene therapy projects has been the focus of recent expansion efforts.

“We are investing in large scale capacity and implementing best practice industrial operations, standards, and quality systems,” reveals Brian Mullan, Yposkesi’s CTO. “Our site outside Paris is the largest Cell and Gene Therapy CDMO in Europe. We are currently investing in a second 5,000m2 (50,000 square feet) bioproduction facility designed for EMA and FDA compliance.”
The expansion is to be fully operational for commercial production in 2023.
Solving Customer Problems
SK see Cell & Gene Therapy as a high growth area, and their commitment to this sector is further demonstrated by their investment in the Center for Breakthrough Medicines (CBM), a US-based single-site advanced therapies facility offering process development, analytical testing, plasmid DNA manufacturing as well as viral vector and cell therapy manufacturing. CBM is now part of the SK pharmteco family, with the integrated capabilities of CBM and Yposkesi providing customers with an endto-end offering through a simplified customer interface.
“Ultimately, whether it is small molecule or large molecule or something in between, it is about solving customer problems,” concludes Steve Barr, SKPT’s VP Business Development. “We live by the motto ‘Safety First, Quality Always’ and are extremely proud of our compliance track record. All our facilities have been successfully audited by regulatory authorities worldwide. We strive to be a trusted and reliable partner for our customers and we are dedicated to continuous improvement. This, coupled with our performance, operational excellence culture, and ability to solve problems is what makes SK pharmteco successful and the go-to choice for customers.”
66 Irish PharmaChem | Industry Buyers Guide 2023
biote
Through the implementation of strong safety policies and compliance with the high-quality and safety standards required of the industry, SK has a proven track record as a reliable supplier of HPAPIs to multiple customers.
SK
K
WE ARE RENEWABLE HEAT & POWER SPECIALISTS. WE BRING THE FUTURE,TODAY.
DECARBONISATION PARTNERS FOR PHARMACEUTICAL MANUFACTURING

DELIVERING ENERGY COST SAVINGS AND REDUCING CARBON EMISSIONS FOR OUR PHARMACEUTICAL INDUSTRY PARTNERS ACROSS THE ISLAND OF IRELAND
FULL TURNKEY DECARBONISATION SOLUTIONS INCLUDING INDUSTRIAL HEAT PUMPS AND SOLAR:

• Industrial heat pumps up to 200°C, which can reduce carbon emissions by over 70% with paybacks of 2-3 years when utilising the grant supports available.
• Astatine is installing Ireland’s first heat pump over 100°C in Ireland.
• Solar PV can reduce electricity costs by over 50%.
• Full management of grant process to minimise project paybacks.
CONTACT
WHAT ARE THE IMMEDIATE BENEFITS OF DEPLOYING A HEAT PUMP?
• Up to 100% reduction in onsite fossil fuel usage.
• The processing of heat of up to 200°C.
• Dramatic decrease in on-site CO2 emissions by over 70%.
• Projects can be delivered with no upfront costs.
• Deployment projects are delivered in tandem with existing system.
Get in touch with Astatine today to see how we can help you to cut energy costs, achieve energy independence and reduce your CO2 emissions info@astatine.ie
www.astatine.ie
€
Actylis: the New Name for A&C Biobuffer Ireland
As of September 2022, Limerick-based A&C Bio Buffer has been fully integrated into and has become a key part of the newly formed Actylis, a leading global manufacturer and sourcing expert of critical raw materials and performance ingredients for the life sciences market.
Actylis combines A&C Bio Buffer and 10 other industry specialists into an integrated global ingredient powerhouse, which includes PI & API manufacturing facilities in North America and excipient and critical raw materiel plants in Europe, North America & Asia. Actylis (“Actill-iss”) is the culmination of an ambitious initiative launched several years ago to address the major un-met need for better and more dependable access to critical raw materials and performance ingredients essential for the manufacture of highly regulated products in key industries.
Manufacturing & Sourcing of Raw Materials Sourcing of Raw Materials
Actylis offers a unique hybrid of manufacturing and sourcing of critical raw materials, which provides key benefits to its customers in the pharmaceutical and biopharmaceutical industries.
Their key products include:
• Excipients;
• APIs and PIs;
• Process and cleaning solutions;
• Buffers;
• Cell culture ingredients;
• Amino acids;
• Critical raw materials.
Global operations include R&D facilities, GMP manufacturing, sourcing hubs, GMP warehousing and sales offices across 10 countries, including Ireland. Their GMP manufacturing facilities, renowned for high-quality standards, hold all the major certifications and applicable licenses from
the main accreditation bodies and agencies, including ISO 9001:2015 and EXCiPACT (GMP and GDP), and are Drug Establishment Licensed for the manufacture of APIs.

The unique offering of both manufactured and sourced materials provides unparalleled choice for customers’ supply chains. Actylis offers over 4,000 critical raw materials to customers globally, with full supply chain transparency and supporting regulatory and quality documentation.
Understanding Customers’ Needs
Actylis’ deep understanding of its customers’ needs, industry regulations and market requirements enables them to manufacture or source materials with a strong record for ontime/in-full deliveries.
Their key services include:
• GMP manufacturing;
• Contract R&D and scale-up;
• Custom manufacturing;
• Custom ingredient development;
• GMP custom packaging & down-packing;
• Analytical services;
• Sourcing and distribution;
• Regulatory support.
Actylis Ireland specialises in all of the above services for downstream liquid and buffer manufacturing and is poised. to meet customer demand either by manufacturing critical starting materials or sourcing them through its extensive global network. All products are backed by world-class quality, regulatory expertise, and transparency for confidence in the finished drug product.
For more information, visit www.actylis.com or email biopharma@actylis.com.

Actylis
R Pharma Supplier of the Year Irish PharmaChem | Industry Buyers Guide 2023 68
Limerick based A&C Bio Buffer is a key part of the newly formed Actylis, a global ingredient powerhouse.
WINNE
Our Hybrid model delivers more choice and flexibility
Hybrid of Global Manufacturing & Sourcing

Think packaging; think
Tekpak Automation can fulfil every secondary and tertiary packaging requirement for a wide range of pharmaceutical, biomedical, medical device, biotechnology, and cosmeceutical products within the life sciences industry. The company is focused on the design, development, and manufacture of endof-line packaging systems for manufacturers of retail packaged goods and pharmaceuticals.
With a core expertise in high-speed robotic pick-and-place applications for flexible or difficult to handle products, Tekpak provides production and cleanroom ready machines within a compact footprint. The modular packaging systems are capable of handling multiple products from several infeed conveyors and loading into variable secondary package configurations. With quick product changeover and no tooling required, machine downtimes are minimised.
Typical products handled include:
• Blister Sheets and Thermoformed Packs;
• Glass Vials, Dropper Bottles and Ampoules;
• Auto Injector and Pre-Filled Syringes;
• MDI Canisters;
• Jars, Tubes and Tubs;
• Sachets, Flow Packs and Strip Packs;
• Medical Devices;
• Rubber and Plastic Bulk Part Handling.
Customised Packaging Lines
Tekpak provides completely customised packaging lines for clients wanting to increase packaging line efficiency, reduce labour overheads, improve compliance with quality standards, or launch a new product range. A typical pay-back on a Tekpak robotic system is less than two years, with the benefits of automation far surpassing the direct cost savings. By automating the end-of-line packaging, clients can meet increasing product demand in a flexible and consistent way. This includes the ability to accurately record and project production volumes, based on real-time data from the robot
Tekpak Automation designs, develops and manufactures end-ofline packaging systems for pharmaceutical manufacturers, with a core expertise in high-speed robotic pick-and-place applications.
controller, which can be easily integrated with any production management system.
Life science applications include:
• Vertical and Horizontal Cartoning;
• Loading and Unloading Brite Stock from Trays;
• Stacking, Nesting and Collating;
• Feeding Product to a Flow Wrapper Infeed;
• Labelling (TE, Print and Apply, or Thermal Transfer);
• Batch Data Printing with Camera Verification;
• Carton and Case Erectors/Closers;
• Case Packing and Palletising;
• Machine Linking Conveyors with Signal Exchange;
• Integration of Serialisation and Aggregation Systems;
• 21 CFR Part 11 Ready Machines;

• GAMP 5 Project Management;
• GMP Design Features;
• Full Validation Documentation.
Adaptive and Agile
With over 20 years’ experience, Tekpak is an adaptive and agile company with engineering and innovation at the very core. Through analysing the client’s requirements in detail, identifying the risks,
and developing the best technical solution for the application, machines are produced in short lead times to reduce the time to market.
Operating from a state-of-the-art 40,000 square foot manufacturing and R&D facility in Wexford, Ireland, with 20,000 square feet dedicated to full line assembly and FAT, Tekpak employs over 50 professionals, including an in-house design team, engineering department, machine shop and complete fabrication services.


With clients across Ireland, the UK, Europe, North America, Asia and the Middle East, Tekpak Automation can produce customised packaging machinery for product manufactures at any size or scale. From design concept to installation and commissioning, Tekpak provides the highest level of customer care through knowledgeable project management and quality engineering, backed up with comprehensive after-sales service and support.
For more information contact: Tekpak Automation Ltd., Whitemill Industrial Estate, Wexford, Y35 A620, Ireland Tel: (053) 916 3033 E-mail: info@tekpak.ie Web: www.tekpakautomation.com
Packaging
Irish PharmaChem | Industry Buyers Guide 2023 70
Tekpak: world class packaging machines made in Ireland.







24/7 Technical Support Customised Engineering & Manufacture +353 (0) 53 916 3033 | +44 (0) 113 3505 694 Whitemill Industrial Estate, Wexford, Y35 A620, Ireland www.tekpakautomation.com info@tekpak.ie HIGH-SPEED PICK AND PLACE • TRAY LOADING & UNLOADING • SPECIAL LABELLING • FEEDING • STACKING/NESTING • COLLATING HORIZONTAL AND TOP LOAD CARTONING • CASE PACKING • PALLETISING • CARTON/CASE ERECTING • CARTON/CASE CLOSING SINGLE SOURCE SUPPLIER • TRACK & TRACE INTEGRATION • FULL VALIDATION • 21 CFR PART 11 READY MACHINES • GMP DESIGN End of Line Packaging Automation Primary Product Handling Secondary & Tertiary Packaging Turnkey Full Packaging Line Supply FULL LINE DESIGN, MANUFACTURE AND INTEGRATION Irish Owned and Operated Since 1999
Univar Solutions is bringing innovation to the future of pharmaceutical ingredient distribution.
The past several years have tested the grit of chemical and ingredient distributors like never before. Economic pressures, supply chain disruptions, climate-related shocks, changing regulations and shifting consumer preferences have brought difficult challenges but also great opportunities. To meet the changing needs of the market, Univar Solutions has successfully shifted its focus. In fact, the company has expanded from a traditional chemical distributor to a distributor with a full line card of specialty and foundational ingredients that also delivers a suite of value-added technical, supply chain and sustainability solutions to customers in life sciences markets, from pharmaceuticals, biopharmaceuticals and nutraceuticals to ophthalmic and animal health.
As a leading pharmaceutical ingredient distributor, Univar Solutions is always asking “What’s next?” This means constant assessment, alignment and innovation to provide customers and suppliers access to a world-class product portfolio, the brightest technical minds and operational excellence that help you focus on the bottom line. They’re continuing to invest in value-added services to help suppliers and customers solve their toughest challenges, remain ahead in their markets, and plan for a bright future. Here are six key business drivers which Univar Solutions is focusing on to accelerate its long-term growth within the pharmaceutical space.
Pharmaceutical Market Industry Focus
Univar Solutions’ sales, marketing, product management and technical teams are built with specific expertise and aligned to the pharmaceutical ingredients industry, delivering specialty products in line with market trends and differentiated technical and application development services. “We leverage global scale and local touch, collaborating with customers as they develop their next commercial success,” explains James Peterson, Global Vice President for Pharmaceutical Ingredients at Univar Solutions.
Sustainability
Univar Solutions has ambitious goals to drive positive change within and beyond its operations. “From researching excipients that can do more with less to testing alternatives
The Future for Ingredient Distribution
to recycle solvent waste, we’re your partner that can help find solutions that protect our planet and grow business,” says Peterson.
Technical Acumen
“Through our global network of Pharmaceutical Ingredient Solution Center laboratories staffed by our technical experts, we’ve built an ecosystem of innovation, delivering practical solutions that address the latest drug formulation innovations, regulatory requirements and sustainability challenges,” Peterson notes.
Digitalisation
E-commerce, artificial intelligence and “smart supply chain” are not just buzzwords. “Digital technology is helping transform our business across the board, from formulation testing, product traceability and inventory planning to 24/7 online access to technical documents and ordering,” Peterson explains.

Marketing
With a nimble and dynamic combination of traditional and digital tactics, Univar Solutions
has built the capability to find pharmaceutical customers across their product development cycle, “delivering recommendations for the hero ingredients that meet unique formulation needs while also supplying foundational products with speed,” according to Peterson.
Reliability
“As a full-service distribution partner that leverages a global supply chain at the local level, we have a true advantage,” Peterson insists. “We own the ‘last mile’ of delivery. By seamlessly bringing together our world class portfolio and services businesses, we are redefining pharmaceutical ingredient distribution.”
Distribution may have started out as face-toface customer meetings and moving materials from one location to another. However, it’s evolved to mean many different things to different people. Safely handling, storing and shipping materials are still a must, but bringing value-added and sustainable services and solutions to customers and suppliers is what the future of distribution is all about.
For more information about Univar Solutions, please contact: univarsolutions.com/pharma
Pharmaceutical i ngredients
Irish PharmaChem | Industry Buyers Guide 2023 72
Advancing Innovative Pharmaceutical Ingredient Solutions

Univar Solutions brings you a premier portfolio, distribution and logistics excellence, and advanced technical solutions.

Pharmaceutical manufacturers who are seeking a global specialty pharmaceutical ingredient solutions partner are turning to Univar Solutions for innovation and technical support, plus insights into forthcoming regulations, trends, and market dynamics.
Whether you need high-purity solvents for API synthesis, or APIs, excipients, reactants and intermediates, we have a portfolio of the most specialized and in-demand brands from leading suppliers around the globe. Together with our application, regulatory, and quality experts, we can develop solutions for your manufacturing challenges, improving total costs of operations while supporting your supply chain.

Contact us for customized ingredient and distribution solutions: +353 1 4019800 or Irelandsalesoffice@univarsolutions.com
univarsolutions.com/pharma
A New Generation of Sensors for Liquid Analysis
Endress+Hauser are introducing the next generation of Memosens digital technology for simple, safe and connected liquid analysis.
Memosens technology has revolutionised liquid analysis technology. It converts the measured value to a digital signal and transfers it inductively to the transmitter, offering safe data transfer for increased availability of the measuring point and trouble-free processes.
With Memosens 2.0, the next generation of Memosens digital technology from Endress+Hauser, liquid analysis measuring points now become completely future-proof and ready for IIoT. The new technology is available for pH/ORP, conductivity and
dissolved oxygen sensors. It will be extended to the complete sensor portfolio for liquid analysis.
Unlocking the Potential of Measurement Data
Memosens 2.0 sensors store numerous, relevant data such as operating hours, minimum and maximum temperatures and measured values, calibration histories and load matrices. All this data can be used and processed for comprehensive analysis and more precise process management. The sensors also provide a perfect basis for predictive maintenance strategies with Endress+Hauser’s Heartbeat Technology and enhanced IIoT services via the Netilion ecosystem.
Simplifying Liquid Analysis
Memosens 2.0 combines cutting-edge technology with maximum practicability. Because the Memosens sensors are equipped with highly integrated electronics, they can be calibrated and adjusted under lab conditions that are favourable for the operator and stable for precise results. Replacing sensors in the field is a simple process and can be performed in a timely manner, thanks to the lockable bayonet connector and automatic sensor identification by the transmitter.
Increasing Process Safety
Non-contact digital data transmission eliminates the effects of moisture, corrosion and salt bridges with alert messaging if the signal transmission is disturbed. Galvanic isolation ensures interference-free measurement and EMC safety. The Memobase Plus software provides full traceability of all sensors used, supporting operation according to strict guidelines in regulated industries. Memosens 2.0 offers error-free flexibility for measuring points in hazardous areas, since all Ex-sensors can be connected to all Endress+Hauser transmitters with the respective approval.
Reducing Operating Costs
Replacing sensors on-site is simple and quick; using pre-calibrated sensors reduces process downtime and regular regeneration extends sensor lifetime. Lab calibration reduces stand-by hours of analysis experts.
Sustainable in Every Industry
Memosens sensors are proven in use in all industries, from chemical and food, to life sciences and power, to water and wastewater industries. Memosens 2.0 is backwards-compatible and can easily be integrated into existing systems, taking them to the next step towards a future-proof liquid analysis.
Contact Endress+Hauser today to learn more: https://eh.digital/3wwh6fl.

Liquid An ALysis
Irish PharmaChem | Industry Buyers Guide 2023 74
Memosens sensors can even be connected under water.
We understand how leading-edge products and process improvements are critical in your business.



INNOVATE + ACCELERATE
You are enabled to achieve a faster time to market, improve plant productivity and reduce risk.
Improve your processes with our comprehensive portfolio of measuring instruments, solutions and services:
Calibration Management Service
Calibration Management Service
Liquiline CM44P: Multiparameter transmitter combines all sensors (pH, oxygen, conductivity, cell growth, UV) for optimal process control and product yield.


iTHERM TrustSens TM37x: World’s first self-calibrating compact thermometer reduces the risk of process failures.




Efficient management of field instrumentation’s calibration for documented proof of process quality and reduced operational costs.
Do you want to learn more?
www.ie.endress.com/life-sciences
Supporting Ireland’s Industry to Realise a Circular Economy
Energy supply is under pressure due to skyrocketing gas prices. Production lines and sometimes even entire companies are being shut down. As a waste company, how does Indaver guarantee that its processing plants do not shut down? Continuing to invest in high-tech recycling and processing infrastructure and storage capacity appears to be the answer.
Energy is becoming a precious commodity. Affordable and local energy that is preferably green is increasingly a must-have. Waste plays a fundamental role. By recovering energy and materials from waste streams and reusing them as raw materials, Indaver creates value from waste.
Heat Networks for Industry & Community
With its waste-to-energy facility in Meath, Indaver generates 110GWh electricity and supplies enough clean energy to power the equivalent of 32,000 households every year. In the UK, Indaver is also putting the circular economy into practice. In 2022, Indaver started the construction of an Integrated Waste Management Facility (IWMF) in Rivenhall in the Essex region, to process 595,000 tonnes of non-recyclable household and commercial waste by the end of 2025. The facility will meet the power needs of around 60,000 households.

Discover how European waste management expert Indaver can contribute to a costeffective, CO2-reducing and environmentally friendly waste management.
In Belgium, Indaver invested heavily in the Ecluse steam network and heat network Boortmalt, both situated in the larger port of Antwerp. Here, an industrial pipeline network transports steam and heat from Indaver’s waste-to-energy plants to surrounding industry and 3,000 households, seven schools and several public buildings.

Limit Your Environmental Impact
As an industry leader, you want to limit your environmental impact as much as possible. A reliable partner for your waste management can contribute to this. Thanks to Indaver’s wide range of state-of-the art treatment facilities in Ireland and abroad and its focus on the circular economy, by recovering valuable materials and energy from your waste, Indaver helps you achieve your sustainability goals in close partnership, based on 35 years of know-how and innovation.
Valuable Material Recycling
Indaver invested heavily in the recycling of end-of-life plastics and transforming them into base chemicals again. Through the innovative Inda-MP process, Indaver also recycles precious metal from homogeneous catalyst waste, resulting in substantial economic and ecologic benefits for the pharma industry. Furthermore, Indaver is strengthening its position in the solvent recycling business with its recent acquisition of BIP Chemical Holdings and BIP Environmental Ltd in the Manchester area. The site consists of a solvent recovery unit with a processing capacity and a transfer station for Pharmachem waste.
Indaver’s solvent recycling business has expanded.
For more information, visit www.indaver.ie or call (01) 6972900.
Waste Manage M ent
Irish PharmaChem | Industry Buyers Guide 2023 76
Heat network connecting Indaver’s waste treatment facility with industry and cities.



























LEADING THE FIELD IN SUSTAINABLE WASTE MANAGEMENT The circular economy Together we make it happen It's all about Sustainable Partnership really. Constant Innovation comes with it. Discover how Indaver can contribute to a cost-effective, CO2-reducing and environmentally friendly waste management. Contact us by email: info@indaver.ie or call +353 1 6972900. www.indaver.ie Recycling of precious metals & end-of-life plastics Local and international waste treatment Heat networks for industry & community Solvent recovery
Chemifloc Group provides specialist chemical solutions and technical services for multiple industrial and municipal applications.
Chemical Solutions for Industry
Chemifloc Group is a wholly owned Irish company dedicated to the development and supply of chemical solutions to municipal and industrial facilities. Potable water and wastewater treatment solutions are provided from its Chemifloc and Chemilab operations, and bulk chemical solutions from GI Chemicals DAC.
Chemifloc Group has over 40 years’ experience as a water treatment chemical solutions specialist, and now operates with a staff of 80 personnel across three separate companies, providing a wide range of chemicals and associated technical services to the pharmaceutical and general industry. Key to its growth has been its personnel, whose work ethic, safety culture and commitment to the company have enabled growth and development of new products to serve these sectors today.
Chemifloc Group is fully compliant with all current Health and Safety, Environmental and Quality standards, and to this end, maintains all associated ISO certifications including ISO 9001, ISO 14001, ISO 45001 and an INAB accredited laboratory.
Chemifloc Group has facilities in both Shannon and Foynes Port. Both facilities continue to evolve, with a planned capital programme of projects to ensure the group stays at the leading edge of safety, sustainability and technology.
The Group also values logistics, with continued investment in its modern fleet and skilled ADR driver team. With a dedicated tanker and rigid truck fleet, prompt deliveries to customers are guaranteed.

Chemifloc Ltd
Chemical solutions manufactured by Chemifloc facilitate the delivery of potable drinking water to homes and businesses throughout Ireland, and enable wastewater treatment plants to meet the most stringent environmental standards
in force today. These chemical solutions are fully supported by the technical expertise of the Chemilab team, allowing continuous optimisation of existing processes and the capability to provide support services for future R&D projects.
Chemifloc manufacture and supply a full range of chemical products for potable water and wastewater treatment, including the following applications:
• Coagulation/Flocculation
• Aluminium Sulphate solutions (ALUM)
• Polyaluminium Chloride (PACL)
• Ferric Sulphate
• Ferric Chloride
• Ferric Aluminium Sulphate
• Disinfection
• Sodium Chlorite
• Sodium Hypochlorite solutions
• PH Correction
• Sodium Hydroxide solutions
• Sulphuric Acid Solutions
• Odour and Septicity
• Ferric Nitrate
• Sodium Nitrate
• Calcium Nitrate
A full range of polyelectrolytes and specialist chemical solutions for the treatment of foaming, sludge bulking and nutrient problems are also available, and these solutions can be fully specified and supported by the Chemilab team to ensure they are correctly applied on-site.
Chemilab
Chemilab offers a full range of technical services to support its chemical solutions design, as well as a wide range of specialised testing services for customers through its INAB accredited laboratory.
This includes:
• Ireland’s only dedicated THM (TriHaloMethane) analysis facility;
• Chemical analysis of potable and wastewater streams;
• Biological analysis of potable and wastewater streams;
• Jar testing to select and optimise chemical coagulation programmes;
• HPLC testing to determine detailed chemical compositions;
• R&D project works and design as requested by customers.
GI Chemicals DAC
GI Chemicals supplies industrial bulk chemical solutions in road tanker format. The Industrial Chemical solutions provided comply with all relevant standards applicable to sectors served (including pharma, food and dairy) and include Sodium Hydroxide solutions, Sulphuric Acid solutions, Caustic Potash solutions, and Hydrochloric Acid solutions.
GI Chemicals’ chemical storage facility is in Foynes Port and a highly skilled team operates from this hub to meet and exceed its customer needs. Certified to ISO 9001 standard, their team ensure 100% compliance with Health and Safety, Quality and Logistical requirements for all sectors, including the pharmaceutical sector.
Bespoke Solutions
The Chemifloc Group has the capability to develop and provide bespoke chemical solutions to meet your needs. The combination of their manufacturing capability, industry knowledge and technical expertise allows them to innovate and develop solutions to meet specific customer requirements.
For more information, visit www.chemifloc.ie or email info@chemifloc.ie.
Chemi C al Solution S
Irish PharmaChem | Industry Buyers Guide 2023 78
Chemifloc group
Ireland’s largest indigenous Chemical Solution provider to the Water, Wastewater Treatment and Manufacturing Industries


ISO 9001.2015 and IBEC certified, the Group has operations located in Shannon and Foynes
Supplying to industry the following:
• Flocculent and Coagulant aids for water and waste treatment processes
• Odour and Septicity control chemicals
• Disinfection chemicals

• PH correction chemicals
Contact us at: info@chemifloc.ie


Supplying to industry the following:
• Chemical analysis
• Microbiological analysis
• Jar testing
• HPLC testing of solutions
Contact us at: info@chemilab.ie
Supplying to industry the following:
• Caustic Soda solutions
• Sulphuric Acid solutions
• Hydrochloric Acid solutions
• Caustic Potash solutions
• All bulk formats catered for all industry sectors
Contact us at: info@gichemicals.ie
Chemifloc Group Smithstown Industrial Estate, Shannon, Co. Clare., V14 VY67 Phone: +353-61-708699 Website: www.chemifloc.ie www.gichemicals.ie
Protecting Our Health, Industry and Environment


best in class secure voice communications but also integrated lone worker/man down alarms, GPS location services, fire panel integration, secure text and video in one dedicated device, which is

Hubbcat: the Next Generation of Communication
Two-way radio communications have long been the bulwark upon which successful ERT teams have based their operations and response to emergency situations. However, as pharmaceutical plants and manufacturing facilities have grown in scale, scope and ambition, it is arguable that many previously useful solutions such as two-way radio and paging systems have not advanced in parallel. Many ERT members will be familiar with twoway radio, paging systems, fire panels alerts and lone worker systems. They are critical tools but often operate independently of each other and are based on technology which is largely unchanged for the past 20 years. This is despite high levels of on-site infrastructure investment in data connectivity in terms of Wi-Fi, enhanced mobile/cellular coverage and even private LTE.
Today’s pharmaceutical plants operate more like connected cities than simple factory or production lines. Better team collaboration, process, compliance and duty of care to the workforce have never been more important. Automation is everywhere across the factory floor; machines talk to machines; production is 24 hours, round the clock, with people and goods constantly on the move. For all this to work efficiently, we need to think differently about how we communicate and collaborate, speedily and securely, across our functional teams.
Technological advances in on-site connectivity mean that it is now possible to converge many of the legacy single technologies into one easy-to-use, cost efficient digital device. This greatly enhances communication effectiveness, whilst providing the necessary compliance measures in one package.
Business Critical Solutions
Hubbcat offers a range of cuttingedge Business Critical Solutions to the pharmaceutical sector. Their Push to Talk platform not only includes best in class secure voice communications but also integrated lone worker/man down alarms, GPS location services, fire panel integration, secure text and video and much more. All this comes in one dedicated device, which is ATEX rated for all working environments.
Alarms and emergencies happen. When they do, Hubbcat’s system can track, log and control the situation. Users can trigger an alarm via dedicated assistance buttons on the device or if the sensors on the device sense a drop, fall or inactivity. Alarms can be handled locally on the proprietary dispatch console or handed off to 24-hour dedicated monitoring teams. Colleagues’ location can be determined instantly on a map and the ERT team can react at speed and in a co-ordinated manner to any ongoing event.
Hubbcat’s devices use clever technology to utilise the network coverage of all the mobile phone operators based on signal strength. This is great for operations with large campuses or multiple geographically disperse facilities. They can also connect to local Wi-Fi networks. This is designed to eliminate the coverage blackspots often found using traditional twoway radio systems.
Core Benefits
EHS/ERT teams’ core mission is to provide a safe and productive environment for their colleagues across the workplace. Using Hubbcat can bring the following core benefits:
• Fast, secure and reliable one-to-one and team communications;
• Maximum site coverage and reduced communications blackspots;
• Integrated alarms and fire panels;
• Lone worker protection;
• ATEX cer tified device range;
• Converged services and ease of deployment;
• 30% cost savings over legacy systems;
• Fully encr ypted GDPR compliant communications;
• Unlimited geographic reach and range.
Hubbcat is a trusted partner to a number of leading pharmaceutical companies by providing best in class communications to ERT teams in some of Ireland’s newest and most modern facilities: When communication counts, you can count on Hubbcat.
For more information, visit www.hubbcat.com or email Sales@Hubbcat.com.

ERT Communi C aT ion
Advancing technology allows ERT critical communications equipment from Hubbcat to offer a range of elements
Hubbcat’s Push to Talk platform not only includes
ATEX rated for all working environments.
Irish PharmaChem | Industry Buyers Guide 2023 82
Hubbcat’s digital devices make communication easy across modern pharmaceutical plants.



Modernize Your Emergency Response Communications Email hubbcat.com for more information and a free trail. Effective team communication with Hubbcat • Consolidate systems on to one reliable platform • Eliminate poor coverage areas • Better collaboration between EHS teams • Lone Worker & Fire Panel integration • Improve Audit compliance
Known for its exceptional quality and customer service, Greenfield Global is one of the world’s largest privately held ethanol and specialty chemical companies, servicing customers across the globe. For more than 20 years, under its Pharmco brand, Greenfield Global has provided a wide range of specialty alcohols and biobased chemicals that adhere to the highest quality standards to meet pharmaceutical market requirements for mission critical products.
Operating with a commitment to sustainability and using Good Manufacturing Practices (GMP) for excipients and International Pharmaceutical Excipients Guidelines (IPEC), Greenfield Global’s reputation of quality, service, and flexible packaging solutions is at the core of everything they do.
Greenfield Global meets the needs of laboratories, medical device manufacturers, and both large and small molecule pharmaceutical companies from around the globe. Starting in the lab and ending in full-scale production, they provide high-purity solvents and critical bioprocess solutions through quality agreements with the majority of Fortune 500 pharmaceutical companies.
Cutting Edge cGMP Manufacturing Facility
Opened in 2020, their state-of-the-art 40,900 square feet, cGMP manufacturing facility in Portlaoise is strategically positioned in the heart of Ireland with direct access to Dublin Port. ISO certified and soon to be EXCiPACT certified, the site is equipped with production suites and an on-site Class 8 clean room, and the facility can batch and fill a range of critical solutions, using both USP/EP purified water and WFI (water for injection).
Features of the facility include product dedicated production venues, bulk storage tanks for ethanol and IPA, product dedicated blend tanks and closed loop piping from and to the docks to production tanks, filling lines and to the cleanroom. The site is equipped and validated with USP purified water and Water for Injection (WFI) generation, and an in-house quality control and microbial laboratory.
Materials manufactured and produced for customers across the biopharmaceuticals sector include Ethanol, Sodium Hydroxide, Phosphoric Acid, Citric Acid, and custom blend solutions as required by customers. The pure ethanol is distilled at Greenfield’s manufacturing operations in Canada before it’s shipped in dedicated isotainers to Portlaoise. Greenfield produces some of the lowest carbon intensity ethanol in North America and was the first company in Ireland to complete a Net Zero Emissions Building (NZEB).

Continuous Innovation
In medicine and the life sciences, innovation happens fast, and the stakes are high. Greenfield Global’s chemists and engineers find new ways
Greenfield: Your Partner for Specialty Chemicals
Greenfield Global is a trusted partner for multi-compendial raw materials.
to improve their products and processes, continually adapting and adding capabilities without compromising quality.
Their dedicated experts across quality, production, compliance, shipping, maintenance, logistics, and administration, understand and meet the high expectations of their customers and work closely with their partners every step of the way to ensure testing, quality, and reliable supply in order to successfully deliver mission-critical products. In short, the speed and agility of Greenfield Global’s service extends to their supplychain transparency, service reliability, and responsiveness to customer needs.
As Ireland’s strong global reputation in biopharma manufacturing continues to expand, Greenfield Global continues to be a trusted partner for raw materials throughout the entire value chain.
For more information, visit www.greenfield.com. Tel: (057) 8671400. Email: Portlaoise.info@ greenfield.com.
Greenfield Global meets the needs of laboratories, medical device manufacturers, and both large and small molecule pharmaceutical companies from around the globe.

Irish PharmaChem | Industry Buyers Guide 2023 84 Specialty c hemical S

Are You Prepared for the Impact of the Energy Crisis?

In addition to war, trade barriers and inflation, the recent cost increases and instability of energy is a major challenge facing the pharmaceutical and chemical industry. Not only will this lead to significant additional manufacturing overheads, but it could even result in industry shutdowns. Here at NCC, we are encouraging our customers to not only consider the energy crisis from their own perspective but to also acknowledge the many tiers of chemical manufacturers and distributors that make up their raw material supply chain.
Energy Intensive Industry
The chemical industry uses approximately 10% of all gas imported for manufacturing within the EU. Being so energy intensive, it is at an increased risk of being directly impacted. To mitigate the impact of the crisis or to maintain a level of overall business competitiveness, many chemical companies are reducing production or postponing their manufacturing schedules in 2023 altogether.
While many manufacturers are using innovative strategies to reduce energy consumption in their processes, chemical buyers in the pharmaceutical industry must examine their supplier base. We strongly advise that contingency strategies are put in place to maintain production goals and to avoid plant shutdowns.
Second Sources for Key Materials
EU chemical manufacturers are traditionally considered a very reliable source for raw materials as regards the pharma industry, though not as always keenly priced as some
manufacturers in Asia. For the foreseeable future, however, this is unlikely to be the case. With that in mind, finding second sources for key materials should be a priority.
This can be achieved by examining what raw materials are used in a manufacturing process and avoiding sources that are using high amounts of ‘vulnerable’ materials. For example, ammonia relies on gas as a feedstock to be produced. Previously, ammonia was relatively cheap to manufacture and was readily available across the globe. With spiralling energy costs, ammonia production has been reduced by 70%. This creates huge pressure on manufacturers who rely on ammonia to produce an array of other materials. Chemicals like methanol, melamine and caprolactam are similarly vulnerable to the energy crisis, and are common upstream materials used in the production of a huge collection of fine chemicals
When deciding a second source, geography also plays a key role, mitigating any macroeconomic or political events that could otherwise affect both sources simultaneously. For example, if a potential shutdown was to take place at one of the intensive chemical sites in Germany, the impact would have huge consequences for the EU market in a matter of weeks. We would strongly advise to examine potential raw material suppliers at a global level and ensure secondary sources will
remain viable if your primary source is affected by the energy crisis. Consider who your suppliers purchase raw materials from, and how current events might have an impact on their ability to produce. For key raw materials, consider going as far up the chain as possible, to fully understand how shortages of certain chemicals could have a cascade effect along the supply chain.
Taking Another Look at Green Chemistry
The energy crisis is likely to accelerate cleaner energy sources, and as well as alternative chemicals produced using less energy. With spiralling costs and energy challenges, now might be the time to change to greener chemistry. Greener chemicals are now rapidly becoming more economically viable than their traditional alternatives. What may have previously been seen as non-cost-effective business decision may now be a prudent financial and environmental move, with little impact to overall procurement spend.
NCC is a strategic sourcing partner; we can assist in any of your supply chain challenges, from diversifying your material supply base, to creating a greener raw material footprint. We further help mitigate material risk, with local storage options, as well as having strong partnerships with principal chemical manufacturers globally. For more information, call (01) 6131400 or email hello@ncc.ie.
Pharmaceutical r aw i ngredient s
Irish PharmaChem | Industry Buyers Guide 2023 86
Paul Power, Strategic Sourcing & Supply Chain Executive, NCC, discusses the impact of the energy crisis and how it may affect the pharmaceutical industry.
A sourcing partner you can rely on
In times of uncertainty, you need a pharmaceutical sourcing partner that not only has the know-how and in-house capability but will always go the extra mile. NCC is that partner.
In a recent survey, 87% of our pharma customers agreed or strongly agreed that NCC’s sourcing expertise is excellent and is better than competitors* With full supply chain traceability and the highest global standards, NCC is that essential link in your supply chain.

*Customer survey results 2022
To learn more about NCC and our approach to sourcing:
T. +353 1 613 1400 E. hello@ncc.ie W. ncc.ie
Hovione: Endto-End Solutions from One Site
Hovione: endto-end solutions from one site

Hovione is a global company with over 60 years of experience as a Contract Development and Manufacturing Organisation with a fully integrated offer of services for drug substance, drug product intermediate and drug product, always based on a culture of innovation, quality and delivery.


In it for Life
Hovione has 60 years of experience as a Specialist Integrated CDMO (Contract Development and Manufacturing Organisation), with a range that includes drug substances, drug product intermediates and drug products. With four FDA inspected sites in the US, Macau, Ireland, and Portugal, and development laboratories in Lisbon and New Jersey, the company provides branded pharmaceutical customers with services for the development and compliant manufacture of innovative drugs and is able to support highly potent compounds. For generic pharmaceutical
Staff at Hovione are dedicated to helping customers bring new and off-patent drugs to market and offer innovative particle engineering technologies, at all scales, to address challenges in drug delivery. “’In it for Life’ is our motto,” explains Paul Downing, General Manager, Hovione
Ireland. “We exist because patients need us and serving patients is a privilege.”


customers, the company offers niche off-patent API products. Hovione also provides proprietary product development and licensing opportunities for drug products. In the inhalation area, Hovione is the only independent company offering a complete range of services. As a leader in spray drying, Hovione has the largest capacity, the best scale-up science and the most experienced team to take your project from development to market.
that is particularly suited for large volume products.


and to facilitate onboarding of Drug Substance Manufacturing projects of all sizes,” concludes Paul Downing.

Currently employing more than 230 team members, the Hovione Cork site offers Contract Manufacturing for both drug substance and particle engineering. The plant is regularly inspected by the FDA and by the Health Products Regulatory Authority. With extensive facilities for drug substance manufacturing and approximately 430 cubic meters of state-of-the-art cGMP capacity and the potential for 12 discrete chemical process trains, the site also houses one of the largest commercial pharmaceutical spray dryers available on the market, one
With a view to helping customers solve complex problems, Hovione has invested in building know-how and expertise in particle design


and formulation development for highly sophisticated inhalation APIs. They apply QbD principles in every carrier-based or composite particles formulation development endeavour, ensuring early-on scalable processes to their partners.



Sustainability Focus
In Ireland, Hovione has been independently certified by B-Corp, Business in the Community Ireland, Ecovadis, Responsible Care, excellence in energy efficiency design (EXEED) and most recently achieved the ISO 50001 Energy management certification. This demonstrates the company’s commitment to be a responsible and sustainability focused organisation.
Hovione offers end-to-end solutions at a one-site-stop, from drug substance to drug product intermediate to drug product, which means API synthesis, particle engineering, formulation and powder filling can all be developed, characterised and GMP manufactured on the same site. These integrated services can


“In the next number of years we will continue to invest to enable the production of Highly Potent Active Pharmaceutical Ingredients (HPAPI)
minimise risk, save cost and time on development and manufacturing processes.


For more information, please visit www.hovione.com.

For more information, please see www.hovione.com.



ContraC t Development an D m anufaC turing
Speciali S t i ntegrated cdMO
Irish PharmaChem | Industry Buyers Guide 2022 65
Irish PharmaChem | Industry Buyers Guide 2023 88
hovione.ie
Westbourne’s World: where your critical technologies always work
Westbourne IT Global Solutions Ltd work with their client’s IT department as an outsourced extension of their team, delivering short, medium- and long-term projects in their laboratories, such as:
• Innovation projects – road maps for moving to paperless labs;
• Computer System Validation (CSV) and process documentation projects;
• Lab Application Upgrades – instrumentation / software;

• Business Process Improvements - reducing compliance risk, process automation;
• LIMS – LabWare / LabVantage upgrades / installation, integration projects;
• Pre-audits / site surveys;
• Data analytics – forecasting and planning. Westbourne IT’s lab services put lab users in a data-driven IT environment and at the centre of their business. They offer In Lab, Near-Lab and RemoteLab support and provide exceptional right first-time fix rates from teams of IT-enabled scientists and lab savvy IT engineers.
Westbourne IT’s teams provide support for lab applications such as LIMS, LES, Empower, Discoverant and Citrix. Additionally, their engineers ensure that your IT network is working end-to-end, so laptops, software and infrastructure work together with customer lab systems. The impact of the everincreasing digitalisation of our world at the business
and the social level is increasing expectations on IT support. Always available, “always up” becomes a challenge for labs and IT.
Why Westbourne?
• GxP Compliance
o Fully compliant engineers;
o Rigorous up-skill training programme:
• Driven by forward thinking and highly qualified training department;
• GAMP5 and CSV certified.
• Confidence in people supporting your labs
o Proven track record of delivering lab projects;
o Effective communication (multi-lingual, professional);
o Highly qualified and certified staff;
o Bench of engineers to ensure uninterrupted service levels;
o ITIL and SDI trained.
• Confidence in your IT infrastructure and applications
o ITIL driven ticket resolution;
o High ‘right first time’ fix levels;
o Metric driven continuous improvement initiatives
o Indicative Dashboard below gives a flavour of their approach.

• Cost effective and flexible
o Shared or dedicated service;
o Pay only for what you need;
o Stand alone or integrate into your existing solution;
o Grow as you grow;
o Flat reporting structure so greater control over quality of service;
o Onsite / off-site.
Who are Westbourne IT?
Founded by Chief Executive Officer, John O’Sullivan in 1994, Westbourne IT Global Services delivers multi-lingual technical service desk solutions and lab IT solutions to highly regulated companies in the biopharmaceutical, med-tech and food sectors, on a global scale.
Westbourne IT is a flexible, niche provider of topend, high-quality remote and on-site IT services on a 24 x 7 x 365 basis from delivery centres in Cork and Auckland, New Zealand. The focus is always on putting customer service and ticket ownership at the centre of the service to deliver an exceptional customer experience in over 10 languages, with follow-the-sun availability.
Client range
Westbourne IT’s clients range from start-ups to top
10 pharmaceuticals, biotech and food & beverage companies.
For more information, contact:
Westbourne IT Global Solutions Ltd Rubicon Centre, MTU, Bishopstown, Cork, T12 Y275

Tel: (021) 4314310 www.westbourneit.com
Contact details: John O’Sullivan
Email: john@westbourneit.com
IT Serv I ce S
Irish PharmaChem | Industry Buyers Guide 2023 89
Optimising your lab IT
Outside of your laboratories, IT support teams use the ITIL framework to improve efficiency and achieve predictable service delivery of IT assets. Modern laboratories have PC-based instruments and systems which are required to comply with GMP rules, such as those established by the FDA and the EMA, for example.
As your laboratory becomes more integrated and IT based, so will the tools you need to manage it. Westbourne IT predict that within three years, any laboratory operating at Level 3 or higher of their maturity model below will also be using ITIL framework to resolve IT issues.

Why ITIL?
ITIL stands for Information Technology Infrastructure Library and uses four elements - service strategies, service design, service operations and service transition - to ensure IT service providers deliver best practice in a continuous service improvement environment.

ITIL exposes the root cause of all reliability issues of your instruments and systems in the laboratory.
Is the answer Yes?
• Do you understand what is happening
with IT systems’ reliability, instrument IT status and Windows 11 upgrade in your QC Laborator y?
• Are you certain that don’t get the same IT issues repeating themselves?
• Do you have a dashboard on a TV monitor
in your laboratory showing status of testing?
• In a multi-lab environment, do you use your IT engineers effectively and could some work be done remotely?
If the answer is ‘No’ to any of these questions then Westbourne IT is ideally placed to support you deploying these practices so you can expedite the resolution of IT systems, applications and instrument issues and achieve increased operating efficiencies. Contact John O’Sullivan to discuss how Westbourne IT can achieve increased operating efficiencies in your Laboratory IT.
For more information, contact: Westbourne IT
Rubicon Centre, MTU, Bishopstown, Cork, T12 Y275
Tel: (021) 4314310 www.westbourneit.com
Contact details: John O’Sullivan
Westbourne IT predict that within three years, any laboratory operating at Level 3 or higher of their maturity model will also be using ITIL framework to resolve IT issues.
Email: john@westbourneit.com
Irish PharmaChem | Industry Buyers Guide 2023 90 IT Serv I ce S
QC Lab Managers should adopt IT best practices, such as those from Westbourne IT, to optimise your lab IT.
Digitisation Meets Calibration
The world of pharmaceutical, chemical, biotechnology and medical device manufacturing is swiftly evolving, and so is the role played by technology in maintaining critical asset records. So, what kind of automation technologies can businesses use efficiently to maintain sustained competitive advantages across their industries?
Paperless Calibration
One method that is significantly changing asset management is Paperless Calibrations. Gone are the days when a human had to play the burdensome role of manually managing calibration records and maintenance. Paperless Calibrations now complete tasks in a matter of minutes, enabling businesses to grow and scale at speeds that were previously unthinkable.
Partner Portal
Bonner has performed periodic
process and laboratory calibrations using paperless solutions for over 10 years. Today, they can deliver a calibration management system that gives clients direct access to all their assets, information and history in real-time. This portal allows you to securely make decisions and take
actions from anywhere in the world.
Traceability
Calibrations are completed on-site by Bonner’s qualified technicians, who have unparalleled holistic understanding of your production process. They conduct traceable calibrations using test instruments certified in an ISO17025 laboratory. Bonner’s Partner Portal provides digitally complete reports, generates certificates and labels that guarantee audit readiness and are available the same day.
Standards You Can Trust
For over 40 years, Bonner has been setting the standards for calibration in Ireland, making them the partner of choice for quality assurance managers.

One thing is certain: Paperless Calibration is here to stay. The only question is when will you take part in it?

Calibration
Irish PharmaChem | Industry Buyers Guide 2023 91 C M Y CM MY CY CMY K ai165849213027_Bonner_FI2022_180x131_04.pdf 1 22/07/2022 13:15
Barentz: a Broad Portfolio to Suit A ll Applications
Barentz represents some of the world’s foremost producers of excipients, APIs, nutraceutical, and biopharma ingredients.
Binders
Diluents
Disintegrants
Glidants
Ingredients distributor Barentz offers pharmaceutical manufacturers a range of ingredients to suit every application, including challenging formulations.


Barentz is a global life science ingredients distributor, specialising in human nutrition, pharmaceuticals, personal care and animal nutrition, creating unique synergies across all fields of expertise.
Founded in 1953, Barentz is now present in over 65 countries, with a global team of more than 2,000 local experts, dedicated to 22,000 customers and with a turnover of €2.1 billion. Driven by the powerful blend of entrepreneurship, partnership and knowledge, Barentz is known as the global life sciences ingredients distributor and create and delivers ‘Always a better solution’.
Barentz acquired Forum Products in 2011 and rebranded it as Barentz Ireland in 2019. Barentz’s success lies in building long-lasting relationships with suppliers and customers, based on trust, transparency and reliability, where going the extra mile to provide customer satisfaction is part of the company’s DNA.
High quality ingredients and technical expertise
Barentz has a skilled team of technical sales
managers, offering a broad portfolio of ingredients to suit every application. They are on hand to select the optimum combination of ingredients to assist with solving the formulation challenges and manufacturing demands of customers.
Barentz represents some of the world’s foremost producers of excipients, APIs, nutraceutical and biopharma ingredients, including Roquette, Meggle, Dr Paul Lohmann, IFF, Ajinomoto, Abitec, Asahi Kasei, Sandoz & Moehs. Barentz supplies a range of customers producing specialist pharma, generics, OTC, CMOs/CDMOs, biopharma, medical devices, nutraceutical, and healthcare supplements.
Why Barentz is the right business partner for you
Barentz offers clients:
In-house technical scientists, providing specialist advice on ingredient choices and functionality;
Local sales office, staffed with technical sales managers and support staff ;
Local, regional & central (HUB) warehousing;
Combined order management and sampling service with harmonised ERP/ CRM systems;
Fully implemented QA systems, ISO9001:2015 and GDP cer tified.
For more information, contact Barentz Ireland Ltd, Block S, Grants View, Greenogue Business Park, Rathcoole, Co. Dublin, D24 XN60 Tel: (01) 4039518
E-mail: pharmaireland@barentz.com
Web: www.barentz.com
Irish PharmaChem | Industry Buyers Guide 2023 92
Ingred I ents
Sugars Controlled Release Oils, fats, and waxes Preservatives Emulsifiers Permeation enhancers Antihypertensives Antiarrhythmics Sedatives Anthelmintics Diuretics Mineral salts for Atypical & Speciality APIs FILLERS TASTE MASKING E XCIPIENTS F o R Nu TR ACE u TIC ALS API S A broad portfolio of premium quality and high-performance ingredients
Lubricants Flavours Sweeteners Solubilisers


www.barentz.com
a better solution. At Barentz, we have made it our business to excel in delivering premium quality and high performance excipients, APIs & nutraceutical ingredients – sourced and provided by our partnered suppliers. Customers greatly value our deep technical knowledge and extensive product portfolio, our capability to manage quality throughout the entire supply chain and our local presence. Contact our Dublin sales office at pharmaireland@barentz.com or call us at + 353 1 4039518.
Always
Cleanrooms without the Headaches
Dawsongroup TCS Ireland are well known in the pharmaceutical and life sciences sectors for their temperature control solutions, whether it’s 2-8 degrees, 15-25 or ultra low temperatures. Thanks to extensive R&D, they have been able to introduce a wide range of cleanroom solutions for customers.
Dawsongroup TCS Ireland Ltd have 20+ years’ experience in modular designs and are a market leader in providing MHRA compliant modular and portable temperature control solutions to the pharmaceutical industry. The same level of dedication, attention to detail and quality is applied to the design and construction of DGTCS Modular Cleanrooms.
Dawsongroup TCS Ireland’s Modular Cleanrooms are 4 metres wide, making them much wider than a permanent cleanroom usually is, and because they are modular, any size structure can be created. They meet the specifications for International Organization for Standardization (ISO) Class 9 to Class 5, making them ideal for a range of solutions in different industries. Currently, they are primarily used for packaging, manufacturing, and Research & Development in the pharmaceutical industry, and engineering processes.
Modular Cleanrooms to Rent or Buy
Not only do DGTCS Modular Cleanrooms provide solutions for a range of industries, they are also the only modular cleanrooms which are available to rent instead of buy. This makes them the most convenient solution for any
Dawsongroup TCS Ireland have introduced a wide range of cleanroom solutions for customers, including modular cleanrooms to rent as well as buy.
This means there is no disruption to business processes or staff when installing them, or when they reach the end of the time they are needed for and they are removed.
“There are many benefits of using our modular cleanrooms,” explains Susan Conroy, Managing Director, Dawsongroup TCS Ireland. “They are great for contract manufacturing which needs a cleanroom but where there is a limited time and/or space to install one. They can be completely standalone or connected to an existing building. Dawsongroup modular cleanrooms can be bespoke and can be delivered and installed in a short timescale. The rooms are fully integrated to include HVAC, electrics, lighting, plumbing and monitoring.

business. There is no significant capital outlay, and they can be provided purely for the length of time they are needed. Most cleanrooms are built inside an existing building, which therefore causes significant disruption to a company whilst being installed. In comparison, DGTCS Modular Cleanrooms can be built externally.

“Our modular cleanrooms temporarily extend the floorspace in the client’s own facility, without the need for significant capital expenditure, ensuring financial flexibility to our clients. As individual units, our Modular Cleanrooms are a plug-and-play solution. There is very little disruption on-site during installation and it instantly adds value to their business.”
For more about Modular Cleanrooms and the other solutions Dawsongroup TCS Ireland can provide for your business, visit www.dawsongroup.ie or call their Naas office on (045) 448810.
Irish PharmaChem | Industry Buyers Guide 2023 94 Modular
M s
Cleanroo
Susan Conroy, Managing Director, Dawsongroup TCS Ireland.



Dawsongroup TCS Ireland Book your free consultation dawsongroup.ie | +353 (0)45-448810 | contactus@dawsongroup.ie *Compared to other commercial units Market leading rentable temperature control solutions you can rely on with dual refrigeration systems and auto-switch in the event of a fault, ensuring your high value products are never exposed to unwanted temperatures. 30-minute Fire Resistant Data monitoring and full temperature mapping LPBC approved and MHRA compliant Stability Chambers | Atex Storage | Humidity Control | Hot Boxes | Test Chambers | Blast Freezers | -70ºC Freezers Reach In | -40ºC Freezers | -20ºC Freezers
Grifols Inaugurates Albumin Plant in Dublin
Grifols new 17,000 square metre albumin plant in Grange Castle brings its total investment in its Irish operations to around €300 million since 2012.
Grifols, a global leader in plasma-derived medicines, will inaugurate a new albumin purification and filling plant at its global manufacturing and supply hub in Grange Castle, Dublin, which will help address the growing demand for this vital plasma-derived medicine.
The newly built plant, which adds more than 17,000 square metres to Grifols’ cutting-edge facilities in Dublin, is part of the company’s continued global growth strategy and investment in critical plasma infrastructure. This expansion brings Grifols’ total investment in Irish operations to over €300 million since first establishing a presence in the country in 2012.

Dublin is the Group’s fifth manufacturing site for essential plasma medicines, alongside Barcelona; Clayton, North Carolina; Los Angeles, California; and Dreieich, Germany. Additional Grifols manufacturing sites under construction will become operational in Montreal, Canada, in 2024, and El Cairo, Egypt, in 2025.
Ireland has continued to prove an attractive location for Grifols, given its highly educated and skilled workforce, in addition to its
strategic position between North America and continental Europe and its pro-business environment. The expansion will provide considerable employment opportunities in the Dublin region across entry-level and specialist roles in manufacturing, logistics and packaging. Grifols expects the number of employees, currently more than 300, to increase to over 500 between 2022 and 2024, including considerable employment opportunities across entry-level and specialist roles in manufacturing, logistics and packaging.
Expansion in Dublin
“The new plant, displaying Grifols’ industryleading technological excellence, is part of our broader expansion in Dublin that includes the growth of the supply chain and logistical operations of our biopharma business unit, all of which brings additional professional development opportunities to the Irish workforce,” said Shane O’Brien, Vice President of Grifols Worldwide Operations.
Then Tánaiste and Minister for Enterprise, Trade and Employment, Leo Varadkar TD, welcomed Grifols’ continued investment in Ireland and the 200 extra jobs this will bring to Dublin: “Having steadily grown its presence in Ireland over the last decade, Grifols’ further expansion reinforces Dublin as an important centre of the company’s global operations. It’s further proof of Ireland’s role as a major biopharmaceutical and international trade hub, with a highly talented workforce available.”
Martin Shanahan, CEO of IDA Ireland, said, “This significant investment by Grifols marks a 10-year milestone in its commitment to Ireland. The Irish site plays an important role in in providing vital plasma-derived medicine to treat disease around the world. We welcome the company’s plans to create new employment opportunities across several activities and look forward to continued success for Grifols in Ireland.”
Growing Demand for Albumin
Specifically, the new plant will help Grifols meet growing demand for albumin, which is expected to increase by a compound annual growth rate of around 5% over the next five years. The most abundant protein found in plasma, albumin is used to replace lost fluids, restore vital blood volume and to treat prevalent diseases such as cirrhosis. Grifols is also advancing its potential use to treat neurological degenerative disorders.
“This new magnificent Dublin manufacturing facility, which incorporates Grifols industryleading engineering, is indicative of this company’s commitment to investing in essential plasma-medicine infrastructure globally to treat more patients around the world,” concluded Víctor Grifols Deu and Raimon Grifols, Grifols co-CEOs. “The significant investment underlines our long-term commitment to Ireland and reinforces Dublin’s role as a critical nerve centre for Grifols’ global operations.”
Grifols
Irish PharmaChem | Industry Buyers Guide 2023 96
INNOVATIVE PLASMA THERAPIES
A pioneer in the plasma industry, Grifols manufactures lifesaving plasma-derived medicines to treat chronic and rare conditions, as well as infectious diseases.
Learn more about Grifols at www.grifols.com

In 2022, GE Healthcare opened a new $30 million production line for pharmaceutical imaging agents at its Ireland Campus in Carrigtohill, Co. Cork. The new line, which has created 140 jobs, manufactures injectable diagnostic imaging agents (contrast media) used in Xray and Computed Tomography (CT) procedures around the world.

The growing global prevalence of chronic disorders has driven significant growth in CT procedures, leading to increased demand for iodinated contrast media, used to enhance visualisation of organs, blood vessels and tissues across disease pathways. GE Healthcare expects global demand for iodinated contrast media to double over the next 10 years due to the continued growth of CT imaging procedures.
GE Healthcare’s Pharmaceutical Diagnostics business develops and manufactures imaging agents used to support over 100 million procedures per year globally, equivalent to three patient procedures every second. It is estimated that the new manufacturing line will increase production capacity at the Cork facility by over 50% by 2025.
Doubling of Demand
“This new production line is central to our continued growth and to meeting future, estimated, doubling of demand driven by significant increase in CT procedures,” revealed Eugene Barrett, GE Healthcare Ireland Site Leader, who leads the 765-strong team at the Cork facility. “Our focus is very much on our customers and their patients and expanding and strengthening our talented and dedicated team in Cork so that we can deliver more patient doses for our customers. That’s good for our customers, knowing we are investing in securing future supply of contrast media, and it’s good for the local economy too and a recognition of the significant role Cork plays in manufacturing imaging agents used across the globe.”
GE Healthcare has already invested almost $400 million in the past 10 years to increase capacity across its global manufacturing network. In 2022, alongside opening of the new production line in Cork, GE Healthcare also announced an $80 million expansion of its active pharmaceutical ingredient (API) site in Lindesnes, Norway, and signed a multi-year agreement with a leading iodine supplier to secure increasing volumes of iodine raw material. These investments are all part of the company’s commitment to produce 30 million more patient doses annually by 2025. GE Healthcare is the world’s leading supplier of contrast media,
Securing Future Contrast Media Supply
used to support patient imaging procedures in 130+ countries globally.
The new production line was delivered over 24 months, with Design & Project Management led by BioPharma Engineering, and construction works completed by MMD Construction.
Good Manufacturing Practices
GE Healthcare’s contrast media manufacturing
adheres to current Good Manufacturing Practices. With over 4,000 employees globally, and seven manufacturing sites, GE Healthcare’s Pharmaceutical Diagnostics business also develops and supplies radiopharmaceuticals used to support diagnosis, monitoring and treatment selection across Neurology, Cardiology and Oncology clinical pathways. For more information about roles currently open at GE Healthcare, visit https://jobs.gecareers.com/global/en.
Irish PharmaChem | Industry Buyers Guide 2023 98 Contrast Media
GE Healthcare’s new $30 million pharmaceutical imaging agents facility in Cork secures the future supply of contrast media, as demand is projected to double.
Minister for Public Expenditure and Reform, Michael McGrath TD, is pictured at the official opening of GE Healthcare’s new $30 million production line for pharmaceutical imaging agents at its Ireland Campus in Carrigtohill, Co. Cork. Also pictured are Michael Lohan, Head of Life Sciences, IDA Ireland; John O’Reilly, Managing Director, Biopharma Engineering; Tanya O’Sullivan,Site Quality Lead;Eugene Barrett, GE Healthcare Site Lead; and Kevin O’Neill, President & CEO, GE Healthcare Pharmaceutical Diagnostics.
eLearning Enables Effective First Impressions


The American writer Cynthia Ozick once said, “two things remain irretrievable: time and a first impression.” Your opportunity to make a lasting good first impression on your new employees happens only once. As you teach new starters important information about the structure of the organisation, company culture, best practices, colleagues’ names and roles, rules, tools used and responsibilities, you also have the critical opportunity to develop their personal identification and emotional relationship with the company. An effective first impression informs as well as bonds new employees. Technically Write IT (TWi) can help you achieve this.
“To create a strong first impression with a lasting impact, TWi works closely with you to determine your specific needs,” explains Paula Álvarez, Information Developer, Technically Write IT. “First, we analyse your audience, conduct a detailed learners’ needs analysis and establish clear, achievable learning objectives. We help you decide whether to include interactive videos and images, simulations, animated content, branching scenarios, games, knowledge checks and assessments.”
A Human-Centred Approach
Throughout the development process, TWi applies a human-centred approach.


“We combine our mastery of andragogy (adult learning) with a generous range of resources, tools and design expertise, while successive iterations refine our product to ensure top quality,” Paula notes. “This is how we create enjoyable highimpact learning experiences that offer a warm welcome to your new employees.”


Ultimately, your new starters experience a visual learning journey that engagingly guides them through the process of developing the skills required for their new roles. By providing them with such a considerately presented experience, you foster their functional competency, as well as a positive human experience. “Arguably, the best first impression during onboarding will always include some eLearning,” Paula concludes. “Online and blended learning formats that save company time by streamlining the training process and optimising resources simultaneously offer consistent, high-quality onboarding for everyone joining.”
For more information, visit technicallywriteit.com.
e Learning
Paula Álvarez, Information Developer, Technically Write IT.
Irish PharmaChem | Industry Buyers Guide 2023 SCAN HERE info@technicallywriteit.com More Information technicallywriteit.com +353 21 242 8800 From content strategy to publishing and more, we offer customised end-to-end workflows, expertise, and management of your content projects. TECHNICALLY WRITE IT Increase software user adoption Effectively onboard new hires Enable true behavioural change Digitise existing training content 1 2 4 3
Robots Transforming Pharma Manufacturing
Robots continue to bring huge advantages to pharmaceutical manufacturing, assisting in the management of complex, time-consuming tasks that require agility and resilience around the clock.

Pharmaceutical manufacturers require stateof-the-art, smart production equipment to meet the changing needs of the industry. Mass produced pharmaceutical recipes are becoming a thing of the past, as demand for product, aligned with changing consumer behaviours is driving mass customisation. Intolerances, allergies and the changing dynamics of infectious conditions mean that one size no longer fits all.
Maintaining the best quality product output, mitigating waste and satisfying demand are crucial to pharmaceutical manufacturers. Robots and automation are integrating into solutions that enable the successful and efficient delivery of products across a diverse, domestic market that is being challenged by international competition - reduced cost of production enables the delivery of costefficient products to market.
Robot technology from KUKA can be employed right along the process chain, from API recipe testing and ingredient measuring to packaging product in clean room facilities. Such robot models have been specifically adapted to operate under the strictest of hygienic conditions, manufactured of stainless steel and safe for utilisation in direct contact with pharmaceutical substances. A variety of robot models, from mobile robots to collaborative medical iterations, are available and are being used, today, to assist in the management of complex and sometimes time-consuming tasks that require agility and resilience around the clock.
New Levels of Laboratory Test Excellence
Covid-19 saw an explosion in the adoption of innovative, automated solutions to meet urgent market demands. The management of an increase in complex and varied laboratorybased tasks, coupled with the challenges presented by social distancing, meant robotics were in many cases the natural fit to sustain increased levels of activity, which couldn’t be undertaken by humans in the same timeframes and at such high volumes. New levels of laboratory testing excellence were achieved
The accurate and repeatable characteristics of modern day robotic technology mean the dexterity of task execution is far superior to that which can be undertaken by humans and can be sustained, without interruption, over long periods of time.
thanks to robotic and digital technologies; one such solution, a mobile robot scientist, developed by Liverpool University, conducted 688 experiments over eight days, working for 172 out of 192 hours. In doing so, it made 319 moves, completed 6,500 manipulations, and travelled a total distance of 2.17km.
Automated tasks within the pharmaceutical industry can include weighing-out solids or dispensing liquid. The accurate and repeatable characteristics of modern day robotic technology mean the dexterity of task execution is far superior to that which can be undertaken by humans and can be sustained, without interruption, over long periods of time.
Traceability & Recalls
Traceability, once a product leaves a facility,
is also a vital consideration in fast-paced environments, such as the pharmaceutical sector. Having the appropriate coding and marking solutions in place, often delivered by automated robot methods and supported by integrated vision inspection systems, ensures that recalls can be quickly and efficiently managed. Global Trade Item Numbers (GTIN) applied by robots can be done so at speed and across high product volumes, ensuring compliance.
Technological advancements, such as robotics and automated processes, are enabling the pharmaceutical industry to serve more people than ever and advance medicinal research. As the needs of the industry become ever more challenging, an intelligent, digital workforce is just around the corner.
Robotics
Irish PharmaChem | Industry Buyers Guide 2023 100
Automating the healthcare sector: robot-based solutions, shaping the medical technology of the future
Robotic lab solutions optimise workflows and provide personnel with more time for highervalue tasks in their daily work. KUKA robots meet the specific technical requirememts of fast-paced, sterile environments, that demand highly-accurate, repetitive application delivery.

Featured: KR AGILUS HM (hygienic machine). The design and material of this variant are absolutely hygienic. This enables use in applications with direct contact with food and pharmaceutical substances.
KUKA Ireland Ltd.
T: 042 9395034
E: sales.ie@kuka.com

As the demand for top talent grows, pharmaceutical and chemical companies are turning to outsourced & managed talent solutions.
Cpl's Talent Evolution Group (TEG) is an expert, multi-disciplinary group with over 30 years of experience executing the most evolved talent solutions, from Recruitment Process Outsourcing (RPO) to Managed Service Provision (MSP).
Our track record within the pharmaceutical and chemical industries, coupled with our passion for transforming organisations will benefit you in many ways:

• Reduced time & cost per hire



• Ability to flex and scale with your business
• Improved candidate experience
• Specific strategies to fill roles
• Flexible solutions to meet all talent requirements

• Future-proofed hiring
Discover how we can help you resolve your talent challenges today: www.talentevolutiongroup.com

C M Y CM MY CY CMY K TEG QTR Page Ad Portrait 1 Mock Up 8.pdf 1 15/12/2022 10:30:06 “SERVICE, QUALITY AND RELIABILITY” Optimising your Packaging Management Call: 090 9741148 Email: sales@quitmannoneill.com Address: St. Brendan’s Road, Portumna, Co. Galway, H53 HX51
CHEMICAL SUPPLIERS
Camida Ltd
Acids & A lk A lis
AQS Environmental Solutions
Associated Chemicals Ltd
Brenntag Ireland
Calx Instrumentation Services Ltd
Camida Ltd
Carbon Group
Chemco Ireland Ltd
Chemifloc Ltd
Fisher Scientific Ireland Ltd
Goulding Chemicals Ltd
Heterochem Dist Ltd
Micro-Bio Ireland Ltd
National Chemical Company
Q1 Scientific
Solv-Echem Ireland Ltd
Univar
ActivAted c A rbons
Associated Chemicals Ltd
Brenntag Ireland
Chemco Ireland Ltd
Fisher Scientific Ireland Ltd
National Chemical Company
Univar
Active PHA r M Ace U tic A l in G redients
AbsorboPak
Barentz
Corcoran Chemicals Ltd
Mallinckrodt Pharmaceuticals
Micro-Bio Ireland Ltd
SK Pharmteco
bioc H e M ic A ls
Alexion
Arran Chemical Company
Associated Chemicals Ltd
Camida Ltd
Carbon Group
Corcoran Chemicals Ltd
Fisher Scientific Ireland Ltd
GI Chemicals
Micro-Bio Ireland Ltd
Pharmalex
Univar
biocides
Associated Chemicals Ltd
Brenntag Ireland
Camida Ltd
Carbon Group Chemco Ireland Ltd
Corcoran Chemicals Ltd
Fisher Scientific Ireland Ltd
Heterochem Dist Ltd
Univar
c AtA lysts
Arran Chemical Company
Associated Chemicals Ltd
Camida Ltd
Fisher Scientific Ireland Ltd
Ortec Inc.
National Chemical Company
SK Pharmteco
c H ir A l co MP o U nds
Arran Chemical Company
Associated Chemicals Ltd
Camida Ltd
Fisher Scientific Ireland Ltd
Hovione Ltd
National Chemical Company
SK Pharmteco
exci P ients
Actylis
Associated Chemicals Ltd
Azelis
Barentz
Brenntag Ireland
Chemco Ireland Ltd
Corcoran Chemicals Limited
Greenfield Global
Heterochem Dist Ltd
Micro-Bio Ireland Ltd
National Chemical Company
Ortec Inc.
Univar
fine c H e M i c A ls
Actylis
AbsorboPak
Arran Chemical Company
Associated Chemicals Ltd
Azelis
Brenntag Ireland
Camida Ltd
Carbon Group Chemco Ireland Ltd
Corcoran Chemicals Limited
Fisher Scientific Ireland Ltd
Greenfield Global
Heterochem Dist Ltd
IDA Ireland
Micro-Bio Ireland Ltd
National Chemical Company
Ortec Inc.
SK Pharmteco
Solv-Echem Ireland Ltd
GA ses
National Chemical Company
H eterocyclics
Arran Chemical Company
Associated Chemicals Ltd
Camida Ltd
Corcoran Chemicals Ltd
National Chemical Company
ind U stri A l c H e M ic A ls
Corcoran Chemicals Ltd
GI Chemicals
Micro-Bio Ireland Ltd
inor GA nic c H e M ic A ls
Associated Chemicals Ltd
Brenntag Ireland
Camida Ltd
Carbon Group
Chemco Ireland Ltd
Chemifloc Ltd
Corcoran Chemicals Limited
Fisher Scientific Ireland Ltd
GI Chemicals
Heterochem Dist Ltd
Micro-Bio Ireland Ltd
National Chemical Company
Ortec Inc.
Solv-Echem Ireland Ltd
Univar
l A bor Atory re AG ents
Associated Chemicals Ltd
Bonner
Corcoran Chemicals Ltd
Fisher Scientific Ireland Ltd
Heterochem Dist Ltd
IDA Ireland
Micro-Bio Ireland Ltd
Solv-Echem Ireland Ltd
Misc c H e M ic A ls
AbsorboPak
Arran Chemical Company
Associated Chemicals Ltd
Azelis
Brenntag Ireland
Camida Ltd
Carbon Group Chemco Ireland Ltd
Chemifloc Ltd
Corcoran Chemicals Limited
Fisher Scientific Ireland Ltd
Greenfield Global
Heterochem Dist Ltd
National Chemical Company
Solv-Echem Ireland Ltd
Univar
oil s, fAts A nd wAxes
Associated Chemicals Ltd
Brenntag Ireland
Carbon Group
Corcoran Chemicals Limited
Heterochem Dist Ltd
or GA nic inter M edi Ates
Arran Chemical Company
Associated Chemicals Ltd
Camida Ltd
Corcoran Chemicals Ltd
Fisher Scientific Ireland Ltd
Heterochem Dist Ltd
Hovione Ltd
IDA Ireland
National Chemical Company
Ortec Inc.
SK Pharmteco

Univar
or GA no M e tA llics
Arran Chemical Company
Associated Chemicals Ltd
Camida Ltd
National Chemical Company
re AG ents
Associated Chemicals Ltd
Camida Ltd
Corcoran Chemicals Ltd
Fisher Scientific Ireland Ltd
Heterochem Dist Ltd
IDA Ireland
Micro-Bio Ireland Ltd
National Chemical Company
Source BioScience
sil A nes
Arran Chemical Company
Associated Chemicals Ltd
Brenntag Ireland
Camida Ltd
Fisher Scientific Ireland Ltd
Heterochem Dist Ltd
Ortec Inc.
Univar
solvents
Actylis
Brenntag Ireland
Camida Ltd
Carbon Group
Chemco Ireland Ltd
Corcoran Chemicals Limited
Fisher Scientific Ireland Ltd
Greenfield Global
Heterochem Dist Ltd
National Chemical Company
Univar
s U rfActA nts
Actylis
Associated Chemicals Ltd
Brenntag Ireland
Camida Ltd
Carbon Group
Corcoran Chemicals Limited
Fisher Scientific Ireland Ltd
Greenfield Global
Heterochem Dist Ltd
tre At M ent c H e M ic A ls
Corcoran Chemicals Ltd
GI Chemicals
Micro-Bio Ireland Ltd
Irish PharmaChem | Industry Buyers Guide 2023 103
GENERAL SUPPLIERS
AG itAtors
CPI Technology Ltd
Quitmann O’Neill
A ir / r oA d / oce A n frei GH t
AbsorboPak
Hazchem Training Ltd
Kuehne + Nagel
Portakabin Ireland
UPS Healthcare
A ir filtr Ation / M onitorin G / in G redients
CMS Chemstore Engineering Ltd
A lUM ini UM P r od U c ts
Foltech Engineering Ltd
Quitmann O’Neill
A n A lysis services
Almac Sciences Ltd
ATG Scientific Ltd
Bonner
Charles River Laboratories Ireland Ltd
Charles River Microbial Solutions
Corcoran Products Ltd
Eurofins Biopharma Product Testing
GI Chemicals
IDA Ireland
Particular Sciences Ltd
Reading Scientific Services Ltd
SK Pharmteco
A n A lytic A l e QU i PM ent
ATG Scientific Ltd
Bonner
Endress & Hauser (Ireland) Ltd
Fisher Scientific Ireland Ltd
LABPLAN
Particular Sciences Ltd
Scientific Instruments Ireland
A ssoci Ations
GS1 Ireland
AU tocl Aves
Fisher Scientific Ireland Ltd
Scientific Instruments Ireland
AU to MAtion
Bonner
Endress & Hauser (Ireland) Ltd
LABPLAN
O’Flynn Medical Ltd
Portakabin Ireland
ProSys Containment and Sampling Technology
Tekpak Automation Ltd
b A l A nces
Bonner
Fisher Scientific Ireland Ltd
Scientific Instruments Ireland
b A r code verific Ation
GS1 Ireland
Holfeld Graphics
Tekpak Automation Ltd
b A r codin G / l A bellin G / tr Ace A bilit y
Corcoran Products Ltd
GS1 Ireland
Holfeld Graphics
Tekpak Automation Ltd
biointer Action A n A lysis
ATG Scientific Ltd
biolo G ics
MSD Ireland
bio PHA r MAce U tic A ls
AbsorboPak
Actylis
Alexion
Almac Sciences Ltd
Barentz
BS&B Safety Systems Ltd
Charles River Laboratories Ireland Ltd
Charles River Microbial Solutions
DHL Supply Chain
Eurofins Biopharma Product Testing
IDA Ireland
Janssen
Micro-Bio Ireland Ltd
MSD Ireland
Pharmalex
Portakabin Ireland
Reading Scientific Services Ltd
bio PHA r MA / biotec H s UPP liers
BS&B Safety Systems Ltd
bio PHA r MA / biotec H s UPP orts
Flexachem Manufacturing Ltd
biotec H nolo G y
Almac Sciences Ltd
Charles River Microbial Solutions
IDA Ireland
Labplan
Mallinckrodt Pharmaceuticals
Micro-Bio Ireland Ltd
MSD Ireland
Particular Sciences Ltd
Pharmalex
blenders
Fisher Scientific Ireland Ltd
Ortec Inc.
blisterin G / de - blisterin G
Holfeld Graphics
blowers
CPI Technology Ltd
b P rv
BS&B Safety Systems Ltd
CPI Technology Ltd
c A bine ts
Fisher Scientific Ireland Ltd
Foltech Engineering Ltd
Source BioScience
c A libr Ation
Ballinlough Pharma Solutions
Bonner
Labplan
LotusWorks
c A rtonin G syste M s
Tekpak Automation Ltd
c A se erec tin G / PAckin G
Tekpak Automation Ltd
centrif UG es
AQS Environmental Solutions
Central Pump Supplies Ltd
CPI Technology Ltd
Fisher Scientific Ireland Ltd
Labplan
c H e M ic A l cons U ltA nts
Corcoran Chemicals Limited
Hazchem Training Ltd
c H illed wAter
Actylis
Central Pump Supplies Ltd
Cross Technical Solutions
c H ro MAto G r APHy
Charles River Microbial Solutions
Fisher Scientific Ireland Ltd
Labplan
SK Pharmteco
cle A nroo M s
Charles River Microbial Solutions
Cross Technical Solutions
Fisher Scientific Ireland Ltd
KUKA Robotics Ireland Ltd
Ortec Inc.
Portakabin Ireland
cle A nin G services / e QU i PM ent
AQS Environmental Solutions
Portakabin Ireland
clinic A l rese A r c H or GA nis Ation
Charles River Microbial Solutions
cold c HA in PAck AG in G
Alexion
CRS Pharma Solutions

DHL Supply Chain
Kuehne + Nagel
Quitmann O’Neill
UPS Healthcare
cold c HA in cons U ltAtion
UPS Healthcare
co MP ressed A ir / co MP ressors
Ballinlough Pharma Solutions
co MPU ter syste M s
Charles River Microbial Solutions
Chemishield
Westbourne IT Global Services
Irish PharmaChem | Industry Buyers Guide 2023 104
condensors
Ballinlough Pharma Solutions
CPI Technology Ltd
Cross Technical Solutions
Flexachem Manufacturing Ltd
condition M onitorin G
AbsorboPak
Bonner
Charles River Microbial Solutions
Flexachem Manufacturing Ltd
Foltech Engineering Ltd
LotusWorks
Q1 Scientific
constr U c tion MA n AG e M ent
Portakabin Allspace
Tandem Project Management Ltd.
cons U ltA nc y
Hazchem Training Ltd
Reading Scientific Services Ltd
Tandem Project Management Ltd
content str Ate G y
TWi
contr Act de velo PM ent & M A n U fAct U rin G
Hovione Ortec Inc.
SK Pharmteco
contr Act de velo PM ent & M A rke tin G
Charles River Microbial Solutions
Hovione
contr Act PHA r M A services
Charles River Laboratories Ireland Ltd
Charles River Microbial Solutions
Eurofins Biopharma Product Testing
Hovione
Ortec Inc.
Pharmalex
Reading Scientific Services Ltd
control s U bstA nces conveyors
Tekpak Automation Ltd
coolin G syste M s
Ballinlough Pharma Solutions
Central Pump Supplies Ltd
CPI Technology Ltd
Cross Technical Solutions
CRS Pharma Solutions
dAtA AcQU isition
Bonner
Charles River Microbial Solutions
IDA Ireland
Labplan
de HUM idifiers
Cross Technical Solutions
CRS Pharma Solutions
desi G n
Ballinlough Pharma Solutions
Nelipak Healthcare Packaging
Pharmalex
Quitmann O’Neill
Tandem Project Management ltd
Tekpak Automation Ltd
dis P ersers
Fisher Scientific Ireland Ltd
distill Ation
CPI Technology Ltd
Fisher Scientific Ireland Ltd
Labplan
doc UM entAtion solU tions
Charles River Microbial Solutions
Kuehne + Nagel
TWi
dr A ins
AQS Environmental Solutions
Foltech Engineering Ltd
driers
CPI Technology Ltd
dr UM s / contA iners
AbsorboPak
CMS Chemstore Engineering Ltd
Complas Packaging Ltd
Corcoran Products Ltd
Interpac
National Chemical Company
Quitmann O’Neill
econo M ic de velo PM ent AG enc y IDA Ireland
ed U c Ation & tr A inin G
Charles River Microbial Solutions
CPI Technology Ltd
GS1 Ireland
Pharmalex
Reading Scientific Services Ltd
Science Foundation Ireland (SFI)
TWi
Westbourne IT Global Services
efflU ent M onitorin G / tre At M ent
Bonner
Carbon Group
electric A l
Portakabin Ireland
Tandem Project Management ltd.
electric A l co MP onents
Bonner
ener G y efficiency / MA n AG e M ent
Berkley Group
Bonner
Central Pump Supplies Ltd
Sustainable Energy Authority of Ireland
en G ineerin G services
Berkley Group
Bonner
Central Pump Supplies Ltd
Charles River Microbial Solutions
Chemishield
Endress & Hauser (Ireland) Ltd
LotusWorks
Tandem Project Management ltd
Tekpak Automation Ltd
environ M entA l cons U ltin G
Charles River Microbial Solutions
CMS Chemstore Engineering Ltd
Quitmann O’Neill
environ M entA l M onitorin G
Charles River Microbial Solutions
environ M entA l services / e QU i PM ent
AQS Environmental Solutions
Central Pump Supplies Ltd
Charles River Microbial Solutions
CMS Chemstore Engineering Ltd
GI Chemicals
O’Flynn Medical Ltd
Portakabin Ireland
Quitmann O’Neill
Source BioScience
evAP or Ators
Cross Technical Solutions
Fisher Scientific Ireland Ltd
Flexachem Manufacturing Ltd
Labplan
ex P losion P r oofin G
CMS Chemstore Engineering Ltd
Henley Forklift Group Limited
ex P losion P r otection / PA nels
BS&B Safety Systems Ltd
CMS Chemstore Engineering Ltd
CPI Technology Ltd
Henley Forklift Group Limited
extr U ders
BS&B Safety Systems Ltd
fAcility desi G n
ATG Scientific Ltd
Bonner
Pharmalex
Tekpak Automation Ltd
fAcilities MA n AG e M ent
AbsorboPak
AQS Environmental Solutions
Foltech Engineering Ltd
O’Flynn Medical Ltd
Quitmann O’Neill
fillin G e QU i PM ent
Ortec Inc.
Quitmann O’Neill
Tekpak Automation Ltd
filters
CPI Technology Ltd
Fisher Scientific Ireland Ltd
Flexachem Manufacturing Ltd
filtr Ation
Associated Chemicals Ltd
CPI Technology Ltd
Fisher Scientific Ireland Ltd
fire detection / P re vention / P r otection
BS&B Safety Systems Ltd
fl AM e A rresters
BS&B Safety Systems Ltd
Flexachem Manufacturing Ltd
flexco P l Ates
Holfeld Graphics
flow control
Bonner
CPI Technology Ltd
Endress & Hauser (Ireland) Ltd
Flexachem Manufacturing Ltd
flU id HA ndlin G
Central Pump Supplies Ltd
CPI Technology Ltd
Interpac
Labplan
ProSys Containment and Sampling Technology
Quitmann O’Neill
f UM e c UP boA rds
Fisher Scientific Ireland Ltd
Foltech Engineering Ltd
f U rn Aces
Fisher Scientific Ireland Ltd Scientific Instruments Ireland
GENERAL SUPPLIERS
Irish PharmaChem | Industry Buyers Guide 2023 105
GENERAL SUPPLIERS
GA s de tection
CMS Chemstore Engineering Ltd
Fisher Scientific Ireland Ltd
GA s s UPP ly
Corcoran Products Ltd
Scientific Instruments Ireland
GAUG es
Bonner
BS&B Safety Systems Ltd
Fisher Scientific Ireland Ltd
G ener Ators
Scientific Instruments Ireland
G l A sswA re
Associated Chemicals Ltd
CPI Technology Ltd
Fisher Scientific Ireland Ltd
Quitmann O’Neill
G rindin G
CPI Technology Ltd
Fisher Scientific Ireland Ltd
HAZA rdo U s wA ste dis P os A l in G redients
Chemishield
Indaver Ireland
Interpac
Quitmann O’Neill
H e A lt H c A re lo G istics
Kuehne + Nagel
H e A lt H & s A fety / first A id
Charles River Microbial Solutions
Hazchem Training Ltd
Tandem Project Management ltd.
H e At exc HA n G ers
BS&B Safety Systems Ltd
Central Pump Supplies Ltd
CPI Technology Ltd
Cross Technical Solutions
Flexachem Manufacturing Ltd
Labplan
H e Aters
Ballinlough Pharma Solutions
CMS Chemstore Engineering Ltd
H o M o G enisers
CPI Technology Ltd
Fisher Scientific Ireland Ltd
Flexachem Manufacturing Ltd
H oses
CPI Technology Ltd
HUM idity / HUM idifiers
AbsorboPak
Ballinlough Pharma Solutions
Bonner
Cross Technical Solutions
Interpac Source BioScience
HyG ienic di APH r AGM vA lves
Flexachem Manufacturing Ltd
inc U b Ators
Ballinlough Pharma Solutions
Charles River Microbial Solutions
Cross Technical Solutions
Fisher Scientific Ireland Ltd
ProSys Containment and Sampling Technology
in J ection M o U ldin G
Quitmann O’Neill
ins P ection e QU i PM ent
Bonner
Holfeld Graphics
O’Flynn Medical Ltd
Tekpak Automation Ltd
instr UM entAtion
ATG Scientific Ltd
Bonner
BS&B Safety Systems Ltd
Charles River Microbial Solutions
Endress & Hauser (Ireland) Ltd
Labplan
LotusWorks
Scientific Instruments Ireland it
Charles River Microbial Solutions
Westbourne Global IT Services
invest M ent
IDA Ireland
invest M ent P r o M otion AG enc y
IDA Ireland
isol Ators
Foltech Engineering Ltd
ProSys Containment and Sampling Technology
l A bellin G
CMS Chemstore Engineering Ltd
Tekpak Automation Ltd
l A b it
Westbourne Global IT Servicess UPP liers
l A bor Atory e QU i PM ent / s UPP liers
ATG Scientific Ltd
Bonner
Charles River Microbial Solutions
Chemishield
CMS Chemstore Engineering Ltd
Fisher Scientific Ireland Ltd
Labplan
Micro-Bio Ireland Ltd
O’Flynn Medical Ltd
Particular Sciences Ltd
Portakabin Ireland
ProSys Containment and Sampling Technology
Scientific Instruments Ireland
Solv-Echem Ireland Ltd
l A bor Atory M obile benc H es
ATG Scientific Ltd
l A bor Atory servi ces
Charles River Laboratories Ireland Ltd
CMS Chemstore Engineering Ltd
Eurofins Biopharma Product Testing
GI Chemicals
Nelipak Healthcare Packaging
Reading Scientific Services Ltd
Westbourne Global IT Services
li QU id fillin G & c APP in G
ATG Scientific Ltd
Tekpak Automation Ltd
lo G istics
AbsorboPak
AQS Environmental Solutions
Ballinlough Pharma Solutions
Charles River Laboratories Ireland Ltd
Chemco Ireland Ltd
DHL Supply Chain
Kuehne + Nagel
Portakabin Ireland
Quitmann O’Neill
Solv-Echem Ireland Ltd
UPS Healthcare
MA inten A nce
AQS Environmental Solutions
Bonner
CPI Technology Ltd
Cross Technical Solutions
Endress & Hauser (Ireland) Ltd
LotusWorks
Particular Sciences Ltd
Source BioScience
MA n U fAct U rers
A&C Your Global GMP Partner
Abbvie
Amneal
BS&B Safety Systems Ltd
Central Pump Supplies Ltd
Hovione
IDA Ireland
Micro-Bio Ireland Ltd
Portakabin Ireland Ltd
Quitmann O’Neill
Source BioScience
Tekpak Automation Ltd
MAteri A ls HA ndlin G /
forklfts / PA lle t tr U cks
AbsorboPak
Ballinlough Pharma Solutions
Henley Forklift Group Limited
Interpac
Portakabin Ireland
Toyota Material Handling Ireland Ltd
M ec HA nic A l en G ineerin G services
Berkley Group Central Pump Supplies Ltd
CPI Technology Ltd
Foltech Engineering Ltd
LotusWorks
Portakabin Ireland
Tandem Project Management ltd
Tekpak Automation Ltd
M ec HA nic A l & P r ocess en G ineerin G
Bonner
CPI Technology Ltd
Endress & Hauser (Ireland) Ltd
Foltech Engineering Ltd
LotusWorks
Tandem Project Management ltd.
M edic A l de vice MA n U fAct U re
B. Braun Medical
Charles River Microbial Solutions
LotusWorks
Mallinckrodt Pharmaceuticals
Ortec Inc.
Tekpak Automation Ltd
M e M br A ne filtr Ation syste M s
Microfiltration: Fisher Scientific Ireland Ltd
Nanofiltration: Fisher Scientific Ireland Ltd
Ultrafiltration: Fisher Scientific Ireland Ltd
Reverse osmosis: Fisher Scientific Ireland Ltd
M eters
CPI Technology Ltd
Fisher Scientific Ireland Ltd
Irish PharmaChem | Industry Buyers Guide 2023 106
GENERAL SUPPLIERS
M icro Q c
Charles River Microbial Solutions
Reading Scientific Services Ltd
M icrosco P es
Bonner
Fisher Scientific Ireland Ltd
Particular Sciences Ltd
M icrowAve tec H nolo G y
Scientific Instruments Ireland
M illin G
CPI Technology Ltd
Fisher Scientific Ireland Ltd
SK Pharmteco
M ixers
CPI Technology Ltd
Fisher Scientific Ireland Ltd
Flexachem Manufacturing Ltd
noise / odo U r control
AbsorboPak
Associated Chemicals Ltd
ATG Scientific Ltd
Flexachem Manufacturing Ltd
non -HA ZA rdo U s wA ste
dis P os A l/recovery
Indaver Ireland
non -HA ZA rdo U s wA ste
MA n AG e M ent
Indaver Ireland
non -HA ZA rdo U s wA ste
tre At M ent
Indaver Ireland
oe M MA n U fAct U rin G
B. Braun Medical
Foltech Engineering Ltd
IDA Ireland
PAck AG in G / blendin G U nder GMP
National Chemical Company
PAck AG in G / desi G n
Charles Tennant & Co Ltd
Complas Packaging Ltd
Holfeld Graphics
IDA Ireland
Interpac
Kuehne + Nagel
Limerick Packaging
Nelipak Healthcare Packaging
Quitmann O’Neill
Tekpak Automation Ltd
UPS Healthcare
PAck AG in G / MAc H inery
AbsorboPak
IDA Ireland
Interpac
NPP Group Ltd
Limerick Packaging
Nelipak Healthcare Packaging
Quitmann O’Neill
Smurfit Kappa Ireland
Tekpak Automation Ltd
PA llets
Ballinlough Pharma Solutions
Interpac
Quitmann O’Neill
Tekpak Automation Ltd
PA lletisin G/de PA lle tisin G
Tekpak Automation Ltd
PA rticle si Z in G s U rfAce A re A
Particular Sciences Ltd
Reading Scientific Services Ltd
PHA r MAce U tic A l fA bric Ation
Charles River Microbial Solutions
IDA Ireland
ProSys Containment and Sampling Technology
PHA r MAce U tic A l MA n U fAct U re Abbvie
Amneal
LotusWorks
Mallinckrodt Pharmaceuticals
SK Pharmteco
P ick & P l Ace MAc H ines
Tekpak Automation Ltd
PZ P es / cores
Quitmann O’Neill
Smurfit Kappa Ireland
P l A stic contA iners
Measom Freer
Interpac
Nelipak Healthcare Packaging
PrimePac Ltd
Quitmann O’Neill
P l A stic cores / t U bes
Quitmann O’Neill
Smurfit Kappa Ireland
P ne UMAtics
Flexachem Manufacturing Ltd
P owder HA ndlin G
AQS Environmental Solutions
Bonner
CPI Technology Ltd
Foltech Engineering Ltd
Interpac
ProSys Containment and Sampling Technology
Quitmann O’Neill
P ress U re M e A s U re M ent / switc H es / vessels
Bonner
BS&B Safety Systems Ltd
Central Pump Supplies Ltd
CPI Technology Ltd
Flexachem Manufacturing Ltd
P ress U re relief
BS&B Safety Systems Ltd
CPI Technology Ltd
Flexachem Manufacturing Ltd
P rint PAck AG in G
Limerick Packaging
Quitmann O’Neill
P rocess control
Bonner
BS&B Safety Systems Ltd
Charles River Microbial Solutions
O’Flynn Medical Ltd
Scientific Instruments Ireland
P rocess desi G n
Bonner
BS&B Safety Systems Ltd
Pharmalex
Tandem Project Management ltd.
P rocess & M ec HA nic A l en G ineerin G contr Actors
Central Pump Supplies Ltd
P ro J ect MA n AG e M ent
Bonner
Chemishield
Pharmalex
Reading Scientific Services Ltd
Tandem Project Management Ltd
P rotective clot H in G /
APPA r At U s
O’Flynn Medical Ltd
ProSys Containment and Sampling Technology
PUMP s
Central Pump Supplies Ltd
CPI Technology Ltd
Fisher Scientific Ireland Ltd
Flexachem Manufacturing Ltd
Quitmann O’Neill
QUA lity & co MP li A nce
AbsorboPak
Charles River Microbial Solutions
Chemifloc Ltd
LotusWorks
Pharmalex
ProSys Containment and Sampling Technology
Reading Scientific Services Ltd
SK Pharmteco
Westbourne Global IT Services
r&d
Almac Sciences Ltd
ATG Scientific Ltd
Charles River Microbial Solutions
Chemifloc Ltd
IDA Ireland
Pharmaceutical Manufacturing Technology
Centre (PMTC)
ProSys Containment and Sampling Technology
Reading Scientific Services Ltd
SK Pharmteco
Synthesis and Solid State Pharmaceutical Centre
re Actors
CPI Technology Ltd
Flexachem Manufacturing Ltd
recr U it M ent
Berkley Group
Chemishield
ICDS Recruitment Consultants
Tandem Project Management ltd.
refri G er Ation / free Z in G
Ballinlough Pharma Solutions
Central Pump Supplies Ltd
Cross Technical Solutions
CRS Pharma Solutions
Fisher Scientific Ireland Ltd
Q1 Scientific
Source BioScience
Irish PharmaChem | Industry Buyers Guide 2023 107
GENERAL SUPPLIERS
renewA ble ener G y
Central Pump Supplies Ltd
Sustainable Energy Authority of Ireland
rese A rc H f U ndin G
Pharmaceutical Manufacturing Technology
Centre (PMTC)
Science Foundation Ireland (SFI)
res P ir Atory PHA r M Ace U tic A ls
Reading Scientific Services Ltd
robotics
Charles River Microbial Solutions
KUKA Robotics Ireland Ltd
Labplan
Tekpak Automation Ltd
s A nitA ry t U bin G
CPI Technology Ltd
Flexachem Manufacturing Ltd
sc A dA /dcs / M is
Bonner
ProSys Containment and Sampling Technology
Tekpak Automation Ltd
scr U bbers
Flexachem Manufacturing Ltd
se A ls & GA ske ts
Central Pump Supplies Ltd
Flexachem Manufacturing Ltd
sievin G
Fisher Scientific Ireland Ltd
Particular Sciences Ltd
softwA re
Ballinlough Pharma Solutions
Charles River Microbial Solutions
Chemishield
CMS Chemstore Engineering Ltd
Westbourne Global IT Services
solvent recovery / services
Carbon Group
CPI Technology Ltd
stA bilit y stor AG e
Almac Sciences Ltd
ATG Scientific Ltd
Ballinlough Pharma Solutions
Charles River Laboratories Ireland Ltd
Charles River Microbial Solutions
CMS Chemstore Engineering Ltd
Corcoran Products Ltd
Cross Technical Solutions
CRS Pharma Solutions
Dawsongroup | TCS Ireland
Eurofins Biopharma Product Testing
Kuehne + Nagel
Q1 Scientific
Reading Scientific Services Ltd
SK Pharmteco
Source BioScience
stA bilit y tests
Charles River Laboratories Ireland Ltd
Eurofins Biopharma Product Testing
Ortec Inc.
Particular Sciences Ltd
Reading Scientific Services Ltd
SK Pharmteco
stA inless steel / fittin G s / P r od U c ts
CMS Chemstore Engineering Ltd
CPI Technology Ltd
Flexachem Manufacturing Ltd
Foltech Engineering Ltd
Henley Forklift Group Limited
Interpac
ProSys Containment and Sampling Technology
Quitmann O’Neill
ste AM e QU i PM ent
BS&B Safety Systems Ltd
CPI Technology Ltd
Flexachem Manufacturing Ltd
Foltech Engineering Ltd
sterility testin G
Charles River Laboratories Ireland Ltd
Charles River Microbial Solutions
Eurofins Biopharma Product Testing
Reading Scientific Services Ltd
Source BioScience
stor AG e / b U ndin G
Ballinlough Pharma Solutions
CMS Chemstore Engineering Ltd
Charles River Microbial Solutions
CRS Pharma Solutions
Dawsongroup | TCS Ireland
Interpac
Kuehne + Nagel
Quitmann O’Neill
stor AG e of HAZ A rdo U s
MAteri A ls
CMS Chemstore Engineering Ltd
Corcoran Products Ltd
CRS Pharma Solutions
Dawsongroup | TCS Ireland
Hazchem Training Ltd
Indaver Ireland
Kuehne + Nagel
str APP in G e QU i PM ent
AbsorboPak
s UPP ly c HA in MA n AG e M ent
AbsorboPak
Alexion
Ballinlough Pharma Solutions
Central Pump Supplies Ltd
Chemco Ireland Ltd
DHL Supply Chain
GS1 Ireland
IDA Ireland
Kuehne + Nagel
KWE (Ireland) Ltd
Limerick Packaging
National Chemical Company
Portakabin Ireland
Quitmann O’Neill
Solv-Echem Ireland Ltd
s U rfAce P l A so M on reson A nce
ATG Scientific Ltd
tA ble tin G e QU i PM ent
ATG Scientific Ltd
Flexachem Manufacturing Ltd
tA nks
Celtic Forwarding Ltd
Central Pump Supplies Ltd
Complas Packaging Ltd
Flexachem Manufacturing Ltd
Quitmann O’Neill
te MP er At U re control
Ballinlough Pharma Solutions
Bonner
CMS Chemstore Engineering Ltd
Corcoran Products Ltd
Cross Technical Solutions
CRS Pharma Solutions
Dawsongroup | TCS Ireland
DHL Supply Chain
Fisher Scientific Ireland Ltd
Flexachem Manufacturing Ltd
KWE (Ireland) Ltd
Labplan LotusWorks
Q1 Scientific
Source BioScience
testin G services
Almac Sciences Ltd
Anecto CPI Technology Ltd
ATG Scientific Ltd
Bonner
Charles River Laboratories Ireland Ltd
Charles River Microbial Solutions
Chemifloc Ltd
CMS Chemstore Engineering Ltd
Eurofins Biopharma Product Testing
Reading Scientific Services Ltd
SK Pharmteco
t H er M A l i M AG in G /
t H er M o G r APHy
Ballinlough Pharma Solutions
Bonner
Reading Scientific Services Ltd
tools
Charles River Microbial Solutions
tr A inin G
Hazchem Training Ltd
Reading Scientific Services Ltd
TWi
tr A ns P ort & lo G istics
AbsorboPak
AQS Environmental Solutions
Ballinlough Pharma Solutions
Celtic Forwarding Ltd
CRS Pharma Solutions
Dachser Ireland Ltd
DHL Supply Chain
Hazchem Training Ltd
Kuehne + Nagel
KWE (Ireland) Ltd
Quitmann O’Neill
Skycell AG
UPS Healthcare
tr Ay H e At se A ler
Nelipak Healthcare Packaging
t U be se ts / dis P os A bles
Quitmann O’Neill
vAccines
Ballinlough Pharma Solutions
MSD Ireland
vAc UUM syste M s
BS&B Safety Systems Ltd
CPI Technology Ltd
Fisher Scientific Ireland Ltd
Flexachem Manufacturing Ltd
Particular Sciences Ltd
Irish PharmaChem | Industry Buyers Guide 2023 108
vA lves
Bonner
BS&B Safety Systems Ltd
CPI Technology Ltd
Flexachem Manufacturing Ltd
Foltech Engineering Ltd
vA lidAtion
Almac Sciences Ltd
Bonner
Charles River Microbial Solutions
Chemishield
CRS Pharma Solutions
Dawsongroup | TCS Ireland
LotusWorks
Pharmalex
Reading Scientific Services Ltd
SK Pharmteco
Source BioScience

Tandem Project Management ltd
Tekpak Automation Ltd
Westbourne IT Global Services
ventil Ation
Cross Technical Solutions
vision syste M s
KUKA Robotics Ireland Ltd
Particular Sciences Ltd
Tekpak Automation Ltd
wA re H o U se MA n AG e M ent
Celtic Forwarding Ltd
CMS Chemstore Engineering Ltd
Complas Packaging Ltd
Henley Forklift Group Limited
Kuehne + Nagel
Portakabin Ireland
UPS Healthcare
wA ste MA n AG e M ent /
b A lers / recyclin G
AQS Environmental Solutions
Indaver Ireland
Quitmann O’Neill
wAter for in J ec tion
A&C Your Global GMP Partner
Central Pump Supplies Ltd
National Chemical Company
wAter tre At M ent
Bonner
BS&B Safety Systems Ltd
Central Pump Supplies Ltd
Charles River Microbial Solutions
Chemco Ireland Ltd
Chemifloc Ltd
Flexachem Manufacturing Ltd
GI Chemicals
InOpSys
Portakabin Ireland
wei GH in G
Bonner
Fisher Scientific Ireland Ltd
Tekpak Automation Ltd
workwe A r
O’Flynn Medical Ltd
workwe A r M A n AG e M ent
dis P ensin G MAc H ine
O’Flynn Medical Ltd
GENERAL SUPPLIERS
Irish PharmaChem | Industry Buyers Guide 2023 109
COMPANY LISTINGS
A bbvie
Address: ABBVIE Sligo – Manorhamilton Road.
tel: (071) 913 6600
Address: ABBVIE Cork - IDA Business & Technology Park, Carrigtohill, Co. Cork.
tel: (021) 488 1400
business: Pharmaceutical.
AbsorboPA k ltd
Address: 6 Main Street, Howth, Dublin, D13P2C1, Ireland.
tel: +353 (1) 6978733
Alexion, Astr A Zenec A
rA re d ise A se
Address: College Business & Technology Park, Blanchardstown, Dublin 15, D15 R925.
tel: (01) 254 6400
ANNA LIVING WITH HPP
email: julie.carney@alexion.com
web: www.alexion.com
business: Pharmacuetical.

contact: Site Operations Coordinator: Julie Carney
AQ s envir on M entA l solU tions
Address: Castletown, Galmoy (via Thurles), Co. Kilkenny.
tel: +353 (0)504 57800
freephone: 1800 500 020


email: info@aqssolutions.ie
web: www.aqssolutions.ie
business: Provider of drainage, industrial cleaning, waste management and processing services.
contact: Commercial Director: Stan O’Reilly
ciences ltd.
erly b io c lin r ese A rc H tories )
IDA Technology & Business Park, Garrycastle, Athlone, eland, N37 X061. +353 (0)90 646 0200 +353 (0)90 646 0210 almacanalytical@almacgroup.com ww.almacgroup.com
A rr A n c H e M ic A l co MPA ny
Address: Monksland Industrial Estate, Athlone, Co. Roscommon, N37 DN24, Ireland.
tel: +353 (0) 90 644 5700
email: info@arranchemical.ie
web: www.arranchemical.ie
inspiration and our Guiding Star.
Analytical ser vices provider in GMP / GLP environments across UK, Europe and US with significant experience in the analysis of small, large and bio logic molecules. Our state of the art labs support drug substance (API), drug product (finished product) analytics across all phases of clinical development and into commercial elease.
Business Development: Chris Merrick
tel: (061) 574 404
email: biopharma@actylis.com
web: www.actylis.com
business: Actylis is a global GMP manufacturer of Excipients, APIs and PIs, Process and Cleaning Solutions, Buffers, Cell Culture Ingredients, Amino Acids & Cell and Gene Therapy Ingredients.

contact: biopharma@actylis.com
AM ne A l irel A nd
li M ited
Address: Cashel Road, Cashel, Co. Tipperary.
tel: +353 (0) 62 27000
email: careers.cashel@amneal.com

web: www.amneal.com/cashel
business: Pharmaceutical Manufacture.
contact: VP Operations, Ireland: Niall Prendergast
business: Fine chemical company specialising in the manufacture of products for Pharma, Healthcare, Flavour/ Fragrance & other specialised chemicals & industrial applications.
contact: Business Development Manager: Gareth Maguire.
A ssoci Ated c H e M ic A ls ltd
Address: 16D Euro Business Park, Little Island, Co. Cork, Ireland.
tel: +353 (0) 21 4351014
fax: +353 (0) 21 4351015
email: info@acl.ie
web: www.acl.ie
business: Chemical Suppliers.
contact: Managing Director: Sylvester Cotter
A
transform the lives of people affected by rare diseases and devasdevelopment and delivery of innovative medicines, as well as and healthcare services. alexion.com
PANTONE GREEN 361c PANTONE BLACK CMYK GREEN: c: 78.8 m:11.5 y: 100 k:1.5 CMYK BLACK: K 100% RGB GREEN: r: 52 g: 160 b: 44 RGB BLACK: r: 35 g: 31 b: 32 HEX GREEN: #34A02C Font: Myriad Pro arran CHEMICAL COMPANY LTD A Member of the Almac Group
Irish PharmaChem | Industry Buyers Guide 2023 110
AtG s cientific ltd
Address: Oxford Centre for Innovation, New Road, Oxford, OX1 1BY, United Kingdom.
tel: +44 (0) 1865 261423
email: enquiries@atgscientific.co.uk
web: www.atgscientific.co.uk
business: Supply of Laboratory Products and Equipment Solutions.
contact: Andrew Graham
berkley G r o UP
Address: dublin: 509 The Capel Building, Mar y’s Abbey, Dublin 7. cork: Mill House, Carrigrohane, Co. Cork. international offices: Singapore, London & Dubai.
tel: (01) 872 4666 (021) 428 9600
email: sgreenwood@Berkley-group.com
web: www.berkley-group.com
b on n er
bs&b s A fe ty syste M s ltd
Address: Raheen Business Park, Limerick, Ireland V94 N4V2.
tel: (061) 484 700
fax: (061) 304 774
email: sales@bsb.ie
web: www.bsbsafety.com
A Z elis i rel A nd l i M ited
Address: Unit 23, Sandyford Office Park, Blackthorn Avenue, Sandyford Industrial Estate, Foxrock, Dublin D18 X9X7.
tel: (01) 295 6977
fax: (01) 295 8338
email: graeme.locke@azelis.ie

business: Chemical Distributor.
contact: Managing Director: Graeme Locke
b
bA llinlo UGH P HA r M A s olU tions
Address: Citywest, Dublin, Annacarton Bridge, Co. Cork & Ballinlough, Co. Roscommon.
tel: Dublin (01) 460 0322
Cork (021) 488 2077
Roscommon (094) 964 0045
email: info@brltd.ie
web: www.brltd.ie
business: Suppliers of Thermo King Pharma Transport Refrigeration.

Sales - Service - Parts
contact: Joe Malone
bA rent Z i rel A nd ltd
Address: Block S, Grants View, Greenogue
Business Park, Rathcoole, Co. Dublin.
tel: +353 1 4039518
fax: +353 1 4039519
email: pharmaireland@barentz.com
web: www.barentz.com
business: Distributor of excipients, amino acids and APIs to the Pharmaceutical, Nutraceutical & Biopharma industries in Ireland.

contact: Sales Manager: Storme Delaney
i nstrUM entAtion, c A libr Ation A nd control s olU tions
Address: 35 Western Parkway Business Centre, Ballymount Drive, Ballymount, Dublin 12.
tel: (01) 450 5050
fax: (01) 450 5183
email: contact@bonner.ie
web: www.bonner.ie
business: Instrumentation, Calibration and Control Solutions including analysis, maintenance, temperature mapping and automation systems.
Instrumentation product sales from international manufacturers.
contact: Managing Director: Patrick M Bonner
Ser vice Manager: Roddy Jefferson Control Solutions: Vernon Smit
b. b r AU n M edic A l
Address: 3 Naas Road Industrial Park, Dublin 12.
tel: (01) 709 1800
email: robert.bannon@bbraun.com
web: www.bbraun.ie
business: OEM manufacturing.

contact: Sales Consultant: Rober t Bannon
business: Design, manufacture and supply of Pressure Relief Devices such as rupture disks, safety heads, custom engineered products, explosion vents, flame arresters, breather valves, safety valves and more.
contact: Regional Sales Manager: Patrick Murphy
cA ll AGHA n | red
e n G ineerin G
Address: Sobo Works, 2 Windmill Lane, Sir John Rogerson's Quay, Dublin Docklands, Dublin 2, D02 K156.
tel: (01) 661 4420
email: gmail@calleng.ie
web: www.calleng.ie
business: Engineering & Project Management Company.
contact: Director: Killian O'Neill
c AM idA ltd
Address: New Quay, Clonmel, Co. Tipperary, E91 YV66, Ireland.
tel: +353 52 6125455
fax: +353 52 6125466
Building 1000, Units 1201& 1202, City Gate, Mahon, Cork.
Contact:
brenntAG ireLAnd
b renntAG i rel A nd
Address: Unit 405, Greenogue Business Park, Rathcoole, Dublin 24.
tel: +353 (0) 1 401 3500
Address: Unit 405, Greenogue Business Park, Rathcoole, Dublin 24.
fax: +353 (0) 1 401 3599
Tel: (01) 401 3500
email: dublin.sales@brenntag.ie
Fax: (01) 405 3501
web: www.brenntag.ie
Email: dublin.sales@brenntag.ie
business: Chemical Suppliers & Distributors.


Web: www.brenntag.ie

Contact: Sales Desk
contact: Evelyn O'Connor: evelyn.o'connor@brenntag.ie
Cole Carroll: colman.carroll@brenntag.ie
Tel: (021) 240 9099
email: info@camida.com
web: www.camida.com
Fax: (021) 240 9009
ceLtic Address:
Email: mail@calleng.ie
contact: Company Secretary: Deirdre McGrath
Web: www.calleng.ie
c A r A PA rtners
Address: Little Island Industrial Estate, County Cork.
Business: Multi-discipline consulting engineering and project managment company.
tel: (021) 4520500
email: mkirk@carapartners.ie
cAmidA Ltd
business: Pharmaceuticals.
contact: Site Head: Michael Kirk
Address: Tower House, New Quay, Clonmel, Co. Tipperary.
Tel: (052) 612 5455
Fax: (052) 612 5466
2012
IrIsh
Tel: (01) 865 6000 Fax: (01) 874 6745 Email: Web:
c
Irish PharmaChem | Industry Buyers Guide 2023 111
COMPANY LISTINGS
c A rbon G r o UP
Address: Ringaskiddy, Co. Cork, P43 R772.
tel: +353 (0)21 437 8988
Mobile: +353 (0) 86 2612 485
fax: +353 (0)21 437 8950
email: carol.deegan@carbon.ie sales@carbon.ie
web: www.carbon.ie
business: Pharma/biopharma chemicals.
contact: Area Sales Manager: Carol Deegan
cHA rles r iver Microbi A l s olU tions i ntern Ation A l
Address: 49, Greenogue Business Park, Jordanstown Ave, Jordanstown, Rathcoole, Co. Dublin, D24 NF21, Ireland.
email: askcharlesriver@crl.com
web: criver.com/microbial
business: Micro QC.
cHA rles t enn A nt & co ltd
Address: Unit J, Aerodrome Business Park, Co. Dublin.
tel: (01) 451 4099
fax: (01) 451 4702
email: info@ctennant.ie
web: www.charlestennant.com
c entr A l P UMP sUPP lies
Address: Unit 21, Primeside Park, Kilshane Way, Ballycoolin, Dublin15.
tel: (01) 861 2326
email: info@centralpumpsupplies.com
web: www.centralpumpsupplies.com

business: Appliances, Electrical, and Electronics Manufacturing.
contact: Sales/Digital Marketing Assistant: Beatriz
Baldiviezo
certific Ation e U ro P e l i M ited
Address: Block 20A, Beckett Way, Park West Business Park, Dublin 12, D12 P8R2.
tel: (01) 642 9300
email: sales@cer tificationeurope.com

web: www.certificationeurope.com
business: ISO Management Standards
Cer tification body for ISO 9001, 14001, 45001, 50001, 27001, 22301 and 20000-1.
contact: Rob Lyons, Sales and Marketing Manager
cHA rles r iver
lA bor Atories i rel A nd ltd
Address: Carrentrila, Ballina, Co. Mayo, F26 D786, Ireland.
email: askcharlesriver@crl.com
web: criver.com/biologics
business: Biologics Testing Solutions.
business: Chemical and Packaging supplier
cH e M is H ield
Address: Arc Labs, Carriganore, Waterford.
tel: +353 (0)51 576 025
email: info@theaphexgroup.com
web: www.chemishield.com
business: Software & Life Sciences Consultancy.

contact: Commerical Director: James Steele
cMs cH e M store e n G ineerin G ltd.

Address: Clondrinagh Industrial Estate, Ennis Road, Limerick, V94 XT27.
tel: (061) 327 792
email: sales@chemstore.ie
web: www.chemstore.ie
business: Solutions provider for the safe storage and management of Hazardous Materials.
co M -P l A s intern Ation A l
Address: Southern Link Business Park, Naas, Co. Kildare.
tel: (045) 874 088/9
fax: (045) 874 090
email: sales@complas.ie
web: www.complas.ie
cH e M co i rel A nd l i M ited
Address: Unit 2, Stadium Business Park, Ballycoolin, Cappagh, Dublin 11, D11 X205.
tel: +353 (0)1 829 3600
fax: +353 (0)1 885 5029
email: info@chemco.ie
web: www.chemco.ie
corcor A n c H e M ic A ls ltd


Address: 17 Parkgate Street, D08 NRP2.
tel: (01) 633 0400
fax: (01) 679 3521
email: info@corcoran-group.com
web: www.corcoran-group.com
business: Distributors of raw materials for the food, pharmaceutical, polymer & chemical industry
contact: Sales
corcor A n P r od U c ts ( irl ) ltd
Address: Unit 12, Northern Cross Business Park, Finglas, D11 DC67.
tel: (01) 864 4422
email: info@corcoran-group.com
cH e M
ifloc
Gro UP: cH e M ifloc, G i cH e M ic A ls, cH e M il A bs
Address: Smithstown Ind Est, Shannon, Foynes Port, Limerick.
tel: 061 708699; 069 65318 (GI)
fax: +353 61 708653
email: info@chemifloc.ie info@gichemicals.ie
web: chemifloc.ie; gichemicals.ie
business: Chemifloc: Water Treatment

GI: Industrial Chemicals Chemilab: Technical Services

contact: Gar y Palmer, Business Development
web: www.corcoran-group.com
business: Suppliers of packaging to the food, pharmaceutical and chemical industry
contact: Derek Lennon
c P l
Address: Ground Floor, One Haddington Buildings, Haddington Road, Dublin 4, D04 X4C9
tel: (01) 614 6000
email: hello@talentevolutiongroup.com
web: www.cpl.com/ie
business: Specialised talent and recruitment solutions company.

COMPANY LISTINGS
lt d
Irish PharmaChem | Industry Buyers Guide 2023 112
c P i tec H nolo G y ltd
Address: 1-5 Eastgate Drive, Eastgate Retail Park, Little Island, Co. Cork, T45 A433.
tel: (021) 487 4142
fax: (021) 487 8764
email: info@cpitechnology.com
web: www.cpitechnology.com
business: Providers of Process Equipment.
contact: Managing Director: Adrian Giltinan
dAc H ser i rel A nd ltd
Address:
cross tec H nic A l solU tions
Address: 9/10 Broomhill Road, Tallaght, Dublin 24.
tel: (01) 405 6777
fax: (01) 413 6932
email: sales@ctsolutions.org
web: www.crosstechnicalsolutions.ie
business: Refrigeration.
contact: Technical Director: Jonathan McGrath
General Manager: Jason Keating
crs P HA r M A s olU tions
Address: Dublin, Belfast, London, Manchester.
tel: +353 46 943 5000
locall: 0818 929 824
email: info@crspharmasolutions.ie
web: www.crspharmasolutions.ie
business: Temperature controlled storage solutions, chamber temperatures range from -70°C to +60°C.
Close control temperature and humidity stores, ICH stability chambers, incubators, Atex cold stores, dual redundant cooling systems with integral back-up generators, blast freezers, freezers for fast freezing of phase change materials
(Eutectic plates and gel packs).
contact: Technical Director: Patrick Tyrrell, 086 849 4836

Blackchurch Business Park, Rathcoole, Co. Dublin, D24 C796.
tel: +353 1 401 3333
email: dachser.ireland@dachser.com
web: www.dachser.ie
business: Founded in 1930, DACHSER is a global market leader in logistic services with a revenue of €7.1 billion. With our comprehensive European road transport network of system and charter service, as well as a homogeneous structure of branches, subsidiaries and partner companies, we will support you in fulfilling your logistics requirements reliably, cost-effectively and on time. We transport your groupage, your full or partial loads and manage your procurement and distribution, both Europe-wide and national, to the highest level
endress+HAU
( irel A nd ) ltd.
ser
Address: Exchequer House, Embassy Office Park, Kill, Co. Kildare.
tel: (045) 989 200
email: info.ie.sc@endress.com
web: www.ie.endress.com
business: Leading supplier of products, services and solutions for industrial process measurement and automation industry.

contact: Sales Manager: Brian O’Connell
eU rofins b ioP HA r MA
Prod U c t t estin G
Address: Clogherane, Dungar van, Co. Waterford, X35 T628, Ireland.
tel: +353 (0) 58 48300
email: EurofinsBPT-IE@eurofins.ie
web: www.eurofins.ie/biopharma-services

dAwson G r o UP | tcs i rel A nd
Address: Unit JB, Beech Avenue, Naas Enterprise Park, Newhall, Naas, Co. Kildare.
tel: (045) 448 810
email: susanconroy@dawsongroup.ie
web: www.dawsongroup.ie

business: Temperature Controlled Solutions.
contact: Managing Director: Susan Conroy
f


IrIsh
fis H er scientific
fisher scientific
irel A nd ltd
d H l sUPP ly cHA in
Address: Unit B1 Horizon Logistics Park, Harristown, Co Dublin, K67 N5C3.
tel: 086 0665865
email: john.halpin@dhl.com
web: www.dhl.com/gb-en/home/ our-divisions/supply-chain.html

business: Supply Chain & Logistics.
contact: Business Development Manager, Life Sciences: John Halpin
Address: 3rd Floor, Kilmore House, Park Lane, Spencer Dock Dublin 1, D01 YE64.
tel: (01) 885 5854
fax: (01) 899 1855
Address: Suite 4, Plaza 212, Blanchardstown Corporate Park 2, Ballycoolin, Dublin 15.
Tel: (01) 885 5854
email: fsie.sales@thermofisher.com
web: www.ie.fishersci.com
Fax: (01) 899 1855
Email: fsie.sales@thermofisher.com

Web: www.ie.fishersci.com
business: Laboratory supplies, Chemicals, Consumables, Reagents, Equipment & Instruments.
Business: Laboratory supplies.
contact: Por tfolio Manager: Gerry Fitzmaurice
Contact: Marketing Manager: Gerry Fitzmaurice
fLexAcheM MAnufActurinG Ltd
d
e
Donnybrook Commercial Centre, GoLiAth systeMs Address: Tel: Fax: Email: Web: Business: Contact: GouLdinG Address: Tel: Fax:
COMPANY
Irish PharmaChem | Industry Buyers Guide 2023 113
LISTINGS
flexAc H e M
MA n U fAct U rin G ltd
Address: Donnybrook Commercial Centre, Douglas, Cork, T12 X68Y.
tel: (021) 461 7200
email: sales@flexachem.com
web: www.flexachem.com
business: Mechanical Process Equipment Supplier - Pumps, Seals, Valves, Process Equipment, Biotech and Pharma Equipment and Technical Suppor t.
contact: Commercial Manager: Michael Bradley
f oltec H e n G ineerin G ltd
Address: The Store House, Charleston Maltings, Midleton, Co. Cork.
tel: (021) 463 9592
email: info@foltech.ie
web: www.foltech.ie
business: Mechanical Engineering.
contact: Director: John Foley
G s1 i rel A nd
Address: Second Floor, The Merrion Centre, Nutley Lane, Donnybrook, Dublin 4.
tel: (01) 208 0660
fax: (01) 208 0670
email: healthcare@gs1ie.org
web: www.gs1ie.org/healthcare
business: Global Supply Chain Standards Body.
H eteroc H e M dist ltd
Address: Unit 49, Rober tson House, Baldoyle Industrial Est., Dublin 13.
tel: (01) 839 3127
email: info@heterochem.com
web: www.heterochem.com
business: Chemical Distributors & Raw Material Specialists.
contact: Managing Director: Kim Doran k im@heterochem.com
Holfeld Gr APH ics
Address: Unit 3, Jamestown Industrial Estate, Kylemore Way, Dublin, D08 PF1C.
tel: (01) 285 5233
email: customercare@holfeldgraphics.com
web: www.holfeldgraphics.com
business: Manufacturer of Flexo plates for Hapa Blister printers, Agents for Axicon, ISO Barcode Verifiers (GS1 128, GS1 Datamatrix, etc.,)
Hovione ltd
G reenfield G lob A l
Address: IDA Business & Technology Park, Mountrath Road, Portlaoise, Co. Laois.
tel: +353 (0) 57 8671400
email: Por tlaoise.info@greenfield.com
web: www.greenfield.com

business: Excipients, Buffer Solutions and CIP Solutions producer.

contact: Business Development Manager: Johnny Geraghty
G r AHAM HA rt (P r ocess tec H nolo G y ) ltd
Address: Friars Industrial Estate, Bradford Road, Idle, Bradford, BD10 8SX, UK.
tel: (0044) 1274 617021
fax: (0044) 1274 618614
email: post@graham-hart.com
web: www.graham-hart.com
HAZc H e M tr A inin G ltd
Address: G10, Maynooth Business Campus, Maynooth, Co. Kildare.
tel: (01) 629 1800
fax: (01) 629 1822
email: info@hazchem.ie


web: www.hazchem.ie
business: Training and Consultancy Ser vices.
contact: Manager: Michelle Cleere
H enley forklift G r o UP li M ited
Address: Henley Industrial Park, Killeen Road, Dublin 10.
tel: (01) 620 9200
web: www.henley.ie/pharma
business: Forklift and warehousing equipment, sales, service, hire, parts, driver training, thorough examinations.
contact: Director: Brian O’Connell boconnell@henley.ie
Address: Loughbeg, Ringaskiddy, Co. Cork, Ireland.
tel: +353 21 451 2856
fax: +353 21 437 8697
email: hello@hovione.com
web: www.hovione.com
contact: General Manager: Dr. Paul Downing
H U bbc At
Address: Block 2, Newtown & Business Enterprise Park, Newtownmountkennedy, Co. Wicklow.
tel: +353 89 700 3476
email: niall.otoole@hubbcat.com

business: Telecommunications.
contact: COO: Niall O' Toole
icds r ecr U it M ent cons U ltA nts
Address: Connacht House, 24 Upper Fitz william Street, Dublin 2.
tel: +353 1 632 1200
email: info@icds.ie
web: www.icds.ie
business: Specialist Recruitment Consultants to the Pharmaceutical, Life Science, Chemical, Medical Device, Food and Technology sectors.
COMPANY LISTINGS
G
H
i
Irish PharmaChem | Industry Buyers Guide 2023 114
idA irel A nd
Address: Three Park Place, Hatch Street Upper, Dublin 2.
tel: (01) 603 4000
email: idaireland@ida.ie
web: www.idaireland.com
business: Investment Promotion & Development Agency.
invest nort H ern irel A nd
Address: Bedford Square, Bedford Street, Belfast, BT2 7ES.
tel: (0044) 800 181 4422
email: patricia.oneill@investni.com
web: www.investni.com
business: Economic development agenc y.
k
kU
e H ne + nAG el irel A nd
Address: Unit D2 Horizon Logistics Park, Harristown, Swords, Co. Dublin, K67 A5W6.
tel: (01) 823 9777
email: Seamus.keane@kuehne-nagel.com

web: ie.kuehne-nagel.com
indAver irel A nd
Address: The Highline, 1st Floor, Bakers Point, Pottery Road, Dun Laoghaire, Co. Dublin, A96 KW29.
tel: (01) 697 2900
fax: (01) 633 5464
email: info@indaver.ie

web: www.indaver.ie
business: Hazardous & nonhazardous waste disposal and recovery ensuring full compliance.
business: Global Freight Forwarding & Supply Chain Management.
contact: Seamus Keane, National Business Development ManagerHealthcare Mob: +353 85 8666646
k U k A r obotics i rel A nd lt d.
Address: Unit 16, Brewery Business Park, Ardee Rd, Cambrickville, Dundalk, Co. Louth, A91 ATX4, Ireland.
tel: (042) 939 5034
email: sales.ie@kuka.com

web: www.kuka.com
business: Industrial robotics & automation.
ino P sys nv
Address: Maanstraat 9B, 2800 Mechelen, Belgium.
tel: +32495653821
email: thomas.windels@inopsys.eu

web: www.inopsys.eu
business: Providing circular side stream solutions. Purifying water and recovering materials with mobile & modular installations
contact: Sales Manager: Thomas Windels inter
PAc
Address: 67E Heather Road, Sandyford Industrial Estate, Sandyford, Dublin D18 NV90.
tel: (01) 294 0600
fax: (01) 294 0602
email: ian@interpac.ie
web: www.interpac.ie

business: Supplier of packaging to the pharmaceutical, hazardous waste, food and dairy industries.

contact: Director: Ian Sutton
lennox l A bor Atory
s UPP lies ltd
Address: John F. Kennedy Drive, Naas Road, Dublin, D12FP79.
tel: (01) 460 7600
email: padraig.callan@lennox.ie
web: www.lennox.ie
contact: Padraig Callan, Head of Business Development
li M erick PAck AG in G
Address: Eastlink Business Park, Ballysimon Rd., Limerick.
tel: (061) 400 035
email: info@lmkpkg.ie
web: www.limerickpackaging.ie
business: Pack aging manufacturers, Distributors, Designers and Auditors.
contact: Sales Director: Mike Boland
lister MAc H ine
tools ltd
Address: PO Box 838, Bluebell Industrial Estate, Dublin 12.
tel: (01) 450 8866
fax: (01) 450 9836
email: sales@listermachinetools.com
web: www.listermachinetools.com
business: Supply of machine tools and ancilliary equipment, service and support
contact: Sales: Ryan McGrath
contact: Managing Director KUKA IE: Brian Cooney
kwe ( i reland) ltd
GDP Wholesale Licence Holder
Dublin Head Office & Temperature Controlled Warehouse Facility
Address: Horizon Logistics Park, Harristown, Swords, Co. Dublin.
tel: (01) 823 9600
fax: (01) 836 1111
email: kwedub@kwe.com
web: www.kwe.com
Cork Regional Office & Warehouse Facility
Address: South Ring West Business Park, Tramore Road, Cork.
tel: (021) 497 5722
fax: (021) 497 5727
email: kweork@kwe.com
l A b P l A n
Address: Allenwood Enterprise Park, Allenwood, Naas, Co Kildare.

tel: (045) 870 560
fax: (045) 870 811
email: info@labplan.ie
web: www.labplan.ie
business: Lab supplier of analytical instrumentation, services, technical suppor t.
lot U s w orks
Address: Building 3, Finisk lin Business Park, Sligo, F91 KAP2.
tel: (071) 916 9783
email: contactus@lotusworks.com
web: www.lotusworks.com
business: Engineering & Technical Solutions Provider.
MAcl Ac H l A n & don A ldson
Address: Unit 10, 4075 Kingswood Road, Citywest Business Campus, D24
tel: (01) 676 3465
fax: (01) 661 2083
email: mail@maclachlan.ie
web: www.maclachlan.ie
business: Intellectual Property Attorneys.
contact: Dr. Yvonne McKeown
COMPANY LISTINGS
l
M
Irish PharmaChem | Industry Buyers Guide 2023 115
Micro- b io i rel A nd ltd
Address: Industrial Estate, Fermoy, Co. Cork
tel: (025) 31388
fax: (025) 32458
email: info@micro-bio.ie

web: www.micro-bio.ie
business: Chemical Manufacturer.
contact: Sales Director: Tom Tobin
n Ation A l c H e M ic A l co MPA ny
Address: NCC House, 42 Lower Leeson St., Dublin 2, D02 FX39.
tel: (01) 613 1400
fax: (01) 634 0132
email: sales@ncc.ie

web: www.ncc.ie
business: Supply Chain PartnerLife Sciences Industry.


contact: Product Manager: Christy Smith
M sd i rel A nd
Address: Red Oak North, South County Business Park, Leopardstown, Dublin 18.
tel: +353 (0)1 299 8700
email: info@msd.ie
web: www.msd.ie
business: MSD Ireland is one of the country’s leading healthcare companies, having first established here over 50 years ago. We have a dynamic and diverse team of over 2,800 employees currently across six sites in Ballydine, Co Tipperary, Brinny, Co Cork, Dunboyne, Co Meath, Carlow and Dublin, and, in addition, operate substantial Human Health and Animal Health businesses. At MSD Ireland, we work at the forefront of science and technology to advance manufacturing excellence and R&D across our Irish sites and global company network. With a long-standing footprint in Ireland, our Irish sites manufacture approximately half of MSD’s top twenty products, helping save and enhance lives in over sixty countries around the world.
contact: Mairead McCaul
MSD Ireland (Human Health) LTD
n eli PA k He A lt H c A re PAck AG in G
Address: Galway: Unit 6D, Mervue Business Park, Mer vue, Galway, H91 C9D0, Ireland.
tel: (091) 757 152
Address: offaly: Kilbeggan Road, Clara, Co. Offaly, R35 F583, Ireland.
tel: (057) 933 1888
Address: derr y: 1 Acorn Road, Campsie Industrial Estate, Derry, BT47 3GQ, Northern Ireland.
tel: 0044 28 7181 4000
email: info@nelipak.com
web: www.nelipak.com
business: Innovative packaging solutions and complementary products and services for the healthcare market ser ving the medical and pharmaceutical sectors.
contact: Director of Global Marketing: Sean Egan
n PP G r o UP ltd
Address: Unit 2, Vantage Business Park, Coldwinters, Dublin 11.
tel: (01) 880 9299
email: sales@npp.ie bmcmahon@npp.ie
web: www.npp.ie
business: Flexible packaging suppliers & distributors.
ocon c H e M ic A ls ltd
Address: Unit 3, M.F.T. Business Park, Doughcloyne Ind. Estate, Sarsfield Road, Co. Cork.
tel: (021) 431 8555
fax: (021) 431 8560
email: info@oconchemicals.com
web: www.oconchemicals.ie
o’flynn M edic A l ltd




Address: Macroom Environmental Park, Bowl Road, Macroom Co. Cork, P12 YD92.
tel: (029) 21 799
email: info@oflynnmedical.com
web: www.oflynnmedical.com
business: Distributor of OSL
“Automated Protective Clothing Distributor”.
contact: Conor O’Flynn
o rtec i nc.
Address: Newcastle West Business Park, Station Road, Newcastle West, Limerick, V42 E765.
tel: +353 87 7752914
email: jgeraghty@ortecinc.com
web: www.ortecinc.com
business: Contract Manufacturing.
contact: Business Development Manager: John Geraghty
Address: Fox & Geese House, Naas Road, Dublin 22.
(01) 450 8759
email: sales@thepackagingcentre.ie
Address: 2 Birch House, Rosemount Business Park, Ballycoolin Road, Finglas, Dublin D11 T327.
tel: (01) 820 5395
fax: (01) 822 8813
email: info@particular.ie
web: www.particular.ie
business: Supply and Ser vice Laboratory Equipment.
contact: Managing Director: Sean Quilty

COMPANY LISTINGS
n
o
P TPC The Packaging Centre Ltd For all your packaging needs Fox & Geese House, Naas Road, Dublin 22. Tel: 01 450 8759 ~ Fax: 01 450 7567 www.thepackagingcentre.ie TPC The Packaging Centre
For all your packaging needs Fox & Geese House, Naas Road, Dublin 22. Tel: 01 450 8759 ~ Fax: 01 450 7567 www.thepackagingcentre.ie Pantone 2935 CMYK Cyan: 100
Ltd
Magenta:
tH e PAck AG in G c entre ltd
tel:
web:
www.thepackagingcentre.ie contact: Managing Director: Ivan Powell
PA rtic U l A r sciences ltd
Irish PharmaChem | Industry Buyers Guide 2023 116
P bc b ioMed
Address: 4D, Western Business Park, Shannon, Co. Clare, V14 RW92
tel: +353 86 1280618
email: bronagh@pbcbiomed.ie
business: Medical device consultancy
contact: Ms Bronagh O'Doherty
Pro s ys contA in M ent And sAMP lin G t ec H nolo G y
Address: IDA Business Park, Carrigtohill, Co. Cork, Ireland, T45AP82.
P H A r MAce U tic A l
M
A n U fAct U rin G
t ec H nolo G y c entre (PMtc )
Address: Bernal Institute, University of Limerick, Co. Limerick, V94 T9PX.
tel: 086 8530310
email: pmtc@ul.ie
web: pmtc.ie

business: Research and development.
contact: Centre Director: Sarah Hayes
P HA r MA lex
Address: Suite 2, Stafford House, Strand Road, Portmarnock, Co. Dublin, D13 H525.
tel: +353 1 846 4742
web: www.pharmalex.com/ireland
business: An award winning EU and US Quality, Technical & Compliance consultanc y to the life science industr y.


contact:
Commercial Manager: Anne Marie Purcell
PortA k A bin i rel A nd
Address: Roseville Business Park, Turvey Avenue, Donabate, Co. Dublin.
tel: (01) 200 3145
email: karen.brennan@portabin.com
web: www.portakabin.ie
business: Portakabin is the pioneer of modular construction in Europe, delivering interim and permanent bespoke buildings, of any size and to fulfil almost any application, site and design. Por takabin has provided award-winning off-site built environments of outstanding quality, with unrivalled on time and on budget performance, for over 50 years.
PP d, i nc.
Address: Building C, Athlone Business & Technology Park, Garrycastle, Athlone, Co. Westmeath.
tel: (0906) 460 300
fax: (0906) 460 301
web: www.ppd.com
business: Contract Research Organisation.
tel: +353 21 4853900
fax: +353 21 4853866
email: info@prosysgroup.com

web: www.prosysgroup.com
contact: Head of Global Sales: Michael Hennessy
Q
Q1 s cientific
Address: 87 Westside Business Park, Co. Waterford.
tel: (051) 355977
email: info.cqw@cambrex.com
web: www.q1scientific.com
business: Stability Storage (ICH/GMP).
contact: Louise Grubb, CEO
r e A din G s cientific s er vices l i M ited
Address: The Reading Science Centre, Whiteknights Campus, Pepper Lane, Reading, Berkshire, RG6 6LA, UK.

tel: +44 (0) 118 918 4076
email: enquiries@rssl.com
web: www.rssl.com
business: Analytical Testing Laboratory.
contact: Commercial Lead Biopharma & Personalised Medicine: Gaynor Johnston
s s cience fo U ndAtion
irel A nd ( sfi )
Address: 3 Park Place, Hatch Street Upper, Dublin 2.
tel: (01) 607 3200
email: info@sfi.ie
web: www.sfi.ie
business: Government funding agency for research.
contact: Director - Strategy and Communications: Dr. Ruth Freeman
Quitmann O’n eill Packaging ltd

Address: St. Brendan’s Road, Por tumna, Co. Galway, H53 HX51.
tel: (090) 9741148
fax: (090) 9741459
email: sales@quitmannoneill.com
web: www.qonpack.com
business: Packaging Disributor and Stockist.
contact: David O’Neill
s cientific i nstr UM ents i rel A nd
Address: Oular t House, Cullagheerva, Clonsilla, Dublin 15.
tel: 086 833 1056 (Jenny)
email: info@siireland.ie
web: www.siireland.ie
business: Distribution and Service
Support of Sample Preparation and Analytical Equipment.
contact: Jenny Egan

COMPANY LISTINGS
Irish PharmaChem | Industry Buyers Guide 2023 117 r
sk PHA r Mteco
Address: Watery Lane, Swords, Co. Dublin.
tel: (01) 813 9000
email: skpharmteco@sk.com
web: www.skpharmteco.com
business: Contract Development Manufacturing Organisation.
contact: Brian Fairley, Director Business Development & Marketing
s kyc ell AG
Address: Gotthardstrasse 28, 6300 Zug, Switzerland.
tel: 00 4144 533 2300
email: info@skycell.ch
web: skycell.ch


business: Pharmaceutical Logistics & Supply Chain Solutions.


contact: Sales Department: sales@skycell.ch
s MU rfit k APPA irel A nd
Address: Ballymount Road, Walk instown, Dublin 12.
tel: (01) 409 0000
fax: (01) 456 4506
email: info@smur fitkappa.ie
web: www.smurfitkappa.ie
business: Packaging.
solv - ec H e M irel A nd ltd
Address: Great Island Industrial Park, Ballincollig, Co. Cork.
tel: (021) 487 7066
email: info@solvechem.com
web: www.solvechem.com
business: Chemical distribution, chemicals, solvents, water treatment, warehousing.
ssPc, sfi reseArcH centre for PHArMAceUticAls
Address: Bernal Institute, University of Limerick, Limerick, Ireland.
web: www.sspc.ie
business: Pharma Research Centre.
contact: Chief Operating Officer, Dr. Sarah Hayes
s U stA in A ble ener G y
AU t H orit y of irel A nd
Address: 3 Park Place, Hatch Street Upper, Dublin 2.
tel: (01) 808 2100
email: info@sei.ie
web: www.sei.ie
business: Energy advice & information.
tek PA k AU to M Ation ltd.
Address: Whitemill Industrial Estate, Wexford, Y35 A620, Ireland.
tel: +353 (0)53 9163033
email: info@tekpak.ie

web: www.tekpakautomation.com
business: End-of-Line Automated Packaging Line Design, Manufacture, and Integration for High-Speed Retail Packaged Products and Pharmaceuticals. Tekpak Automation is Focused on the Life Sciences Industry range of pharmaceutical, biomedical, medical device, biotechnology, and cosmeceutical products. With Clients across Ireland, the UK, Europe, North America, Asia and the Middle East, Tekpak Automation can produce customised packaging machinery for product manufactures at any size or scale. Automated Applications include Robotic Pick and Place Systems, Vertical and Horizontal Cartoning, Brite Stock Loading/Unloading from Trays, Stacking, Nesting and Collating, Feeding Product to a Flow Wrapper Infeed, Labelling (TE, Print and Apply, or Thermal Transfer), Batch Data
tA nde M Pro J ec t
M A n AG e M ent ltd.
Address: 11 Nessan House, Mahon Industrial Estate, Blackrock, Cork, T12 XN4V.
tel: (021) 2038130
email: info@tandempm.ie
web: www.tandempm.ie
business: Tandem is an expert project management and engineering design consultancy successfully delivering to life science clients in Ireland, the UK and Europe. Tandem’s results orientated services include project management, project controls, multi-disciplined engineering design, construction management, energy & carbon reduction and CQV.
Tandem also provide client representative teams, operational readiness consultancy and talent solutions


s o U rce b io s cience
Address: Riverstown 5 Complex, Tramore, Republic of Ireland.
tel: +353 (0) 51 338435
email: salesireland@sourcebioscience.com
web: www.sourcebioscience.com

contact: Customer Relations Manager: Linda Nugent 0876897995 linda.nugent@tandempm.ie
Printing with Camera Verification, Carton and Case Erectors/Closers, Case Packing and Palletising, Machine Linking Conveyors with Signal Exchange, Integration of Serialisation and Aggregation Systems, 21 CFR Part 11 Ready Machines, GAMP 5 Project Management, GMP Design Features and Full Validation Documentation. Tekpak also offers a complete range of after-sales support and service packages to reduce machine downtime and disruptions to maximise the return on investment. Contact us today to assist with your next end-of-line automated packaging project.
contact: Managing Director: John Kehoe
t H er M o fis H er scientific cork ltd
Address: Currabinny, Carrigaline, Co Cork, P43 AY66.
tel: (021) 437 8800
email: contactcork@thermofisher.com
web: thermofisher.com/patheon
business: Active Pharmaceutical Ingredient Contract Development and Manufacuring.

COMPANY LISTINGS
t
Irish PharmaChem | Industry Buyers Guide 2023 118
toyotA M Ateri A l H A ndlin G i rel A nd ltd
Address: Killeen Road, Dublin 12.
tel: (01) 419 0200
web: www.toyota-forklifts.ie

business: Forklift and Warehouse Supplies.
contact: Noel Foley
UP s H e A lt H c A re
Address: Unit 3, Mygan Park, Jamestown Road, Finglas, Dublin 11.
tel: +44 7979 704423
email: ukiehealthcare@ups.com
web: www.ups.com/ie/en/healthcare/Home.page

business: Transport & Logsitics.
t wi
Address: West Building, Carrigaline Industrial Park, Carrigaline, Co. Cork, Ireland, P43 HK76.
tel: +353 (0)21 242 8800
email: info@technicallywriteit.com
web: www.technicallywriteit.com
business: TWi is a team of content creators and content strategists supporting leading technology and life sciences companies to create ideal end-user experiences.

contact: Emmet Kearney, Business Development Manager
contact: Paul Scott, Healthcare Marketing Manager. w
w estbo U rne it Glob A l services

Address: The Rubicon Centre, MTU, Bishopstown, Co. Cork.
tel: (021) 431 4310
email: john@westbourneit.com
business: General IT and Laboratory IT Service Provider to the pharmaceutical industry in Ireland.


UnivA r solU tions
Address: 536 Grants Crescent, Greenogue Business Park, Rathcoole, Co. Dublin.
tel: (01) 401 9800
email: irelandsalesoffice@univarsolutions.com
business: Chemical Distribution

contact: Key Account Manager: Carla Byrne
contact: John O'Sullivan, CEO w
rentec H ltd
Address: Unit 3, Innovation Park, Carrigaline Ind. Estate, Kilnagleary, Co. Cork.
tel: (021) 483 2644
fax: (021) 483 1363
email: mwren@wrentech.ie
web: www.wrentech.ie
COMPANY LISTINGS 119 Irish PharmaChem | Industry Buyers Guide 2023
U
ACADEMY OF CLINICAL
SCIENCE AND LABORATORY
MEDICINE
Tel: (01) 905 9730
E-mail: mail@acslm.ie
Web: www.acslm.ie
AN BORD PLEANALA
Tel: (01) 858 8100
E-mail: bord@pleanala.ie
Web: www.pleanala.ie
BIOPHARMACHEM
IRELAND
Tel: (01) 605 1500
E-mail: info@ibec.ie
Web: www.biopharmachemireland.ie
CHAMBERS IRELAND
Tel: (01) 400 4300
E-mail: info@chambers.ie
Web: www.chambers.ie
COMPANIES
REGISTRATION OFFICE
Tel: (01) 804 5200
LoCall: 0818 452 000
E-mail: cro.info@enterprise.gov.ie
Web: www.cro.ie
D EPARTMENT OF THE E N v IRONMENT, C LIMATE A CTION AND C OMM u NICATIONS
Tel: (01) 678 2444
E-mail: customer.service@decc.gov.ie
Web: gov.ie/decc
D EPARTMENT OF E NTERPRISE, T RADE AND E MPLOYMENT
Tel: (01) 631 2121
LoCall: 0818 302 121
E-mail: info@enterprise.gov.ie
Web: enterprise.gov.ie
D EPARTMENT OF H O u SING, L OCAL G O v ERNMENT AND H ERITAGE
Tel: (01) 888 2000
E-mail: qcsofficer@housing.gov.ie
Web: www.housing.gov.ie
ELECTRICITY SuPPLY
BOARD
Tel: (01) 676 5831
E-mail: esbnetworks@esb.ie
Web: www.esb.ie
ENTERPRISE
IRELAND
Tel: (01) 727 2000
Web: www.enterprise-ireland.com
ENvIRONMENTAL HEALTH
ASSOCIATION OF IRELAND
Tel: (01) 276 1211
E-mail: info@ehai.ie
Web: www.ehai.ie
ENvIRONMENTAL PROTECTION AGENCY
Tel: (01) 268 0100
E-mail: info@epa.ie
Web: www.epa.ie
HEALTH AND SAFETY
AuTHORITY
Tel: (01) 614 7000
LoCall: 0818 289 389
E-mail: wcu@hsa.ie
Web: www.hsa.ie
HEALTH PRODuCTS
REGuLATORY AuTHORITY
Tel: (01) 676 4971
E-mail: info@hpra.ie
Web: www.hpra.ie
HEALTH RESEARCH
BOARD
Tel: (01) 234 5000
E-mail: hrb@hrb.ie
Web: www.hrb.ie
HIGHER EDuCATION
AuTHORITY
Tel: (01) 231 7100
E-mail: info@hea.ie
Web: www.hea.ie
IDA - INDuSTRIAL DEvELOPMENT AGENCY
Tel: (01) 603 4000
E-mail: idaireland@ida.ie
Web: www.idaireland.com
INSTITuTE OF CHEMISTRY OF IRELAND
E-mail:
secretary@instituteofchemistry.org
Web: chemistryireland.org
I NTELLECT u AL P ROPERTY O FFICE OF I RELAND
Tel: (056) 772 0111
E-mail: ipinfo@ipoi.gov.ie
Web: https://www.ipoi.gov.ie/en/
INTERNATIONAL SOCIETY FOR PHARMACEuTICAL ENGINERING (ISPE)
Tel: +1 (813) 960 2105
E-mail: ask@ispe.org
Web: www.ispe.org
INvEST NORTHERN IRELAND
Tel: 0044 (28) 9069 8000
Web: www.investni.com
IRISH BuSINESS & EMPLOYERS CONFEDERATION (IBEC)
Tel: (01) 605 1500
E-mail: info@ibec.ie
Web: www.ibec.ie
IRISH CLEANROOM SOCIETY
Tel: (087) 958 8045
Web: www.cleanrooms-ireland.ie
IRISH COSMETICS, DETERGENT & ALLIED PRODuCTS ASSOCIATION
Tel: (01) 605 1500
E-mail: kevin.maher@ibec.ie
Web: www.icda.ie
IRISH EXPORTERS ASSOCIATION
Tel: (01) 661 2182
E-mail: contact@irishexporters.ie
Web: www.irishexporters.ie
IRISH MEDTECH ASSOCIATION
Tel: (01) 605 1500
E-mail: info@irishmedtechassoc.ie Web: www.irishmedtechassoc.ie
IRISH NATIONAL ACCREDITATION BOARD
Tel: (01) 614 7182
E-mail: info@inab.ie Web: www.inab.ie
IRISH PHARMACY uNION
Tel: (01) 493 6401
E-mail: info@ipu.ie
Web: www.ipu.ie
IRISH vENTuRE CAPITAL ASSOCIATION
Tel: (01) 276 4647
Web: www.ivca.ie
MANDATE TRADE uNION
Tel: (01) 874 6321
E-mail: mandate@mandate.ie
Web: www.mandate.ie
NATIONAL INSTITuTE FOR TRANSPORT & LOGISTICS (NITL)
Tel: (01) 402 3898
E-mail: pamela.obrien@dit.ie
Web: www.nitl.ie
PARENTERAL DRuG ASSOCIATION (PDA)
Tel: +1 (301) 656 5900
E-mail: info@pda.org
Web: www.pda.org
PHARMACEuTICAL SOCIETY OF IRELAND
Tel: (01) 218 4000
E-mail: info@psi.ie
Web: www.thepsi.ie
REPAK
Tel: (01) 467 0190
E-mail: info@repak.ie
Web: www.repak.ie
SCIENCE FOuNDATION
IRELAND
Tel: (01) 607 3200
E-mail: info@sfi.ie
Web: www.sfi.ie
uCD SCHOOL OF CHEMICAL & BIOPROCESS ENGINEERING
Tel: (01) 716 1825
E-mail: SCBE.enquiries@ucd.ie
Web: www.ucd.ie/chembioeng
Irish PharmaChem | Industry Buyers Guide 2023 120 USEFUL REFERENCES
= Public Holiday 2024 January 2024 Week 12 345 M 1 8152229 T 29162330 W 310172431 T 4111825 F 5121926 S 6132027 S 7142128 March 2024 Week910111213 M 411 18 25 T 5121926 W 6132027 T 7142128 F 18152229 S 29162330 S 310 17 2431 September 2024 Week353637383940 M 29162330 T 3101724 W 4111825 T 5121926 F 6132027 S 7142128 S 18152229 February 2024 Week56789 M 5 121926 T 6132027 W 7142128 T 18152229 F 291623 S 3101724 S 4111825 October 2024 Week4041424344 M 71421 28 T 18152229 W 29162330 T 310172431 F 4111825 S 5121926 S 6132027 July 2024 Week2728293031 M 18152229 T 29162330 W 310172431 T 4111825 F 5121926 S 6132027 S 7142128 November 2024 Week4445464748 M 4111825 T 5121926 W 6132027 T 7142128 F 18152229 S 29162330 S 3101724 April 2024 Week1415161718 M 1 8152229 T 29162330 W 3101724 T 4111825 F 5121926 S 6132027 S 7142128 August 2024 Week3132333435 M 5 121926 T 6132027 W 7142128 T 18152229 F 29162330 S 310172431 S 4111825 December 2024 Week484950515253 M 29162330 T 310172431 W 41118 25 T 51219 26 F 6132027 S 7142128 S 18152229 May 2024 Week1819202122 M 6 132027 T 7142128 W 18152229 T 29162330 F 310172431 S 4111825 S 5121926 June 2024 Week2223242526 M 3 101724 T 4111825 W 5121926 T 6132027 F 7142128 S 18152229 S 29162330 2022 January 2022 Week5212345 M 3 10172431 T 4111825 W 5121926 T 6132027 F 7142128 S 1 8152229 S 29162330 March 2022 Week910111213 M 7142128 T 18152229 W 29162330 T 310 17 2431 F 411 18 25 S 5121926 S 6132027 September 2022 Week3536373839 M 5121926 T 6132027 W 7142128 T 18152229 F 29162330 S 3101724 S 4111825 February 2022 Week56789 M 7142128 T 181522 W 291623 T 3101724 F 4111825 S 5121926 S 6132027 October 2022 Week394041424344 M 3101724 31 T 4111825 W 5121926 T 6132027 F 7142128 S 18152229 S 29162330 July 2022 Week2627282930 M 4111825 T 5121926 W 6132027 T 7142128 F 18152229 S 29162330 S 310172431 November 2022 Week4445464748 M 7142128 T 18152229 W 29162330 T 3101724 F 4111825 S 5121926 S 6132027 April 2022 Week1314151617 M 411 18 25 T 5121926 W 6132027 T 7142128 F 18152229 S 29162330 S 3101724 August 2022 Week3132333435 M 1 8152229 T 29162330 W 310172431 T 4111825 F 5121926 S 6132027 S 7142128 December 2022 Week4849505152 M 51219 26 T 61320 27 W 7142128 T 18152229 F 29162330 S 310172431 S 41118 25 May 2022 Week171819202122 M 2 9162330 T 310172431 W 4111825 T 5121926 F 6132027 S 7142128 S 18152229 June 2022 Week2223242526 M 6 132027 T 7142128 W 18152229 T 29162330 F 3101724 S 4111825 S 5121926 2023 January 2023 Week5212345 M 2 9162330 T 310172431 W 4111825 T 5121926 F 6132027 S 7142128 S 1 8152229 March 2023 Week910111213 M 6132027 T 7142128 W 18152229 T 29162330 F 310 17 2431 S 4111825 S 5121926 September 2023 Week3536373839 M 4111825 T 5121926 W 6132027 T 7142128 F 18152229 S 29162330 S 3101724 February 2023 Week56789 M 6 132027 T 7142128 W 181522 T 291623 F 3101724 S 4111825 S 5121926 October 2023 Week394041424344 M 291623 30 T 310172431 W 4111825 T 5121926 F 6132027 S 7142128 S 18152229 July 2023 Week262728293031 M 310172431 T 4111825 W 5121926 T 6132027 F 7142128 S 18152229 S 29162330 November 2023 Week4445464748 M 6132027 T 7142128 W 18152229 T 29162330 F 3101724 S 4111825 S 5121926 April 2023 Week1314151617 M 3 10 1724 T 4111825 W 5121926 T 6132027 F 7142128 S 18152229 S 29162330 August 2023 Week3132333435 M 7 142128 T 18152229 W 29162330 T 310172431 F 4111825 S 5121926 S 6132027 December 2023 Week4849505152 M 41118 25 T 51219 26 W 6132027 T 7142128 F 18152229 S 29162330 S 310172431 May 2023 Week1819202122 M 1 8152229 T 29162330 W 310172431 T 4111825 F 5121926 S 6132027 S 7142128 June 2023 Week2223242526 M 5 121926 T 6132027 W 7142128 T 18152229 F 29162330 S 3101724 S 4111825 2022 2023 2024
No matter where along a product’s lifecycle you operate—from product discovery to patent expiry— choose a partner you can rely on to consistently apply the highest GxP compliant quality standards.

For all your shipping needs:
Personalised medicines
Medical devices
Pharmaceuticals
Vaccines
Animal health products
Consumer healthcare products
■
■
■
■
■
■
Contact our Healthcare Logistics experts to learn more: ireland.sales@kuehne-nagel.com healthcarelogistics.kuehne-nagel.com
when it matters the most ■ Personalised medicines
Medical devices
Pharmaceuticals
Vaccines
Animal health products
Consumer healthcare products
Healthcare Logistics For
■
■
■
■
■

Leo Varadkar, An Taoiseach
Leo Varadkar, An Taoiseach





























































































































































































































































































































































